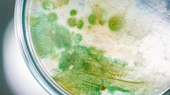
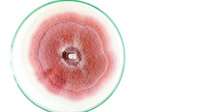

Startseite - Mosaik

NUTZEN
BIOMASSE NUTZENBioökonomie für alle
Was können Verbraucher*innen zu einer nachhaltigen Wirtschaft beitragen? Wie können nicht nur Autos, sondern auch Straßen nachhaltiger werden? Vor welchen ethischen Herausforderungen steht die Bioökonomie? Und wer steht in der Verantwortung?
Urban Gardening
Urban Gardening:Wie an der Uni Würzburg gegärtnert wirdvon Corinna Birner, Lisa Kühnemann und Andreas Krenzer
Beim Urban Gardening geht es darum, brachliegende Flächen in der Stadt nach ökologischen Aspekten gemeinsam zu bewirtschaften. Die grünen Oasen, die dadurch entstehen, bieten nicht nur eine Nutzfläche für den Anbau von Obst und Gemüse, sie fördern auch die Biodiversität.
Natürlicher Kreislauf mit Konzept
Der Naturschutzaktivist und Geograf Markus Gastl aus Herrieden in Mittelfranken hat ein "3-Zonen-Modell" entwickelt, mit dem sich Permakultur auf Hausgärten übertragen lässt: In der Ertragszone werden Nahrungsmittel angebaut, die sogenannte Hot-Spot-Zone mit Sandflächen, Steinhaufen und Teichen fördert die Artenvielfalt. Und die Pufferzone mit Hecken und Bäumen schützt den Garten vor Außeneinflüssen.
Natürlicher Kreislauf
NachhaltigkeitspreisDer Garten wächst
Mittlerweile ist in Würzburg ein vielfältiges Angebot für Urban Gardening entstanden: So realisierte das Referat Ökologie zusammen mit dem Würzburger Urban-Gardening-Verein Stadtgärtner zur Landesgartenschau 2018 die 2.000 Quadratmeter große ‘Stadtgartenschau‘ im Herzen des Landesgartenschaugeländes. Direkt an den CampusGarten schließt außerdem der UniAcker an, der im Rahmen von Lehramts- und Pädagogikseminaren genutzt wird.
80 Beete werden im CampusGarten jedes Jahr an Interessierte vergeben. Aktuell beteiligen sich über 100 Studierende an der Aussaat, Pflege und Ernte des Gartens. Wir haben einige von ihnen gefragt, was das Gärtnern für sie ausmacht:
Durch den Mix aus Steinen, Kies, Sand, lockerer Erde sowie Ästen und Wurzelstücken entstehen unterschiedlich warme Sonnenplätze für die Lebewesen.
Neben Wildbienen gibt es im CampusGarten auch Honigbienen. Der gewonnene Honig kann von allen genutzt werden. Die Betreuung der Honigbienen bedeutet für C. Verantwortung zu tragen und einen Ausgleich zum Alltag zu finden: "Bienen sind spannende Lebewesen, auch wenn sie manchmal zu gerne mit mir fangen spielen."
"Ich bin noch recht neu im Garten, habe aber durch die Ansprechpartner vom RefÖko beste Betreuung erhalten. In meinem Beet befindet sich ein Johannisbeerstrauch, der wohl erst nächstes Jahr richtig Früchte tragen wird. Die Tomaten, Bohnen und Auberginen wachsen hier besser als auf meinem Balkon, weil der Platz einfach größer ist. Ich habe mich über jeden Zentimeter Wachstum und über jede geerntete Frucht gefreut."
Steinstrukturen in sonniger Lage bieten einen optimalen
Lebensraum für Eidechsen. Außerdem können Insekten und Schnecken in der
sogenannten Echsenburg Unterschlupf finden. Auch Erd- und Wechselkröten finden
in kleinen Nischen Platz.
Durch den Mix aus Steinen, Kies, Sand, lockerer Erde sowie Ästen und
Wurzelstücken entstehen unterschiedlich warme Sonnenplätze für die
Lebewesen.
"Ein Beet im CampusGarten zu bewirtschaften ist eine super Möglichkeit, ungezwungen erste Erfahrungen beim Gärtnern zu sammeln. Bisher hatte ich zweimal zwar wenig ertragreiche Ernten, aber große Fortschritte beim Umgang mit Werkzeugen und Pflanzen. Ich baue beispielsweise Chilis, Tomaten und Kartoffeln an. Die Physalis sind diesen Sommer leider nichts geworden."
"Ich habe ein Beet im CampusGarten, weil es für mich einen guten Ausgleich darstellt. Es motiviert, sich an der frischen Luft zu betätigen. Gleichzeitig hat man die Möglichkeit, einen kleinen Teil seines Essens ganz direkt selbst anzubauen und wachsen zu sehen. Mal habe ich es ausprobiert, Kohl wachsen zu lassen oder eine Mischkultur mit Kartoffeln und Ringelblumen. Knoblauch geht immer gut. Außerdem habe ich verschiedene Kräuter wie Schnittlauch und Basilikum und Blumen für die Bienen, zum Beispiel Malve, Löwenmäulchen oder Sauerklee."
"Ich habe durch das Gärtnern viel über die natürlichen Kreisläufe unserer Umwelt gelernt. Als passionierte Hobbyköchin freut es mich außerdem, fast das ganze Jahr von Gartenerträgen zu profitieren. Angepflanzt habe ich bisher verschiedene Kräuter, Erdbeeren, Palmkohl, Süßkartoffeln, Zwiebeln, Zucchinis, Spinat, Jostabeeren, Radieschen, Salate, Lauch, Kornblumen und vieles mehr... Ich achte darauf, möglichst regionale und alte Sorten zu verwenden."
Der Garten bietet neben dem angrenzenden Haus mit Terrasse auch selbstgebaute Möbel aus Paletten. Auf diesen kann man eine kleine Brotzeit zu sich nehmen oder aber auch einfach die Atmosphäre auf sich wirken lassen.
Der untere Bereich des Gartens wurde durch ein unterirdisch verlegtes Rohr mit einem Wasserzapfhahn versehen, um das Gießen zu erleichtern.
Manche Gärtner*innen bewirtschaften ein Beet mit ihrer Familie. Die Kleinen zeigen auch großes Interesse an der Gartenarbeit und helfen mit, wo sie können. Sie dürfen sich aber auch einfach im Sandkasten austoben, während die Eltern in Ruhe das Beet pflegen.
Die Natur unterstützen
Neben Insektenhotels und Totholzansammlungen bieten Blühwiesen im CampusGarten vielen Tieren einen Lebensraum – vor allem bedrohten Wildbienenarten. Als Bestäuberinsekten tragen diese einen großen Teil zum Erhalt von Ökosystemen bei: Die Bienen ernähren sich vom Nektar der Pflanzen, die Pflanzen profitieren von der Verbreitung ihrer Pollen durch die Bienen. Im CampusGarten führt dieses Zusammenspiel wiederum zu gesteigerten Erträgen.
WissenstransferGartenfibel
Nicht nur um nachhaltiges Gärtnern, auch um Nachhaltigkeit im Sinne eines Wissenstransfers geht es also beim Projekt CampusGarten, wie Lukas Lackner erklärt. In Zukunft soll es verstärkt auch Workshops geben, die bei Interessierten die Begeisterung fürs Gärtnern wecken sollen:
Naturkosmetik
Naturkosmetik – gut für Mensch und Natur?von Diana Hisamudin, Fabian Roßhirt und Julian Roßhirt
Laut dem Marktforschungsinstitut IRI ist der Anteil von Naturkosmetik auf dem deutschen Markt seit 2012 um 50 Prozent gestiegen. Gleichzeitig ist der Anteil konventioneller Kosmetik geschrumpft. Eine wichtige Entwicklung, denn die Inhaltsstoffe herkömmlicher Kosmetika werden für die Umwelt immer mehr zur Gefahr.
MikroplastikEine unsichtbare Gefahr
Vom Ozean auf unsere Teller
Auch die Medien schildern immer häufiger die Folgen von Mikroplastik in den Ozeanen. Dabei sind besonders Meereslebewesen von der unsichtbaren Gefahr durch Mikroplastik bedroht. Wie die Umweltschutzorganisation WWF berichtet, verwechseln Fische die kleinen Plastikteilchen mit Nahrung und fressen diese. Am Ende landen die Schadstoffe deshalb auch auf unserem eigenen Teller.
NaturkosmetikSchützer der Natur
Dafür verzichten sie auf den Einsatz erdölbasierter Produkte sowie auf synthetische Farb- oder Duftstoffe. Stattdessen setzen sie natürliche Wirkstoffe wie zum Beispiel natürliche Öle, Zucker, Bienenwachse, Wurzeln sowie Pflanzen und Kräuter ein.
Für die pflanzlichen Rohstoffe gilt außerdem: Biolandbau ohne Pestizide und giftige Schadstoffe. Außerdem verzichten die Produzenten auf Monokulturen und fördern dadurch die Artenvielfalt.
Auch für Verbraucher die gesündere AlternativeWeg von Paraffinen und Co
Jutta Blankenhagen-Wagner ist Inhaberin eines Naturkosmetikstudios in Würzburg. Auch sie rät Verbrauchern dazu, auf Kosmetikprodukte mit natürlichen Wirkstoffen umzusteigen:
Natürliche InhaltsstoffeGenauso gut?
Janika Zahn, Mitarbeiterin beim Naturkosmetikhersteller Benecos meint dazu: „Natürlich gibt es viele Produkte, die noch nicht dem gleichen Standard entsprechen.“ Das gelte besonders für die Wirkungsdauer von Deos oder die Haltbarkeit von Nagellacken. Aber nicht alle Naturkosmetikartikel seien deswegen gleich schlechter, so Zahn. Es gebe auch Produkte, die besser performen als die konventionelle Alternative.
Die Legende vom hohen Preis
2010 waren die Preise für Naturkosmetik tatsächlich höher als für Konkurrenzprodukte, erklärt Zahn. Heute sehe es jedoch anders aus: Den Herstellern gelänge es, beim Preis mit dem konventionellen Markt mitzuhalten.
Auch das Verbrauchermagazin Ökotest zeigte bereits 2015, dass Naturkosmetikprodukte inzwischen in allen Preissegmenten zu finden sind. Außerdem hat sich der Zugang zur Naturkosmetik verbessert: Konsumenten können die Artikel heute sowohl in Fachgeschäften und Apotheken als auch in Drogeriemärkten kaufen.
Naturkosmetik erkennen
Eine 2018 durchgeführte Umfrage der Online-Plattform Utopia bestätigt, dass sich viele umweltbewusste Konsumenten deshalb auf spezielle Siegel verlassen: Über die Hälfte der rund 2.400 Befragten gaben an, beim Kauf von Naturkosmetik auf explizite Zertifizierungen zu achten. Nur jedem Fünften reicht die Bezeichnung „Naturkosmetik“ auf der Verpackung.
Allerdings sollten Käufer sich nicht täuschen lassen. Einige Firmen versuchen ihre Artikel zertifiziert wirken zu lassen und drucken dafür sogar eigene Labels ab. Deshalb ist es besonders wichtig, nur namenhaften Siegeln zu vertrauen.
Die bekanntesten davon sind das BDIH-, das COSMOS- und das NATRUE-Siegel. Obwohl jedes Siegel eigene Standards hat, sind bestimmte Inhaltsstoffe bei fast allen verboten. Dazu gehören laut der Verbraucherzentrale Silikone, Erdöle, Paraffine, Plastikteilchen und Farbstoffe.
Gute Aussichten
Und mit der wachsenden Nachfrage nach natürlicher Kosmetik steigt auch das Angebot auf dem Markt – das zeigen Zahlen des Marktforschungsinstituts RKI und lassen die Hersteller von Naturkosmetik in eine vielversprechende Zukunft blicken.
Ist das möglich?Fleischkonsum mit gutem Gewissenvon Lena Gerhard
Man hört es immer und immer wieder: „Rettet unseren Planeten!“ Klimaschutz-Demonstrationen wie Fridays for Future sind bereits Alltag. Das Bewusstsein ist also da. Auf den ersten Blick klingt das doch gar nicht so schlecht, aber dennoch fragen sich viele Menschen: Wie soll ich, als einer von sieben Milliarden Menschen, die Welt retten? Bin ich, als Einzelperson, überhaupt von Bedeutung? Kann ich überhaupt einen Beitrag leisten, um unsere Umwelt zu verbessern? Die Antwort auf die Fragen lautet ganz klar: JA!
Deutsche essen weniger Fleisch
Ernährung der Zukunft
Die Bioökonomie befasst sich unter anderem mit einer zukunftsorientierten Ernährung. Eine der großen Herausforderungen der Zukunft besteht darin, immer mehr Menschen zu ernähren und dabei gleichzeitig regenerative Ressourcen für eine dauerhafte Energieversorgung sowie Rohstoffe für vielfältige industrielle Prozesse bereitzustellen. Das erfordert Wertschöpfungsnetze, die eine nachhaltige Nutzung der regenerativen Ressourcen, insbesondere von Biomasse, ermöglichen. Auch die Massentierhaltung in der Fleischindustrie spielt hier eine Rolle: Rund 70 Prozent der landwirtschaftlichen Flächen in der EU werden derzeit für den Anbau von Tierfutter genutzt.
„Unser Anspruch ist es, so viel wie möglich zu tun, um die Produktion im Agrarsektor nachhaltiger zu gestalten, und um eine nachhaltige und bioökonomische Zukunft zu sichern“, erklärt Lewandowski. Aber allein die Forschung reiche nicht, um eine Innovation umsetzen zu können. Man brauche die Mithilfe der Konsumenten, die auch gewillt sind, neue Produkte anzunehmen. Sonst könne sich die beste Innovation am Markt nicht halten.
Bildnachweis: Universität Hohenheim / Angelika Emmerling
Nicht überzeugend genug
Basierend auf Daten aus dem Jahr 2018 landen umgerechnet allein 10,5 Millionen Tiere jährlich im Hausmüll. Erschreckende Zahlen, wenn man bedenkt, dass wir in einer Zeit leben, in der in industriellen Ländern theoretisch keine Lebewesen mehr für die menschliche Ernährung vorsätzlich leiden oder sterben müssten. Gesellschaftlich sind wir aber noch lange nicht so weit.
Tiere produziert man nicht!
Ethisches Dilemma
Keller beschreibt ein ethisches Dilemma. Ist eine fleischfreie Ernährung überhaupt so gut, wie man denkt? Schließlich hat auch der biologische Kreislauf der Natur seinen Sinn. Wenn kein Lebewesen mehr sterben würde, so würde das schließlich zu einer Überpopulation führen – Tier und Mensch hätten weder genügend Nahrungsmöglichkeiten noch ausreichend Raum zum Leben. Es ist also ohnehin unmöglich zu leben, ohne dabei anderen Lebewesen zu schaden. Geht es um einen ‘Schaden‘, so denken die meisten Menschen sofort an das Schlachten von Tieren. Somit werden allein die Fleischkonsumenten verantwortlich gemacht und von Fleisch-Gegnern sogar als Mörder dargestellt.
Vegane ErnährungUngesund und langweilig?
Trotzdem: Die Vorurteile gegenüber Veganismus und Vegetarismus bleiben. Kann ich jetzt nur noch Salat und Rohkost essen? So ist es natürlich nicht. „Man sollte den Menschen die Angst nehmen, ihnen das Positive zeigen und es ihnen so leicht wie möglich machen“, meint der Professor. So könnte man die Menschen beispielsweise mit Kochrezepten inspirieren, Alternativen vorstellen und so dem Vorurteil, eine vegane Ernährung sei eintönig und langweilig, entgegenwirken. Denn eine vegane und vegetarische Ernährung kann ganz gewiss vielseitig sein! Zu den beliebten Fleisch-Klassikern wie Burger, Grillwurst und Co gibt es bereits fleischfreie Alternativen. Insbesondere Hülsenfrüchte wie Linsen, Kichererbsen und Bohnen sind ein echter Hit. Hinzukommt: Hülsenfrüchte sind nicht nur vegan und enthalten nährstoffreiche Vitamine, sie sind auch noch preisgünstig. Das Argument, eine vegane oder vegetarische Ernährung sei kostspielig, wird hier also auch entkräftet.
Transparenz durch Labels
Doch nicht nur bei der Fleischproduktion, auch in vielen anderen Wirtschaftsbereichen fehlt es an Transparenz, wenn es um die Nachhaltigkeit geht. Das muss sich ändern.
„Bioökonomie muss verständlich gemacht werden“, erklärt Lewandowski. Auch sollte man schon viel früher über bioökonomische Aspekte aufklären und Kindern durch Bildung früh genug ein Bewusstsein aneignen.
Insekten als Ersatz?
Auch sogenanntes Laborfleisch wird immer besser erforscht. Hierbei wird Fleisch künstlich in einem Labor hergestellt, ohne dass dabei ein Tier sterben muss. Dieser Fleischersatz ist klimafreundlicher und zudem frei von Medikamenten und Zuchtmitteln. Interessant ist hierbei, dass laut dem Ernährungsreport sogar ein knappes Drittel der Bevölkerung grundsätzlich offen für alternative Fleischarten ist, um einen Beitrag zur Ernährungssicherheit zu leisten.
Produktion und Politik
„Da müsste man politisch gesehen viel mehr tun. Es müssen strikte Grenzen gesetzt werden, auch wenn das hart und unpopulär ist. Man muss eine derartige Produktion entweder radikal verbieten, oder die Regeln so aufstellen, dass der Landwirt auch mit einer nachhaltigen Produktion überleben kann“, erklärt die Agrarwissenschaftlerin der Uni Hohenheim. Gleichzeitig müsse es ihrer Einschätzung nach einen Preis für den Service ethisch besser hergestellter Lebensmittel geben, der höher ist, als das billig produzierte Fleisch.
Letztendlich muss jeder für sich entscheiden, welche Art von Ernährung für ihn optimal ist. Und auch, wie er mit einem bewussteren Handeln einen Beitrag für unsere Umwelt leisten kann. Es kommt nicht darauf an, streng vegetarisch oder vegan zu leben. Viel bedeutsamer ist es, mit kleinen Schritten und Veränderungen zu einem bewussteren Lebensstil beizutragen. Denn so ist es tatsächlich möglich, ohne Reue und guten Gewissens zu genießen.
Netzwelt voller Clouds Die grüne Zukunft der Digitalisierungvon Victoria Augst
Hinter der digitalen Bequemlichkeit der Clouds verbergen sich Unmengen an Zahlen, Codes, Servern und Rechenzentren. Cloud Computing bezeichnet onlinebasierte Speicherplätze und Rechenleistungen. Diese Technik ermöglicht uns, Daten auszulagern und bei Bedarf auf sie zurückzugreifen – via Smartphone, Tablet oder Computer. Das schont die eigene Festplatte, erspart Schränke voller Aktenordner.
Aber: Wo das Material wirklich landet, auf welchem Server es ist, bleibt für viele Nutzer im Nebel – oder eben, der Begriff Cloud beschreibt es: in den Wolken. Rechenzentren sind quasi der Wolkenmaschinenpark – Orte voller Computer, Speicher, Kühl- und Brandschutzgeräte. Dort treffen über Mobilfunkantennen unsere Internet-Anfragen ein, 24 Stunden, 365 Tage lang, unermüdlich werden sie hier verarbeitet.
Dreckiger Strom
Digitale Zukunft
Nachhaltige Digitalisierung – geht das? Für die Vereinten Nationen (UN) definitiv, denn sie haben bereits 2015 im Zuge der Agenda 2030 einen Katalog mit 17 Zielen für eine nachhaltige Entwicklung verabschiedet. Dieser betrachtet unter sozialen, ökonomischen und ökologischen Gesichtspunkten die fünf Kernbotschaften Mensch, Planet, Wohlstand, Frieden und Partnerschaft. Unter anderem sollen Maßnahmen zum Klimaschutz und zu bezahlbarer und sauberer Energie ergriffen werden. Auch Industrie, Innovation und Infrastruktur sind ein Teil des Nachhaltigkeitsplans der UN.
Wie nun aber diese auf politischer Ebene geschlossenen Vereinbarungen praktisch umgesetzt werden können, ist noch nicht ganz klar. Trotzdem gibt es deutschlandweit bereits einige Pilotprojekte, die sich mit einer nachhaltigeren Digitalisierung, insbesondere mit nachhaltigen Rechenzentren auseinandersetzen.
GreenITDas grüne Rechenzentrum
So spart zum einen das Unternehmen selbst, aber auch als Kunde zahlt man für die Kilowattstunde weniger als bei anderen Anbietern. Das ist auch gut so, meint Schriewer: „Wenn das ökologisch betriebene Rechenzentrum bzw. die dort betriebenen Services merklich teurer wären als beim klassischen Betreiber, dann wäre es in der heutigen Zeit schwierig, neue Kunden zu gewinnen.“ Denn es lässt sich auch erkennen, dass nachhaltige Lösungen nicht nur aus Überzeugung zum Umweltschutz gewählt werden. „Die Nutzung von grüner IT ist für Unternehmen ein wichtiges Positionierungsmerkmal. So zeigen sie ihren eigenen Kunden, dass sie nicht nur umweltbewusst denken, sondern auch handeln.“
Infrastruktur muss auf die AgendaPolitik ist gefordert
„Eine stabile und zuverlässige Infrastruktur ist auch ein Nachhaltigkeitsthema“, stimmt Hintemann zu, „und Rechenzentren müssen ein Teil davon sein.“ Laut ihm gehöre der Ausbau von Wärmenetzen zur Abwärmenutzung auch auf die politische Agenda. Denn der Anschluss von Rechenzentren an diese Netze ist in Deutschland sehr schwer. Während es hier viele Hochtemperatur-Wärmenetze mit Temperaturen von bis zu 100 Grad gibt, erreicht die Abwärme aus Rechenzentren lediglich Temperaturen von 30 bis 35 Grad.
Der Energieaufwand, um diese Abwärme zu erhitzen, sodass man sie in die vorhandenen Netze einspeisen kann, sei zu aufwendig und zu teuer, gibt Hintemann zu bedenken. „Es wäre billiger, Gas zu verbrennen, um die nötige Wärme zu erhalten, als mit einer Wärmepumpe zu arbeiten.“ Ein möglicher Lösungsansatz sei hierbei die Umstellung auf Flüssigkühlung. So könnten Wassertemperaturen von bis zu 60 Grad bereitgestellt werden, welche deutlich leichter für Heizzwecke zu nutzen seien, so Hintemann. Aber auch dafür seien die deutschen Netze noch nicht ausreichend ausgebaut.
Elektroschrott
Künstliche Intelligenz in der DatenverarbeitungFreund und Feind der Umwelt
„Mit der KI verhält es sich, wie mit der Digitalisierung insgesamt“, fasst Hintemann zusammen. „Wir müssen es schaffen, die KI so einzusetzen, dass sie zu mehr Nachhaltigkeit führt und nicht zu mehr Ressourcenbedarf.“ Eine Möglichkeit dafür ist spezielle, energieschonendere Hardware – besondere Grafikkarten zum Beispiel. Außerdem könnte man beim Betreiben von KIs auf spezielle flüssiggekühlte Server setzen. Solche setzen bereits großen Unternehmen wie Google ein. Insgesamt stellt die Künstliche Intelligenz einen großen Treiber für die Digitalisierung dar. Es gibt immer mehr Rechenzentren speziell für KIs. Abzuwägen ist, ob der enorm hohe Energiebedarf mit dem eventuell positivem Nutzen für Gesellschaft und Umwelt zu rechtfertigen ist.
Ein gewaltiger Riese
Wie kann der gewaltige Riese Internet von uns gefüttert werden und gleichzeitig fortschrittlich und nachhaltig sein? Kann man all das allein mit erneuerbaren Energiequellen generieren? „Es ist eine Herausforderung“, konstatiert Hintemann. Man hoffe auf einen starken Ausbau der Nutzung erneuerbarer Energien. „Alle sind sich einig, dass man die Digitalisierung nicht aufhalten kann“, meint Hintemann, „aber letztendlich muss die Digitalisierungspolitik eine Nachhaltigkeitspolitik sein.“
Tiny Houses, Ökodörfer & CoAlternative Wohnkonzeptevon Julie Vandré
Ida Johansson hat sich für ein Leben im Tiny House entschieden. Sie lebt in einer Bilderbuchwelt: Durchs Küchenfenster blickt sie auf Wiesen und Felder. Ihr Kater Theo streicht ihr um die Beine, während sie sich Kaffee aufsetzt. Die Sonne scheint ihr ins Gesicht. Ida lächelt. Inspiriert vom Minimalismus beschloss sie, auf ein Feld in Norwegen zu ziehen. Doch nicht nur in Norwegen wächst dieser Trend. In Deutschland gibt es die Häuser mit einem Grundriss von durchschnittlich 20 Quadratmetern seit 2016. Einer der ersten und größten deutschen Hersteller ist die Schreinerei Diekmann aus Hamm.
Leben im Ökodorf
"Sieben Linden"Gemeinschaftsgefühl inbegriffen
Er lebt seit 18 Jahren im Dorf. Dort habe man das „Ziel, den Energie- und Ressourcenverbrauch so weit zu reduzieren, wie es möglich ist, dass es trotzdem ein gutes Leben ist, aber nicht ein Überfluss“. Strünke will das Gesamte im Blick haben: „Alles was wir tun hat auch Einfluss auf die Menschen, mit denen wir nicht direkt zusammenwohnen. Ich versuche in dem, was ich tue, förderlich zu sein, zum Beispiel Lebensbedingungen zu fördern, die gut sind.“
Nachhaltige Baustoffe
Die Kosten für Strohballenhäuser liegen bei 1.300 bis 1.600 Euro pro gebauten Quadratmeter; ein Tiny House mit rund 20 Quadratmetern Fläche kostet durchschnittlich 60.000 Euro, also 3.000 Euro pro Quadratmeter Nutzfläche. Dazu kommen zusätzlich noch die Kosten für den Stellplatz des Hauses. Zwar werden die Häuser oft als günstige Alternative zu den steigenden Mietpreisen dargestellt, aber letztlich rechnet sich das erst, wenn man alle Faktoren einrechnet: gewünschte Wohnfläche, Standort, ökologische Bilanz.
Grundstück gesucht
„Es ist noch ein sehr junges Thema. In der Phase sind wir noch, den Nachweis zu erbringen, dass es ein dauerhaftes Thema ist und nicht irgendwie ein Hype oder Trend, der in drei Jahren wieder vorbei ist. Wenn das in der Politik ankommt, dann wird sich in Zukunft sicherlich auch was an der Baugesetzordnung tun“, meint Vera Lindenbauer, Sprecherin der Schreinerei Diekmann.
Wenig Platz, wenig Verbrauch
Durch die begrenzte Wohnfläche verringert sich gezwungenermaßen auch das Konsumverhalten: „Das ist wahrscheinlich auf lange Sicht der größte Beitrag zur Nachhaltigkeit“, so Lindenbauer. Allerdings ist auch hier die Gesamtsicht wichtig: Um mobil zu sein, darf ein Tiny House nach der Straßenverkehrsordnung maximal 3,5 Tonnen wiegen. Deswegen werden die Wände gerne dünn und ohne genügend Dämmstoffe gebaut, was wiederum zu höheren Heizkosten führt.
Minimalismus ist eine Einstellung
Vielfach werden die Tiny-Häuser in Deutschland gar nicht als Hauptwohnsitz genutzt. Ein Großteil der Kunden der Schreinerei Diekmann sind momentan aus dem gewerblichen Bereich, sie sehen das Tiny-House-Movement als Profit- und Präsentationsmöglichkeit. Unternehmen nutzen das Haus als Showroom auf Messen, Campingplatz-Betreiber bieten die Mini-Häuser zur Vermietung an. Die meisten Häuser werden als Feriendomizil genutzt.Unterm Strich wird damit das Kernziel der Nachhaltigkiet auf den Kopf gestellt: So werden eher zusätzliche Ressourcen verbraucht.
Nicht nur ein Trend
Solidarische Landwirtschaft
Monatsabo für ErnteanteilSolidarische Landwirtschaftvon Ronja Hemm
Einkaufen mit gutem Gefühl
Das Rundum-Sorglos-Paket
Preislich ergibt sich für den Verbraucher trotz des Festbetrags ein Vorteil. Weil er die Produkte direkt vom Erzeuger erhält, entfallen Aufschläge von Lieferanten und Einzelhandel. 2019 lag die Marge, die der Naturkostfachhandel mitverdient, laut ContRate-Betriebsvergleich bei durchschnittlich 34,6 Prozent. Mit Solawi zahlt der Verbraucher deswegen über das Jahr hinweg weniger, als wenn er die gleiche Menge Gemüse und Obst bei einer Biomarkt-Kette einkaufen würde. Sowohl der Preis als auch der Ernteplan werden auf einer Versammlung am Anfang eines Jahres festgelegt. Die Erzeuger schlagen vor, was und wieviel sie anbauen wollen und nehmen Vorschläge und Wünsche der Verbraucher mit auf.
Würzburger "SoLaWü-Päckle"Regionaler Ernteanteil
Dieses Jahr landet in jedem Päckle die wöchentliche Ernte von 136 Quadratmetern Gemüsefeld sowie Obst und Saft von anderthalb Streuobstbäumen. Das können in einer Novemberwoche beispielsweise jeweils ein Kilo Kartoffeln und Möhren, ein Pfund Rote Beete, 120 Gramm Feldsalat, 700 Gramm Schwarzkohl, ein Endiviensalat, eine Stange Rosenkohl und 800 Gramm Äpfel sein.
Rundum solidarisch
Quelle Bild: VEG
Wertschätzung für die Produkte
Sicherheit für den Landwirt
Zusätzlich sind die Erzeuger von schwankenden Marktpreisen abhängig. Laut des Deutschen Bauernverbands haben Landwirte 2019 ein Fünftel weniger Geld verdient als im Jahr zuvor. Solawi beschert dem Erzeuger hingegen ein festes Monatseinkommen, mit dem er sich und seinen Angestellten einen fairen Lohn zahlen kann – auch wenn die Ernte durch Trockenheit oder Frost mal schlechter ausfällt.
Solawi: Nische oder Zukunft?
Frankreich führt im europäischen Vergleich mit mehr als 2000 Gemeinschaften die Spitze an. In Japan, wo die Solawi-Idee in den 70er Jahren unter dem Namen „Teikei“ geboren wurde, versorgen sich mittlerweile elf Millionen Menschen nach dem Prinzip. Dennoch: Für Deutschland sieht Stefan Köhler vom BBV klare Grenzen:
Rapsasphalt
RapsasphaltWieso ein Franke Straßen mit Pflanzenöl bauen willvon Alexander Gruber
Das westliche Mittelfranken ist überwiegend ländlich geprägt. Kleine Landstraßen schlängeln sich durch das Taubertal, Äcker wechseln sich mit Wäldern ab. Die A7 und die B13 durchziehen den westlichen Landkreis Ansbach, die restlichen Straßen sind kleine Nebenstraßen. Viel Potenzial für mehr Klimaschutz, findet Klaus Geuder. In Neusitz bei Rothenburg hat seine Straßenbaufirma ihr Büro. Hier in der Umgebung hat Geuder schon mehrere Straßen gebaut und saniert. Viele davon auch mit sogenannten Raps- Bitumenemulsionen, von Geuder als „RapsAsphalt“ vermarktet.
Viel Potenzial für Nachhaltigkeit
Er zeigt eine kleine Gemeindeverbindungsstraße, die er mit seiner Firma im vergangenen Jahr mit Rapsasphalt saniert hat. Der Farbton ist etwas heller als das satte Schwarz, das man sonst von Asphalt kennt, ansonsten ist für den Laien kein Unterschied erkennbar. Die Oberflächenbehandlung, die Geuder hier durchführte, ist das bislang einzige Anwendungsgebiet für Asphalt mit Rapsöl-Anteil. „Bei einer Oberflächenbehandlung wird auf die beschädigte Straßendecke nochmal eine Asphaltschicht aufgebracht“, erklärt Geuder. „In diesem Fall aus RapsAsphalt.“
Bessere bauliche Eigenschaften durch Rapsöl
2004 gab Geuder bei der TU München eine Studie zu den baulichen Eigenschaften seines Raps- Asphalts in Auftrag. Das Ergebnis: Durch das Rapsöl wird der Asphalt schneller fest, kann also früher befahren werden und hält etwa 20 Prozent länger als herkömmliche Verfahren. Eine Oberflächenbehandlung halte normalerweise etwa acht Jahre, sagt Fink. Bei Raps-Bitumenemulsionen seien es zehn Jahre oder mehr. Die Chemikerin begleitete die Studie damals: „Das Rapsöl wirkt im Bitumen als Fluxmittel und verharzt durch den Einfluss von Sauerstoff und Licht.“ Dadurch verklebe das Bitumen besser mit dem Gestein, der Asphalt verfestige sich schneller, werde vier Mal so hart – "und ist alterungsbeständiger."
Kleiner Rapsöl-Anteil – große Wirkung
Raps-BitumenemulsionenNur auf kleineren Straßen einsetzbar
Kritik am Rapsöl im Asphalt
Ein Blick in die betreffende Studie zeigt ein differenziertes Bild: Biogene Öle wie Rapsöl hätten demnach positive Auswirkungen auf Klima und Ressourcenverbrauch. Dafür gebe es Nachteile durch Überdüngung und Versauerung der Böden. In Summe seien die Umweltauswirkungen vergleichbar mit herkömmlichen Verfahren, teilweise sogar höher. Die Schweizer Studie sieht in biogenen grundsätzlich zwar Potenzial, aber auch noch viel Forschungsbedarf.
1 m² Rapsasphalt benötigt 1 m² Rapsfeld
Klaus Geuder hofft, dass die aktuelle Klimadebatte sich auch im Straßenbau auswirkt:
Elektromobilität
Die Lithium-Ionen-Batterien im Kreuzfeuer der KritikElektromobilität: Alternativlose Alternative?von Amelie Mangler
Entwicklung der Elektroautos
Doch von der angestrebten Million Elektrofahrzeuge auf den deutschen Straßen bis 2020 sind nach aktuellen Zahlen des Kraftfahrt-Bundesamts bisher nur 137.000 erreicht. Was bedeutet das für die Zukunft der Elektromobilität? Und ist die Elektromobilität mit der umstrittenen Lithium-Ionen-Batterie wirklich die Zukunft?
Elektromobilität als Zukunftsmodell
In der „Modellstadt der Elektromobilität“ Bad Neustadt (Lkr. Rhön-Grabfeld) wird intensiv an Verbesserungs- und Weiterentwicklungsmöglichkeiten der Elektromobilität geforscht. Vor mittlerweile zehn Jahren initiierte das Team um Jörg Geier in der 15.000-Einwohner-Stadt die Forschung an Themen wie Ladetechnik, Batteriemanagement- oder Active-Balancing- Systemen. „Ob Tesla, Ford oder BMW: Alle haben in irgendeiner Form Technik aus Bad Neustadt in ihren Autos oder wurden durch Bad Neustädter Technik geprüft“, sagt Geier. In den vergangenen zehn Jahren seien in ortsansässigen Unternehmen 750 neue Arbeitsplätze im Bereich Elektromobilität entstanden.
Internationaler Vergleich
Ist schon die Trendwende zum E-Auto in Sicht?
Co2-Bilanz besser als bei Benzinern
Kritik an Lithium-Ionen-Batterie
Eine These, die Geier bestätigt: „Elektronik enthält in Masse und Gewicht mehr Kobalt als alle E-Autos auf der Welt zusammen.“ Dennoch prognostiziert das Kölner Institut für Wirtschaft, dass die Kobalt-Nachfrage bis 2025 auf rund 225.000 Tonnen jährlich steigen könnte.
Lithium im Kreuzfeuer
Doch die Ressource ist endlich. Recyceln sei in Deutschland noch zu kompliziert und nicht rentabel, so Fichtner. Im Unterschied zu Kobald lohnt es sich uch laut Karlsruher Institut für Technologie (KIT) derzeit weder ökonomisch noch ökologisch, Lithium aus den Batterien zu recyceln.
Blaupause bei Alternativen
Biologische Reinigungsmittel mit heimischen TensidenReinigen ganz ohne Chemievon Hanne Scheidler
Herkömmliche Putzmittel verunreinigen die Natur
verschiedensten Chemikalien wird das perfektioniert. Oft haben die Mittel aber negative Nebeneffekte und schädigen den putzenden Verbraucher. Eine Langzeitstudie von der Universität Bergen in Norwegen kam 2018 zu dem Ergebnis, dass Reinigungsmittel sogar ähnlich wie das Rauchen die Lungen schädigen können. Auch die Folgen für die Umwelt sind erheblich.
Laut Umweltbundesamt kommen in deutschen Haushalten jährlich rund 480.000 Tonnen chemische Reinigungs- und
Pflegemittel zusammen. Mit dem Reinigungswasser gelangen entsprechend viele Substanzen in die Umwelt, die nur teilweise oder gar nicht in Kläranlagen abgebaut werden – zum Schaden des gesamten Ökosystems.
Nachhaltigkeitssiegel sorgen für Gewissheit
"Allerdings gibt es umweltfreundliche Siegel für Reiniger, auf die man achten sollte" sagt Messerschmidt und nennt beispielsweise Blauer Engel, Euroblume oder Ecocert. Die Siegel stehen dafür, dass nicht nur die Verpackung, sondern vor allem der Inhalt biologisch ist. Sie lassen den Verbraucher erkennen, dass die jeweiligen Tenside aus nachwachsenden Rohstoffen wie Sonnenblumen, Raps oder Oliven gewonnen
werden und nicht mehr als fünf Prozent künstliche Konservierungsstoffe enthalten sind.
Tenside als zentrale Substanzen
Regional und 100 Prozent biologisch
Biofilon will Verbrauchern in privaten und industriellen Bereichen umweltverträgliche Reinigungsmittel bieten, die erschwinglich sind. Zwar könne vor allem in der Industrie im Moment noch nicht alles durch rein biologische Mittel ersetzt werden, So Knittel: "Aber sie können einen großen Teil der chemischen Reiniger ersetzen.“ Es gebe schon viele Möglichkeiten, etwas zu verändern – auch in der Industrie.
Nachhaltigkeit im Unternehmen
Bewusster Umgang mit Reinigungsmitteln
Messerschmidt vom Kompetenzzentrum Hauswirtschaft. Man könne auch Reinigungsmittel sparen, wenn man Tücher verwendet, die mehr Schmutz aufnehmen.
Der Wille ist da
Knittel ist optimistisch: „Da passiert viel momentan. Der Wille, wirklich etwas zu verändern, ist da.“
Nachhaltiger KonsumZwischen Umweltschutz und Kaufrauschvon Selina Pellner
Der Konsum privater Haushalte ist eine Belastungsrobe für die Umwelt. „Letztlich haben die Konsumenten 60 bis 70 Prozent der Umweltfolgen in der Hand“, sagt Armin Grunwald, Leiter des Büros für Technikfolgen-Abschätzung beim Deutschen Bundestag. Damit geht ein beachtliches Potenzial zur Verringerung der Umweltbelastung einher – eine große Verantwortung für die Verbraucher, die zwischen nachhaltigem Konsum und Kauflust stehen.
Nachhaltiger Konsum – ein Absurdum?
Für Susanne Waldmann, Gründerin und Geschäftsführerin des Unverpackt-Geschäfts in Würzburg, ist das Konzept des nachhaltigen Konsums jedoch ein Widerspruch in sich. „Konsum ist nie nachhaltig“, erklärt sie, weil selbst nachhaltiger Konsum einen Verbrauch von Ressourcen mit sich bringt. So sei mit nachhaltigem Konsum lediglich der bewusste Umgang mit Gütern und Dienstleistungen gemeint, die für das Leben notwendig sind.
Die Nachfrage nach grünen Produkten steigt
Allerdings werden diese Erfolge durch höheren Konsum der Verbraucher gemindert – man spricht vom sogenannten Rebound-Effekt, erklärt Grundwald:
Ein Luxusphänomen
Der Preis der Nachhaltigkeit
Umweltschutz mit kleinem Geldbeutel
Bei der Effizienz solcher Maßnahmen herrscht jedoch Uneinigkeit. „Es kann sein, dass die Summe dieser kleinen Maßnahmen eben nicht ausreicht, um diesen ganz großen Tanker Weltwirtschaft mit dem Konkurrenzdenken und der Wachstumserwartung von Milliarden von Menschen dahinter, umzustellen“, so Grunwald.
Prinzipielle und realistische Macht der Verbraucher
Grundwald ist aber auch der Auffassung, dass es im Alltag viel zu aufwendig ist, bei jedem konsumierten Artikel die Ökobilanz nachzuverfolgen. Wer das täte, sei nahezu ein Held. Er sieht die Verantwortung noch woanders:
Bioökonomie & Ethik
Ethik in der BioökonomieEin Stück Weg fehlt nochvon Celine Fries
Folgt man dem Bioökonomierat in seinem Verständnis von Bioökonomie, so ist das Hauptziel, Ökonomie und Ökologie so zu verbinden, dass nachhaltiges Wirtschaften möglich wird. Dies meint, natürliche Ressourcen ökonomisch zu nutzen, zugleich aber auf eine umweltfreundliche Weise, die den Erhalt natürlicher Kreisläufe sicherstellt. Andere Beschreibungen gehen noch weiter und besagen, dass mit der Bioökonomie eine Ressourcenwende herbeigeführt werden soll. Diese wiederum solle die Voraussetzungen für ein nachhaltiges und zukunftsorientiertes Wirtschaftssystem schaffen.

Messbar machen


GenmanipulationIm falschen Gewand
BiosiegelNicht alle halten ihr Versprechen
Wertschätzung
Insbesondere vor seinem theologischen Hintergrund sieht Markus Vogt darin ein großes Problem: „Die Schönheit der Natur lässt sich eigentlich nicht bezahlen. Dass wir nur alles unter dem Motto des Kaufens wahrnehmen, unter dem Motto des Verbrauchens und unter dem Motto des Besitzens, ist im Grunde eine ärmliche Reduktion der Wahrnehmung der Natur.“
Bei der Frage nach der angemessenen Wertschätzung natürlicher Ressourcen steckt die Gesellschaft moralisch also noch in einer Zwickmühle, denn Tatsache ist: Märke handeln hoch bepreiste Güter als knapp und qualitativ hochwertig. Mit diesem altbekannten Ansatz scheint es allerdings schwierig, den rein ökonomischen Blick auf Produkte, also letztlich auf Pflanzen, Tiere und natürliche Kreisläufe, zu überwinden.
Wirtschaft und EthikKein Konflikt
Bioökonomie & Gesellschaft
Nachhaltige WirtschaftWie die Bioökonomie den gesellschaftlichen Wandel herausfordertvon Nils Braunöhler
Die Bundesregierung hat im Januar 2020 ihre Bioökonomiestrategie vorgestellt. Das Ziel: Eine nachhaltige, kreislauforientierte Wirtschaft, die auf biologischen Ressourcen basiert. Gefördert werden Technologien, die biogene Rohstoffe nutzbar machen und zum Beispiel Erdgas, Kohle oder Öl ersetzen. Die Strategie orientiert sich an den Nachhaltigkeitszielen der Vereinten Nationen, die damit internationale Krisensituation vorbeugen und bewältigen will.
Das Leitprinzip der Bioökonomie ist die Kreislaufwirtschaft,
das auf dem Stoffkreislauf der Natur basiert.
Fossile WirtschaftGrenzenlose Verfügbarkeit
Weniger Wachstum, mehr Verzicht
ArbeitsmarktWeniger Produktion, weniger Arbeit
Und wenn die Menschen in der Bioökonomie genügsamer mit den vorhandenen Ressourcen umgingen, müsste weniger hergestellt werden. „Wo weniger produziert wird, fällt auch weniger Arbeit an“, so Eversberg. Es müsse daher darüber nachgedacht werden, vorhandene Arbeit gerecht umzuverteilen. Immerhin könnten die Menschen dann von mehr Freizeit und Lebensqualität profitieren.
Wir werden verzichten müssen
Die hemmende Rolle der Märkte
Mehr öffentliche Debatte
Postwachstum
PostwachstumsökonomieAußerhalb des WachstumswahnsinnsVon E. Cebulla
Rückblende auf den Frühjahrsbeginn 2020: Die venezianischen Kanäle füllen sich mit glasklarem Wasser und Delfine lassen sich deutlich öfter als sonst an der Küste vor Istanbul beobachten. Die positiven Auswirkungen des weltweiten Shutdowns 2020 auf die Natur sowie die unter den Einschränkungen leidende Wirtschaft rücken eine Frage in den Fokus: Wie könnte eine Wirtschaft aussehen, die nicht ständig wachsen muss? Eine Wirtschaft, die nicht Kapitalvermehrung in den Vordergrund stellt, sondern den Menschen, die Natur und Nachhaltigkeit? Könnte das unsere Zukunft sein?
Der Wunsch nach einer neuen Wirtschaftsordnung
Eine Lösung: die Gemeinwohl-Ökonomie
Wachstum muss nicht das oberste Ziel sein
Lässt sich der gängige Wachstumsgedanke mit einem Wirtschaftskonzept vereinen, das dem Wachstumsparadigma entkommen möchte, oder heißt es in der Gemeinwohl-Ökonomie vollständig und ohne Kompromisse: Wachstum adé? Felber zufolge lässt sich der Wachstumsgedanke in ein solches Konzept integrieren – aber anders als bislang: Es sollen nicht weiterhin die Finanzwerte wachsen, sondern die unterschiedlichen Aspekte von Lebensqualität – beispielsweise mehr ökologische Nachhaltigkeit, mehr gelingende Beziehungen, mehr Glück und Wohlbefinden, mehr Demokratie und Frieden. „Das Wachstum hört nicht auf“, erklärt er. Es verlagere sich nur hin zu neuen Zielen – zu solchen, die Menschen direkt und persönlich berühren.
Welthandel: ethisch korrekt und gemeinwohlorientiert
Gemeinwohl-Bilanz bereits heute in EU verankert
Wirtschaftshilfen an gesellschaftlichen Nutzen geknüpft
Große Konzerne sollen Verantwortung übernehmen
Corona-Pandemie könnte Entwicklungen neuen Schub geben
VERARBEITEN
BIOMASSE VERARBEITENVon der Wegwerf- zur Kreislaufwirtschaft

Biogasanlagen
BiogasanlagenVom Stall zur Steckdosevon My Hanh Huynh, Christoph Klein, Markus Schaupp und Leonie Zengerle
In Deutschland werden schon heute circa 60 Prozent der erneuerbaren Energien aus Stoffen wie Gülle, Mist, Lebensmittelabfällen und landwirtschaftlichen Produkten gewonnen. Aus dieser Biomasse wurden im Jahr 2019 laut des Umweltbundesamtes mehr als 50 Terawattstunden Biogas erzeugt. Das entspricht rund 12 Prozent des gesamten erneuerbaren Stroms. Jedoch können in Biogasanlagen nicht nur Strom, sondern auch Wärme und Biomethan für Kraftstoffe erzeugt werden.
Nachhaltig, flexibel, speicherfähigBiogas
Mit dem gewonnenen Biogas wird Strom erzeugt, der dann für Heizungen, Gasherde oder Kraftfahrzeuge genutzt werden kann. Wie dieser Prozess funktioniert, erklärt Landwirt Christian Endreß, der eine Biogasanlage im mittelfränkischen Ulsenheim betreibt:
Lagerstelle
Mais erzeugt besonders viel Energie, ist jedoch erst ab der Erntezeit im September verfügbar.
Lagerstelle
Mist von Schweinen, Rindern, Pferden und vielen weiteren Tieren ist das am häufigsten verwendete Material in Biogasanlagen.
Fermenter
Die angelieferten Rohstoffe werden durch Bakterien vergärt, wodurch verschiedene Gase entstehen. Diese werden an das Blockheizkraftwerk weitergeleitet.
Blockheizkraftwerk
Durch die in der Gärung entstandenen Gase wird ein Motor betrieben, der durch Drehbewegung Strom erzeugt. Als Nebenprodukt entsteht durch den Betrieb des Motors Wärme.
Reststoffe
Nachdem die Rohstoffe komplett verarbeitet wurden, können die Reststoffe von Landwirten als Dünger genutzt werden.
Speicherstelle
Falls im öffentlichen Netz kein Bedarf an Strom oder Wärme besteht, können die durch Gärung entstandenen Gase bis zu ihrer Weiterverarbeitung gespeichert werden.
Biogas in der Kritik
Je mehr Biogasanlagen es in einer Region gibt, desto teurer ist auch das Ackerland in der Umgebung. Der Grund: Die dort angebauten Nutzpflanzen können gewinnbringend an Biogasanlagen verkauft werden. Für landwirtschaftliche Betriebe, die Viehzucht betreiben und Futter für ihre Tiere anbauen, sind die Preise jedoch zu hoch. Der Ackerbau rentiert sich für sie nicht mehr.
Ein weiteres Problem: Beim Anbau von Biogaspflanzen entstehen immer mehr Monokulturen. So wird auf vielen Feldern zum Beispiel ausschließlich Mais angebaut, der besonders gut verkauft werden kann. Dem Boden werden dadurch langfristig Mineralien entzogen, wodurch er zunehmend unfruchtbar wird. Auch auf die Artenvielfalt in der jeweiligen Region hat das negative Auswirkungen.
Trotzdem haben Biogasanlagen Vorteile gegenüber anderen erneuerbaren Stromerzeugern. Dr. Wilhelm Böhmer, Direktor des Bayerischen Bauernverbands für Franken erklärt, welche das sind:
Ohne Bauern kein Biogas
Biogasanlagen nicht mehr rentabel?
Für viele Biogasanlagen laufen diese Förderungen Ende 2020 jedoch aus. Für eine Vielzahl der Betreiber werden ihre Anlagen dann nicht mehr wirtschaftlich sein und sie werden schließen müssen. Das trifft nicht nur die Betreiber: Auch die Bauern, die ihre Produkte unter anderem an Biogasanlagen liefern, verlieren dadurch ihre Haupteinnahmequelle. Der Bayerische Bauernverband geht davon aus, dass in den nächsten Jahren immer mehr landwirtschaftliche Betriebe schließen werden.
Für den Privatverbraucher bedeutet das: höhere Strompreise, Import von nicht ökologisch hergestellten Lebensmitteln aus dem Ausland sowie eine zunehmende Arbeitslosigkeit im landwirtschaftlichen Sektor. Der Bauernverband will dieser Entwicklung entgegenwirken und das Image von Biogasanlagen aufbessern, wie Dr. Wilhelm Böhmer erklärt:
Biokohle
PflanzenkohleKatalysator für die Umwelt von Alexander Borsig, Nils Aumann und Jonas Orf
und gewinnt das vielfältige Naturmaterial aus Reststoffen der Schokoladenindustrie.
Etwa 13 Millionen Tonnen biogene Reststoffe fallen in der deutschen Lebensmittelindustrie jährlich an. Das zeigt eine Studie der Hochschule Bremen und der Universität Gießen. Dazu kommen große Mengen an Grünabfällen und Holzresten aus der Land- und Forstwirtschaft. Häufig bleiben diese wertvollen Reststoffe ungenutzt. Der Würzburger Unternehmensgründer Felix Ertl hat dieses Potenzial erkannt: Mit seinem Start-Up Circular Carbon verarbeitet er Kakaoschalen aus der Schokoladenproduktion zu nährstoffreicher Pflanzenkohle. Diese kann zum Beispiel als Futtermittel oder Bodenverbesserer eingesetzt werden – und die Möglichkeiten der Pflanzenkohle sind damit noch lange nicht ausgeschöpft.
Umweltschutz für künftige GenerationenLebensgrundlagen erhalten
Das oberste Ziel des Gründers: die natürliche Lebensgrundlage auf der Erde für künftige Generationen erhalten. Der Einklang von Nachhaltigkeit und wirtschaftlichem Erfolg ist deshalb integraler Bestandteil seiner Unternehmensphilosophie. Mit Pflanzenkohle aus biologischen Reststoffen trägt sein Unternehmen Circular Carbon dazu bei, Treibhausgase zu reduzieren und leistet so einen Beitrag zum Umweltschutz.
Von der Kakaoschale zur Biokohle
Das Vorherbild zeigt die Kakaoschalen und Reststoffe der Schokoladenindustrie. Im Prozess der Karbonisierung entsteht aus dem Biorohstoff die Pflanzenkohle. Ihre Eigenschaften machen die Pflanzenkohle zu einem wertvollen Biomaterial, wie Felix Ertl im Interview erläutert:
Ein anpassungsfähiger Rohstoff
So haben die Temperatur, die Prozessdauer und die Aufwärmgeschwindigkeit Auswirkungen auf die fertige Biokohle: Wenn die Kohle zum Beispiel vor allem Mineralstoffe binden soll, muss sie bei niedrigen Temperaturen durchglühen. Bei höheren Temperaturen steigt wiederum die Stabilität der Pflanzenkohle.
EinsatzmöglichkeitenEin Multitalent
EinsatzmöglichkeitenPflanzenkohle als Futtermittel
Wird die Kohle von den Tieren schließlich wieder ausgeschieden, landet sie entweder direkt auf der Weide oder, in Form von Gülle, auf den landwirtschaftlichen Ackerflächen. In beiden Fällen gelangen ihre Nährstoffe in den Boden und fördern so das Pflanzenwachstum.
DürrePflanzenkohle als Wasserspeicher
Grundlage dieses Konzepts ist ein spezieller Strukturboden. Er verhindert, dass sich der Boden verdichtet, also verformt. Dadurch wird er belastbarer. Der Strukturboden setzt sich aus größeren Gesteinen mit geschützten Hohlräumen zusammen, in die dann Pflanzenkohle und Kompostmischungen eingespült werden. Die Pflanzenkohle funktioniert hier wie ein Schwamm: Sie speichert Wasser im Boden und hält es bei Starkregen zurück. Gleichzeitig bindet die Kohle wichtige Nährstoffe. Damit fördert die Pflanzenkohle das Wachstum der Bäume und hilft, ihren natürlichen Lebensraum wiederherzustellen.
Nachhaltig wohnen
Im Holzhaus zum KlimazielNachhaltig Bauen mit Holzvon Ioannis Karagogos und Tobias Vollmer
Laut Statistischem Bundesamt wurden 2019 in Deutschland rund 22.300 Neubauten in Holzbauweise genehmigt – fast 10.000 mehr als noch vor zehn Jahren. Damit wird derzeit fast jedes fünfte neue Haus aus Holz gebaut. Steigt dieser Anteil weiter, könnte der Holzbau in den kommenden Jahren einen erheblichen Teil zum Erreichen der Klimaschutzziele leisten, erklärt Ulf Rössler vom Münchner Architekturbüro dressler mayerhofer rössler:
Vom Baum bis zum HausHolz als CO2-Speicher
Werden die Bäume dann zu Bauholz und schließlich zum fertigen Holzhaus weiterverarbeitet, dient das Holz als wertvoller CO2-Speicher, während im Wald neue Bäume der Atmosphäre CO2 entziehen. Sofern regionales Holz zum Einsatz kommt, das keine unnötigen Transportwege verursacht, ist der Holzbau damit nahezu klimaneutral.
Der Münchner Prinz-Eugen-Park Eine ökologische Mustersiedlung
Der Münchner Prinz-Eugen-Park Eine ökologische Mustersiedlung


Auch das Architekturbüro dressler mayerhofer rössler hat aktiv an dem Projekt im Prinz-Eugen-Park mitgewirkt. Ulf Rössler berichtet bereits von positiven Rückmeldungen der ersten Bewohner: „Es ist unglaublich, was für eine Ausstrahlung dieser Baustoff hat“, so der Architekt.
Quelle Bilder: Michael Nagy / Landeshauptstadt München

In Qualität investieren
Baustoffe aus HolzrestenKeine knappe Ressource
Bierkohle
Holzkohleersatz für nachhaltiges GrillenGrillkohle aus Brauereirestenvon Nadine Achenbach und Vanessa Mei
Grund dafür ist die Holzkohle, die laut einer Studie des Unternehmens für Marktforschung Nielsen bei den meisten Deutschen den Grill anheizt. Das Fraunhofer-Institut UMSICHT hat aus Brauereiresten eine nachhaltige Alternative entwickelt. Projektmanager Fabian Stenzel erklärt, warum der Holzkohleersatz dringend gebraucht wird:
Illegaler Holzkohle-ImportEine Gefahr für unsere Wälder
Gleichzeitig gibt es in der EU für den Import von Holzkohle keine Kontrollinstanz. Es wird also auch nicht behördlich geprüft, ob die nach Deutschland importierte Holzkohle legal produziert wurde. Umso wichtiger ist es für umweltbewusste Verbraucher, selbst auf die Herkunft ihrer Grillkohle zu achten. Das Umweltbundesamt empfiehlt Holzkohle mit einem FSC-Siegel. Dieses garantiert unter strengen Kontrollen, dass das verwendete Holz aus einer nachhaltigen Forstwirtschaft stammt.
Nachhaltige AlternativenGrillkohle aus Produktionsresten
Nur vermeintlich nachhaltiger?Lange Transportwege als Klimafaktor
Aus der RegionDas Problem mit dem Biertreber
Biertreber ist sehr eiweiß- und ballaststoffhaltig und wird in der Landwirtschaft als Futtermittel eingesetzt. Weil er schnell verdirbt, entsteht jedoch vor allem in großstädtischen Regionen häufig ein Biertreber-Überschuss. Zusätzlich erschweren gesetzliche Futtermittel-Restriktionen eine langfristige Nutzung der Brauerei-Abfälle. So bleiben die Reststoffe oft ungenutzt und müssen von den Brauereien aufwendig entsorgt werden.
Hans-Peter Drexler, Braumeister und technischer Betriebsleiter bei Schneider Weisse beschreibt, um welche Ausmaße es sich handelt:
Holzkohle-Ersatz aus der RegionVom Biertreber zur Grillkohle
Gleicher Grillspaß mit besserem GewissenDie Qualität entscheidet
Verwertung problematischer Abfälle
Saubere Energie – Dreckiges Ende? Recycling von Windkraftanlagen von Phillip Charlet und Marvin E. Molwitz
5.000 Anlagen vor dem Aus?
Eine Studie des Umweltbundesamts prognostiziert einen verstärkten Rückbau von Windkraftanlagen und warnt vor Engpässen bei den Recyclingkapazitäten. Doch nicht nur die ablaufende EEG-Förderung ist ein möglicher Grund dafür, dass bald zahlreiche Anlagen abgebaut werden könnten. Lars Schnatbaum-Laumann von der EnergieAgentur.NRW erläutert:
Recycling als HerausforderungProblematische Bestandteile
Zwar kann die Glasfaser aus GFK-Abfällen als Sandersatz in Zementwerken wiederverwertet werden, der übrige Kunststoff wird jedoch nur energetisch recycelt, also verbrannt. CFK-Anteile werden bislang nicht einmal in die Verbrennungsanlage gegeben, da sie diese beschädigen können. Die Beseitigung dieser Abfälle könnte zum Problem werden.
Frank Kreimer, Geschäftsführer der Hagedorn Abbruchservice GmbH, warnt vor den Folgen unsachgerechter Entsorgung:
Teurer Rückbau80.000 Euro pro Megawatt
Für die Betreiber bleibt der Rückbau dennoch ein Problem, vor allem in finanzieller Hinsicht: Nach Aussage des Bundesministeriums für Wirtschaft und Energie kostet der Rückbau einer Windkraftanlage durchschnittlich rund 80.000 Euro pro Megawattstunde. Zum Vergleich: Eine Windkraftanlage mit einem Megawatt Leistung erwirtschaftet bei 1.800 Volllaststunden im Jahr ca. 16.600 Euro Nettogewinn. Laut Kreimer variieren die Kosten für den Rückbau allerdings stark in Abhängigkeit von Standort, Typ, Zustand, Alter und Wiederverwertbarkeit der Anlage.
Kreislaufwirtschaft unmöglich?Keine Lösung in Sicht
Die Herausforderung bestehe darin, „ein wirtschaftliches und vor allem ressourceneffizientes Verfahren für das Recycling von glas- und kohlefaserverstärkten Kunststoffen zu entwickeln“, macht auch Alexander Hofmann, Gruppenleiter Recyclingtechnologien bei Fraunhofer UMSICHT, deutlich. Eine vollständige Kreislaufwirtschaft sieht er in naher Zukunft als unrealistisch:
MedizintechnikNachhaltige Materialien auf dem OP-Tischvon Svenja Zeitler
Medizinprodukte im Wandel
Erforschung von Biopolymeren
Auch Polyactid (PLA) und Polyhydroxyalkanoate (PHA) zählen dazu. Während PLA auf der Basis von Maisstärke und Milchsäure hergestellt wird, werden PHA von Bakterien als Energiereserve produziert. Beide Biopolymere werden intensiv erforscht und sind vereinzelt schon für die Verwendung im medizinischen Bereich zugelassen.
Kunststoff-Alternativen sind einsatzbereit
Gerade im Verpackungsbereich ist der Umstieg auf die nachhaltige Alternative naheliegend: Die Produkte haben meist eine geringere Lebensdauer und werden nach einmaliger Benutzung recycelt oder entsorgt. "Anders als bei Produkten, die mehrere Jahrzehnte im Einsatz sind, ist hier keine aufwendige Erforschung von Langzeiteigenschaften der eingesetzten Biopolymere nötig", erklärt der Materialentwickler des SKZ.
In der Praxis keine Priorität
In Krankenhäusern wie dem Klinikum in Bamberg stünden Aspekte wie die praktische Anwendung und die Risikobewertung noch über der Umweltverträglichkeit. So könnten zum Beispiel neue, nachhaltige Produkte umständlicher in der Handhabung sein und damit eine Fehlerquelle sein, sagt Lindner. Als Beispiel führt sie ein umweltfreundliches Reinigungsmittel an, das sich in der Anwendung möglicherweise von herkömmlichen Produkten unterscheidet und damit reibungslose Abläufe im Klinikalltag stört.
Von Seiten der Anwender sprechen also trotz der generellen Bereitschaft zu mehr Nachhaltigkeit noch Funktionalität, Praktikabilität und der Kostenfaktor gegen umweltfreundlichere Medizinprodukte. Und auch der Preis für nachhaltige Materialien liegt noch über dem für konventionelle Produkte. Rudloff erklärt wie man kostengünstiger produzieren könnte:
Wirtschaftlicher DruckNachhaltigkeit in der Pharmaindustrie
Erfahrungswerte sammeln
Bei der Zulassung als Medizinprodukt stehe den Biokunststoffen eigentlich nichts im Wege. Die Richtlinien, welche die Zulassungsvoraussetzungen für Biopolymere in der Medizintechnik festlegen, unterscheiden häufig nicht zwischen biobasierten oder petrochemischen Materialien. Prinzipiell spreche laut Rudloff deshalb nichts gegen die Zulassung von Medizinprodukten aus Biokunststoffen. Das Hauptproblem sei vielmehr die geringe Erfahrung mit den noch recht jungen Werkstoffen. Oft seien Zulassungen schlicht noch nicht vorhanden und bestimmte Aspekte noch nicht ausführlich genug erforscht. Das könne sich jedoch in den nächsten Jahren und Jahrzehnten ändern.
Erfolg in Sicht
Mit kontinuierlicher Forschung zum Ziel
Essenziell für die Lösung der bestehenden Probleme ist für Rudloff insgesamt die kontinuierliche Erforschung der Biopolymere: Von der Grundlagenforschung über die vorwettbewerbliche Forschung bis hin zur industriellen Forschung, bei der ein Prototyp für die eigentliche Anwendung entwickelt wird. Das zu unterstützen sei Aufgabe der Politik:
Wie Fleischersatzprodukte Umwelt und Gesundheit schonenFast Fleischvon Anne Köppen
Öffnet man die Verpackung des „Lotao Jackfruit Currys“, strömt einem der Geruch von orientalischen Gewürzen in die Nase – ein Hauch von Schärfe. „Die neue Alternative zu Fleisch“ steht auf der Packung. Die dunkelbraun marinierten Fleischersatz-Stücke sind faserig, weich und gut gewürzt – und erinnern an Rindfleischstücke in einem Gulasch. Aber: Es ist Jackfruit. Noch nicht allzu lang reiht sich die Tropenfrucht in die Auswahl an Veggie-Burgern oder vegetarischem Aufschnitt ein. Viel über die Frucht aus dem asiatischen Raum wissen die meisten Konsumenten bislang nicht. Dabei liefert sie gute Gründe, auf Fleisch zu verzichten.
Jackfruit als Fleischersatz
Gründer des Unternehmens Lotao aus Berlin. Die größte an Bäumen wachsende Frucht ist, noch unreif geerntet, weitgehend geschmacksneutral. Der Kunde bekommt sie in Salzlake eingelegt sowie als Curry oder Geschnetzeltes zubereitet. Manko der Frucht: ihr niedriger Proteinanteil. Und dass sie bereits etliche Kilometer aus Bangladesch oder Thailand zurückgelegt hat, bevor sie auf unseren Tellern
landet.
Positive Ökobilanz von Ersatzprodukten
Beim Kauf von Fleischersatz aus Jackfruit sollten die Konsumenten auf die Anbaubedingungen achten. Sind die Früchte fair gehandelt und tragen sie Bio-Siegel? Oder kommen sie aus Monokulturen und nicht zertifiziertem Anbau? Wissenschaftliche Erkenntnisse zur Ökobilanz von pflanzlichen Fleischersatzprodukten gibt es bislang nur in Bezug auf Soja. Eine Studie des Umweltbundesamts (UBA) kam gerade zu dem Ergebnis, dass für die Produktion eines Kilogramm Fleischersatz auf Sojabasis 2,8 Kilogramm Treibhausgase ausgestoßen werden. Zum Vergleich: Für Schweinefleisch liegt der Wert bei 4,1 kg, für Geflügel bei 4,3 kg und für ein Kilogramm Rindfleisch sogar bei 30,5 kg.
Fleischverzehr geht zurück
NährstoffeEs geht auch ohne Fleisch
Fleisch verzichtet, sollte der DGE zufolge durch eine ausgewogen und abwechslungsreiche Ernährung mit Milch- und Milchprodukten, Eiern, Gemüse und Hülsenfrüchten, Obst, Vollkornprodukten, Nüssen und Samen die Versorgung mit
allen wichtigen Nährstoffen sicherstellen.
Die Konsumenten sind gefragt
Die beispielsweise gehören zum Angebot des Unternehmens amidori aus Bamberg: Mithilfe eines vom Fraunhofer-Institut für Verfahrenstechnik und Verpackung (IVV) in Freising entwickelten Verfahrens stellt das Unternehmen Fleischersatz auf der Basis von Erbsenproteinen her. „Es ist unser Anspruch, daran zu forschen, wie wir Fleischersatz nachhaltiger gestalten können", sagt Raffael Osen, Abteilungsleiter Verfahrensentwicklung beim Freisinger Fraunhofer-Institut. "Also zum Beispiel Pflanzenrohstoffe verwenden, die hier auf dem Feld wachsen. Lupine ist da eine super Möglichkeit.“ Die Hülsenfrucht mit 40 Prozent Proteinanteil lässt sich regional und auf nährstoffarmen Böden anbauen. Ähnlich wie die Erbse, die seit 2015 die Basis für die Pflanzenproteine von amidori ist.
Pflanzenproteine ohne den Umweg übers Tier nutzen
Wo Wind und Sonne fehlen:Kraft-Wärme-Kopplung als Alternativevon Alicia Weigel
Die gesamte Energie für das eigene Haus selbst zu produzieren: Das wünschen sich viele Verbraucher nicht nur aus ökologischen, sondern auch aus ökonomischen Gründen. Neben Photovoltaik oder Windanlagen gibt es eine weitere Möglichkeit: Kraft-Wärme-Kopplung, kurz KWK. Die Blockheizkraftwerke erzeugen gleichzeitig Strom und Wärme, ein Verbrennungsmotor treibt dabei einen Stromgenerator an. Die anfallende Abwärme wird dann für die Heizung und das Warmwasser genutzt.
Versorgungssicherheit durch Erdgas
Suche nach neuem Energieträger
Für eine klimaneutrale Zukunft
Die Herausforderung: Gerade am Anfang wird nur ein sehr geringer Anteil an Wasserstoff ins Gasnetz gemischt. Die Anlage soll sich dann ohne manuelle Einstellungen automatisch auf den Wasserstoffanteil anpassen und so immer die bestmöglichen Wirkungsgrade unter Einhaltung der Emissionsgrenzwerte erreichen. Damit wäre der "Dachs" komplett klimaneutral, sagt Hagen Fuhl. Das Ziel: ein emissionsfreier Gebäudebestand. In in paar Jahren soll der "Dachs" in einer neu gebauten Schule in Haßfurt eingesetzt werden, da die Stadt hier ihr Gasnetz bereits mit Wasserstoff speist. Foto: Eckhard
Regulierbare Anlagen sind notwendig
Soll heißen: Es sollen Anlagen gebaut werden, die regulierbar sind. „Wir brauchen Anlagen, die nach links und rechts schauen und dann liefern, wenn kein Strom und keine Wärme von den erneuerbaren Energien kommt“, sagt Gores. Ähnlich sieht das Fuhl: „Die KWK hilft, die Schwankungen der Erneuerbaren auszugleichen. Damit kann die Versorgungssicherheit in Deutschland auch dauerhaft gewährleistet werden“. Laut KWK-Evaluierungsbericht des Bundeswirtschaftsministeriums werden heute bereits 19 Prozent des deutschen Gesamtstrombedarfs durch Kraft-Wärme-Kopplung sichergestellt.
Regularien als Hindernisse
Nachhaltige Baustoffe / SKZ
Carbonbeton und Recycling steigern die Nachhaltigkeit am BauKlimaneutrales Bauenvon Lea Reuter
„Wenn wir Baustoffe in einer kritischen Menge produzieren und verwenden, ist es irgendwann nicht mehr nachhaltig. Dann ist es einfach zu viel“, sagt Hermann Achenbach, Leiter der Forschungsgruppe „Nachhaltigkeit und Kreislaufwirtschaft“ beim Kunststoffzentrum in Würzburg (SKZ). Und werde weiterhin so viel Beton eingesetzt wie bisher, führe das zu akutem Mangel an Ressourcen wie Sand und Kies.
Suche nach Zementersatz
Aber die Suche nach nachhaltigen Alternativen hat begonnen. Seit 2014 läuft das C³-Projekt über Carbonbeton an der TU Dresden mit rund 160 Partnern, darunter dem SKZ. Das SKZ forscht neben Carbonbeton an holzbasierten Kunststoffen und Rohren aus Industrieabfällen, die ebenfalls im Baubereich Anwendung finden.
Herstellung auf Erdölbasis
„Stahlbeton hat sich sukzessive in den letzten 100 Jahren als der Massenbaustoff entwickelt“, sagt Dr. Matthias Lieboldt, C³-Projektmanager. Das Problem: Der Stahl, der im Beton als Bewehrung eingesetzt wird und dadurch den Baustoff verstärkt, korrodiert mit der Zeit - das Bauteil versagt.„Die Stahlbewehrung im Beton muss also vor Korrosion geschützt werden“, erklärt Lieboldt. Bis zu acht Zentimeter dick muss solche eine Mindestüberdeckung sein: Es wird für den Korrosionsschutz also viel Beton benötigt.
Carbonbeton: korrosionsfrei, leicht, tragfähig
Hohe CO2-Werte, weniger Beton
Laut Lieboldt wird CO2 also hauptsächlich dadurch reduziert, dass weniger Beton benötigt wird. Im Vergleich zu Stahlbeton könnten bis zu 80 Prozent an Beton eingespart werden. Die Nutzungsdauer von Carbonbetonbauten wird auf 200 Jahre geschätzt. Ein Nachteil: Carbon ist etwa 15-fach teurer als Stahl. Dafür lässt sich Carbonbeton besser recyceln.
Heimisches Holz nachhaltiger als WPC
Neue Rohre aus Abfällen
Projekte für die Zukunft
Nachhaltige Wasserwirtschaftvon Kathrin Koltunow
In Mitteleuropa braucht der Mensch täglich gut zweieinhalb Liter Wasser, in heißen Wüstengegenden oder in Regionen der trockenen Arktis sogar zwischen acht und 15 Liter. Ohne Wasser ist also kein Leben möglich. Vor etwa 3,5 bis vier Milliarden Jahren entwickelte sich auf der Erde aufgrund von Wasser Leben. Um genügend Nahrung zu bekommen, sind wir auf ein ausreichendes Angebot an Trinkwasser angewiesen. Doch obwohl die Erdoberfläche zu 70 Prozent mit Wasser bedeckt ist, beginnt für den Menschen das notwendige Gebrauchswasser, nämlich Süßwasser, knapp zu werden.
Wassermangel auf der Welt
Testsysteme zur Abwasseranalyse
Testsysteme zur Abwasseranalyse


Thomas Benkert, Biochemiker im Bereich molekulare Genetik, entwickelt mit seinem in Schweinfurt ansässigen Unternehmen DyeNA Genetics Testsysteme, die speziell in der mikrobiologischen Abwasseranalytik eingesetzt werden. Mithilfe der quantitativen Real-Time PCR (kurz: qPCR), einer Vervielfältigungsmethode für Nukleinsäuren, können dabei lebende und tote Bakterien in Abwasserproben präzise bestimmt werden.
Quelle Bilder: Oliver Mauder

Wasser wird wichtiger
Vielseitiges Testsystem
Da der Nachweis des Virus somit als eine Art Frühwarnsystem genutzt werden kann, hat DyeNA Genetics ein SARS CoV-2-PCR- Testsystem speziell für die Abwasseranalytik entwickelt. Die Messung der Viruslast im Abwasser kann auch dazu beitragen, die Dunkelziffer der mit dem Virus erkrankten Personen besser bewerten zu können. „Das ist sozusagen ein doppeltes System, was ziemlich vorteilhaft ist“, so Benkert.
Schadstoffe im Abwasser nehmen zu
Im Wesentlichen hängt es von den Privathaushalten, Krankenhäusern, der Industrie und nicht zuletzt von der Landwirtschaft ab, wie mit Trink- und Brauchwasser umgegangen wird und wie es nach der Benutzung verunreinigt wird. „Es gibt viele pharmazeutische Reststoffe, Antibiotikaresistenzen oder Mikroplastik, von denen wir noch nicht wissen, was es eigentlich bedeutet, wenn sie in der Umwelt sind“, so Professor Drewes von der TU München.
Alternativen für die Zukunft
Grundsätzlich sollte man sich darüber im Klaren sein, dass Randbedingungen wie der Klimawandel, die zunehmende Urbanisierung und Industrialisierung das derzeitige Abwassersystem vor erhebliche Herausforderungen stellen. Es müssen Alternativen und Lösungen bereitgestellt werden, indem Wasserkreisläufe partiell geschlossen oder Programme zur Wasserrückführung und Wasserrecycling eingeführt werden. Ein erster Schritt dahingehend ist sich des Problems bewusst zu werden und Maßnahmen sowohl in der Industrie als auch bei jedem einzelnen einzuleiten.
Recyclefähige Verpackungen
Wie Verpackungen recyclingfähiger werdenGut verpackt und voll recyceltvon Anna Hartmann
Umweltverschmutzung und überflüssiger Müll – Verpackungen haben ein schlechtes Image. Unverpackt-Läden gewinnen deshalb an Beliebtheit. Joachim Christiani ist Geschäftsführer des Aachener Instituts für Recycling und Produktverantwortung cyclos-HTP. Laut ihm entspreche Abfallvermeidung nicht unserer Gesellschaftsstruktur. „Der Fokus muss auf der Optimierung von Verpackungen liegen, um deren Recyclingfähigkeit zu steigern“, sagt Christiani.
Steigende Menge an Verpackungsabfällen
Recycling laut Gesetz
Außerdem schreibt das Gesetz höhere Recyclingquoten für Verpackungen vor, die in Deutschland auf den Markt gebracht werden. Ab 2022 sollen 90 Prozent der Verpackungen aus Glas, Aluminium, Eisenmetallen sowie Papier, Pappe und Karton recycelt werden. Bei Kunststoffverpackungen liegt die vorgeschriebene Recyclingquote dann bei 63 Prozent.
Umstellungsprozesse als Herausforderung
Beurteilung von Recyclingfähigkeit
Probleme beim Recycling
Ein weiteres Problem liegt in den Etiketten. Sind sie zu groß, wird die ganze Verpackung nach dem Material des Etiketts sortiert. Eine PET-Flasche mit großem PVC-Etikett etwa würde nicht als PET-Flasche erkannt, sondern als PVC aussortiert werden. Die recyclebare Verpackung geht verloren. Auch die Farbe von Verpackungen kann Recycling verhindern. Gerade bei schwarzen Hüllen mit traditioneller Ruß-Pigmentierung ist das problematisch, da sie bei der Sortierung nicht reflektieren. Das Nah-Infrarot-Gerät, das Verpackungsmaterialien erkennt, empfängt kein Signal und wertvolle Materialien gehen verloren.
Optimierungen auf Software-Basis
Zusammensetzung der Verpackungen
Ein weiteres Beispiel sind Flaschen mit trennbaren Full-Sleeve-Etiketten, die Verpackungen wie eine zweite Haut umschließen und ohne Klebstoff halten. Durch eine Perforation können Kunden diese Hülle abziehen, sodass die Verpackung ohne störende Elemente recycelt werden kann. Zenger erläutert, warum Henkel die Software öffentlich zu Verfügung stellt: „Henkel möchte mit dem Programm die Kreislaufwirtschaft voranbringen – nicht nur auf Unternehmensebene, sondern auch entlang der gesamten Wertschöpfungskette.“
Kunststoff als Wertstoff
Plastik-Alternativen
Plastik-AlternativenDie Kunststoffe der Bioökonomie

Doch welche Alternativen gibt es? Was hat es mit Bioplastik auf sich? Und wie recyclingfähig sind „kompostierbare Kunststoffe“ tatsächlich?
Bioplastik – seine Stärken, seine Schwächen
Biokunststoff: Seine Stärken, seine SchwächenBio = besser?von Lara Jack
Drei Viertel des Mülls, welcher in den Weltmeeren schwimmt, bestehen laut WWF aus Plastik. Und jedes Jahr kommen zwischen 4,8 und 12,7 Millionen Tonnen dazu. Das entspricht ungefähr 75 voll beladenen Containerschiffen. Dass Kunststoff sich so langsam zersetzt und nicht verrottet, macht die Situation noch schlimmer. Und: Plastik zerfällt in Mikroplastik und landet über die Nahrungskette im menschlichen Körper.
Plastik im Alltag
Zwei Arten von Biokunststoffen
Doch ganz so einfach ist das nicht. Drei Aspekte sind kritisch: Weil zur Herstellung meist stärkehaltige Pflanzen, wie Mais oder Zuckerrohr, benötigt werden, konkurriert es mit der Nahrungs- und Futtermittelindustrie. Außerdem lässt es sich nicht so leicht abbauen wie von der Industrie dargestellt wird und seine Herstellung ist, im Vergleich zum herkömmlichen Plastik, zu teuer, um wettbewerbsfähig zu sein.
Bioplastik muss nicht teuer sein
“PLA ist ein Plastik, das nur aus dem Grund nicht weiter in den Markt gekommen ist, weil der Rohstoff Milchsäure noch zu teuer ist, um ein Plastik daraus herzustellen, das mit aus Erdöl gewonnenem Plastik preislich mithalten kann.”
Abbau von BioplastikKeine 100 Jahre in unserer Umwelt
Eine Verpackung, auf der “biologisch abbaubar” oder “biobasiert” steht, wecke beim Verbraucher allerdings das Gefühl, dass es nicht ganz so verwerflich sei, dieses Produkt zu kaufen und später wegzuwerfen – so der Einwand einiger Bioplastik-Kritiker. Das fördere wiederum einen verschwenderischen Umgang mit derartigen Verpackungen. Läufer entgegnet: “Wenn man dieses Plastik wegwirft, weiß ich, es entsteht kein jahrtausenderlanger Schaden."
Kritik am Biokunststoff
Auch die Entsorgungsfrage sei noch nicht geklärt, erklärt Schägg. Würde PLA nämlich nicht fachgerecht entsorgt, könne das dazu führen, dass es aussortiert und verbrannt wird. PLA im Biomüll sei aber auch nicht sinnvoll, weil die Kompostanlagen nicht die notwendigen Temperaturen für die Zersetzung des PLA aufbringen. Sie sieht die Lösung des Abfallproblems vielmehr in der Nutzung und Förderung von Mehrwegsystemen. Falls dies nicht möglich sei, solle der eingesetzte Kunststoff zumindest recyclingfähig sein und eine korrekte Entsorgung sichergestellt werden.
PolitikVerbindliche Ziele
Forschung für den Markt
Er beschäftigt sich im Rahmen des Forschungsprojektes EFRE-FIS mit diversen nachhaltigen Verpackungen aus nachwachsenden Rohstoffen, zum Beispiel mit Graspapier zum Verpacken von Äpfeln. Äpfel in der Graspapier-Verpackung werden schon heute bei der Supermarktkette Rewe verkauft – komplett ohne herkömmliches Plastik. Und die Nachfrage nach nachhaltigen Verpackungen nimmt, laut Pude, ständig zu. Dies bedeutet sowohl Fortschritt als auch Herausforderung. Sensible Produkte, wie Fleisch, könnten nicht in nachhaltigen Verpackungen aufbewahrt werden, da diese nicht die nötige Dichte aufbringen, erklärt Pude.
In Zukunft will er mit seiner Forschung aber auch diese Lücke schließen und einen Verpackungsstoff entwickeln, der zum Beispiel antimikrobiell beschichtet sein könnte. Um die bislang recht hohen Kosten der Verpackungen aus nachwachsenden Rohstoffen macht sich der Forscher keine Sorgen, denn das würde in Zukunft “großtechnischer gemacht”. Und damit sinke wiederum auch der Preis. Prof. Pude ist zuversichtlich: “Das ist eigentlich nur noch eine Frage der Zeit, dass das konkurrenzfähig wird.”
MüllvermeidungUmdenken für die Umwelt
Upcycling: Einweggeschirr aus Naturfasern
Einweg trifft auf Upycyclingvon Jaqueline Fölkel und Eva Schönwitz
Das Ziel: Plastikrückstände und die Kosten, die durch Umweltverschmutzung entstehen, zu reduzieren.
Rund 350.000 Tonnen Abfall für Einweggeschirr und To-Go-Verpackungen fielen 2017 laut der Gesellschaft für Verpackungsmarktforschung an. Rund ein Drittel davon bestehen aus Kunststoff.
Vermeintliche LösungBio-Plastik
Demnach stehen auch Plastikalternativen bereits in der Kritik. Vermeintliche Bio-Kunststoffe aus Zuckerrohr können zum Teil nicht kompostiert werden und Einwegprodukte aus Pappe oder Papier sind nur dann empfehlenswert, wenn sie aus recyceltem Material hergestellt wurden. Dass Bio-Plastik häufig nur als solches vermarktet wird, weiß auch Julia Piechotta, Gründerin von Spoontainable:
Eine Utopie?Wirtschaften ohne Abfall
Recycling, Downcycling und Upcycling: Verfahrensweisen, deren Ziel es ist, einen dauerhaften Kreislauf zu bilden, welcher die Umwelt schont. Upcycling ist neben dem bekannten Recycling eine Form der Wiederverwertung, die eine Aufwertung von Stoffen mit sich bringt.
Reststoffe nutzen
Spoontainable macht´s vor
Wunsch nach mehr Politik
und recycelbaren Rohstoffen, positiv entwickelt. Ausschlaggebend hierfür sieht er in der Entwicklung der Food-Service-Industrie, dem wachsenden Bewusstsein für Nachhaltigkeit und dem Befinden in einem Nischenmarkt.
Das Verbot von Einweggeschirr sieht er allerdings kritisch.
Foto: Greenbox
Bioplastik FHWS
Kommt Plastik bald auf den Kompost?Kompostierbarer Kunststoffvon Birte Kock
Das neue deutsche Verpackungsgesetz sieht vor, dass alle, die gefüllte Verpackungen in Umlauf bringen, für deren Rücknahme und Verwertung verantwortlich sind. Das stellt viele Hersteller vor Herausforderungen, denn zu viel des Plastikmülls kann nicht recycelt werden und sie müssen für die entstehende Umweltverschmutzung bürgen. Eine mögliche Lösung erforscht das Fraunhofer-Institut für Silicatforschung (ISC) in Würzburg: Verpackungen aus kompostierbaren Kunststoffen sollen den Markt verändern.
Bis zu 12,7 Millionen Tonnen Plastik im JahrEin Problem für Mensch und Natur
Plastik verschmutzt die Umwelt mit langfristigen Folgen für Mensch und Natur – dieses Problem ist inzwischen weit bekannt. Jedes Jahr gelangen 4,8 bis 12,7 Millionen Tonnen Plastik in die Meere. Laut der Umweltschutzorganisation WWF steuert gerade Verpackungsmaterial für Lebensmittel einen großen Teil dazu bei. Diese ausgedienten Verpackungen gelangen hauptsächlich vom Land aus über Flüsse in die Meere.
Forschung am Würzburger Fraunhofer-Institut ISCNachhaltige Funktionsschichten
„Das Problem ist, dass solche zusammengesetzten konventionellen Folien nicht recycelt werden können“, sagt die Materialforscherin. Seit acht Jahren arbeitet sie an einer – inzwischen preisgekrönten – Funktionsschicht aus biologischen Materialien, die bioabbaubar und kompostierbar ist. Diese Schicht kann dann als Barrierelack auf Biokunststoffe und konventionelle Kunststoffe aufgetragen werden. Selbst konventionelle Verpackungsfolien werden dadurch einfacher recycelbar, sagt Amberg-Schwab.
Foto: Fraunhofer ISC
Keine einheitliche Recycling-InfrastrukturDoch nicht kompostierbar?
Denn während sich die Zertifizierung als "biologisch abbaubar" auf labortechnische Bedingungen bezieht, seien die Kompostierungsverhältnisse in der Realität häufig nicht gesichert. Demnach stellen biologisch abbaubare Kunststoffe eher Störstoffe dar, die nicht normgerecht abgebaut werden können. Solange es keine einheitliche Recycling-Infrastruktur gebe, müssten die Biokunststoffe auch im Restmüll entsorgt werden, so der Umwelt- und Verbraucherschutzverband.
Kreislauf statt Kompost
Umweltbewusstsein schaffen
Die Wissenschaftlerin appelliert zudem an die Verbraucher, sich möglichst zuverlässig zu informieren mit Blick auf die gebrauchten Verpackungen. Das sieht auch der Aktionsplan der EU vor: Nur, wenn alle Verbraucher bewusster mit Verpackungen umgehen, kann in Zukunft das korrekte Kompostieren von abbaubaren Kunststoffen zu einer nachhaltigen Kreislaufwirtschaft führen.
BIOKRAFTSTOFFE
Ethanol aus AgrarrestenBiokraftstoffe 2.0
Fossile Ressourcen werden immer knapper. Laut dem Energiereport des Mineralölunternehmens BP betrug der weltweite Erdölverbrauch im Jahr 2019 knapp 14 Millionen Tonnen Erdöl am Tag. Rund 40 Prozent davon werden zur Kraftstoffherstellung genutzt und fließen damit in den Individual-, Güter- oder Flugverkehr.
Gleichzeitig verursacht der Verkehrssektor ein Viertel der weltweiten Treibhausgasemissionen, die nach Auswertungen der Wissenschaftsorganisation Global Carbon Project kontinuierlich ansteigen. Die Entwicklung und der flächendeckende Einsatz umweltfreundlicher Kraftstoffalternativen für den Personen- und Güterverkehr ist deshalb trotz verbesserter Antriebstechnologien unabdingbar, um die Treibhausgasemissionen langfristig zu reduzieren und die im Pariser Klimaabkommen festgesetzten Klimaziele zu erreichen.
Fortschrittliche BiokraftstoffePflanzenreste statt Futtermittel
95 Prozent weniger CO2
Als Energielieferant dient stattdessen ein Nebenprodukt des Verfahrens, das Lignin, der holzige Bestandteil, der in vielen Agrarresten enthalten ist. Es kann nicht zu Bioethanol verarbeitet werden und wird deshalb energetisch genutzt. Die sogenannte Vinasse, eine nährstoffreiche Flüssigkeit, die ebenfalls als Nebenprodukt des Verfahrens entsteht, kann zudem als Biodünger zurück aufs Feld gebracht werden. Ein Paradebeispiel für eine Kreislaufwirtschaftslösung durch die umfassende Nutzung erneuerbarer Ressourcen, erklärt Hortsch. Im Vergleich zur Herstellung fossiler Kraftstoffe spart das Verfahren rund 95 Prozent CO2-Emissionen ein. Wird das im Prozess abgegebene CO2 zusätzlich gespeichert, sind laut Hortsch sogar negative Emissionen von bis zu 120% möglich.
Ein rohstoffflexibles VerfahrenVon Miscanthus bis Zuckerrohr
Kurze Wege fürs Klima
Auch Biotechnologe Ekhard Boles, Professor für Mikrobiologie an der Goethe-Universität in Frankfurt am Main befürwortet ein solches „dezentrales Modell“: „Wenn man die Reststoffe von sehr weit herantransportieren muss, wird es fragwürdig.“ Allerdings seien solche regionalen Anlagen häufig sehr klein, ihre Betriebskosten fielen dadurch sehr stark ins Gewicht. „Man braucht einen Kompromiss zwischen der Größe der Anlage und dem Umkreis, aus dem man die Reststoffe einsammelt.“ Die Nutzung von regionalen Abfällen sei dann nicht nur ökologisch, sondern auch preislich die bessere Variante.
Ganz ohne fossile Kraftstoffe?
Lokale Strukturen stärken
Wasserstoff als Energiespeicher
Wie Haßfurt Wasserstoff zum Energiespeicher der Zukunft machtvon Renan Schmid
Haßfurt ist in Sachen regenerative Energien ein Vorreiter in Deutschland, wenn nicht gar in Europa. Während Deutschland verstärkt darauf setzt, mit Wasserstoff Autos oder Lkw anzutreiben, will die EU mit Wasserstoff auch die Industrie langfristig zur Klimaneutralität führen: Wasserstoff, so die Europäische Kommission, könne „die Dekarbonisierung von Industrie, Verkehr, Stromerzeugung und Gebäuden in ganz Europa unterstützen“.
In Haßfurt wird Windstrom in Wasserstoff gespeichert
Zösch ist sich der Vorreiterrolle bewusst. Er sieht vor allem im Speichermedium Wasserstoff die beste Lösung, um den Auswirkungen des Klimawandels effizient entgegenzusteuern. Man müsse für die Energiewende den weiteren Ausbau „unterstützen und nicht behindern", fordert der Stadtwerk-Geschäftsführer.
Windkraft spielt große Rolle
Doch ist der Ausbau der Windkraftanlagen ins Stocken geraten, in Bayern durch die umstrittene 10H-Regelung (Abstand zu Wohngebäuden in Gebieten mit Bebauungsplan mindestens das 10-Fache ihrer Höhe) gar zum Erliegen gekommen. Norbert Zösch kann diese Regelung nicht nachvollziehen, so könne man die Energiewende nicht vorantreiben. Gerade für den Ausbau der Wasserstofftechnologie seien neue Windkraftanlagen unerlässlich.
Entwicklung aus Erlangen:Wasserstoff wird in Öl gespeichert
Das Szenario: Windkrafträder produzieren überschüssigen elektrischen Strom, so wie in Haßfurt. In einem Hydrier- Reaktor wird der Wasserstoff unter Druck mit Dibenzyltoluol, einer organischen Flüssigkeit, kurz LOHC (engl.: liquid organic hydrogen carriers), zusammengebracht und fest daran gebunden. „Das Prinzip ähnelt dem Füllen und Leeren einer Pfandflasche, die danach für den nächsten Speicherzyklus wieder bereitsteht“, so Wasserscheid. Gebunden an das flüssige Dibenzyltoluol lässt sich der Wasserstoff gefahrlos transportieren. Abnehmer können eine beliebige Industrieanlage oder eine Wasserstofftankstelle sein.
Sowohl das Stadtwerk Haßfurt als auch das Erlanger Unternehmen sehen in Wasserstoff als Energiespeicher die Zukunft in der Energiewende. Das Stadtwerk hat das Ziel klar definiert: null Emissionen in allen Sektoren. Nicht nur in kommunalen Vorzeigeprojekten, sondern in ganz Deutschland. Norbert Zösch fordert deshalb, die die Dominanz der "Etablierten" des Energiesektors zu durchbrechen – „und dann den Wasserstoff an die Position bringen, wo er hingehört“.
Pilze als Wasserfilter
Biofilter gegen ChemierestePilze zersetzen Medikamentenrückstände im Abwasservon Manuel Fröhlich
Neben Arzneimitteln, die rund ein Fünftel der Xenobiotika ausmachen, fallen darunter insbesondere bestimmte Industrie- und Agrarchemikalien. Thomas Ternes, Leiter der Abteilung Qualitative Gewässerkunde der Bundesanstalt für Gewässerkunde, schätzt die Menge der Substanzen auf rund 300.000 Tonnen pro Jahr. Problematisch ist, dass das dreistufige Filtersystem konventioneller Kläranlagen es nicht schafft, die Xenobiotika vollständig aus dem Wasser zu entfernen. Da 97 Prozent des Abwassers durch solche Kläranlagen gereinigt werden, verbleibt der Großteil der Stoffe im Wasser.
Ökosysteme leiden
Pilzenzyme zersetzen die Rückstände
© Anett Werner
Ozonierung und Aktivkohle sind praxiserprobte Alternativen
Werner sieht die beiden Verfahren vor allem aus Umweltaspekten teilweise kritisch: „Die Herstellung von Aktivkohle hat durch das anfallende CO2 eine sehr schlechte Ökobilanz.“ Bei der Ozonierung dürfe zusätzlich die Gefahr, dass krebserregende Stoffe entstehen können, nicht vernachlässigt werden. Der biologische Pilzfilter sei dagegen nachhaltig und die Enzyme würden ohne Zutun komplett abgebaut. Laut Werner ist eine Kombination aus allen drei Ansätzen am vielversprechendsten.
Gib der Natur nicht den Rest
Eine gesetzliche Grundlage für die Nachrüstung der Kläranlagen, wie sie das UBA fordert, gibt es bisher nicht. Mit dem Spurenstoffdialog hat das Bundesministerium für Gesundheit aber einen Austausch mit den Beteiligten ins Leben gerufen, um Lösungen zu erarbeiten. Außerdem läuft unter dem Titel „Gib der Natur nicht den Rest!“ seit Anfang des Jahres eine Kampagne, um auf die falsche Entsorgung von Medikamentenresten aufmerksam zu machen.
Xenobiotika im Abwasser stellen jedoch keine Gefahr für den Menschen dar, sagt Werner:
Nachhaltige Batterien
Mit nachhaltigen Batterien eine klimafreundliche Mobilität schaffenVon Felix Spies
Foto: TWAICE
Die gesamte Wertschöpfungskette im Blick behalten
Foto: TWAICE
Gebrauchte Batterien können wiederverwendet werden
Foto: TWAICE
Es gibt Alternativen zu Lithium-Ionen-Batterien
EU-KommissionBatterien sollen klimafreundlicher werden
Bioherbizide
Unkraut nachhaltig bekämpfenWie Minze herkömmliche Herbizide ergänzen könnte Von Antonia Röper
Konventionelle Herbizide belasten das Ökosystem
Doch sie könnten eine Lösung sein, sollten sie spezifisch auf eine Unkrautart wirken, ohne die Pflanzenvielfalt und Bodengesundheit zu gefährden.Der Molekularbiologe Peter Nick und sein Team arbeiten am Botanischen Institut des Karlsruher Instituts für Technologie (KIT) daran, ein solches Bioherbizid entwickeln.
Minze als Bioherbizid
In Zellkulturen erkannten die Forscher, dass die im ätherischen Öl der Minze vorhandene Verbindung Menthon dafür sorgt, dass sich in der Nachbarpflanze die Mikrotubuli – ein Teil des Zellskeletts – sehr schnell auflösen. Dadurch bringen sich die Zellen um und die Pflanze stirbt. Diese chemische Kriegsführung unter Pflanzen nennt man auch Allelopathie. Laut Nick lässt sich Menthon besonders gut gegen das Unkraut Ampfer einsetzen. Im Interview erklärt der Molekularbiologe, wie das Menthon auf den Acker gebracht werden könnte.
Bioherbizide stehen noch vor einigen Herausforderungen
Kosten stellen eine weitere Herausforderung dar. In die Forschung muss laut Nick mehr Geld fließen, damit aus Projekten wie seinem überhaupt ein Bioherbizid produziert werden kann. Zusätzlich müssen die Kosten für die landwirtschaftlichen Betriebe stimmen, damit diese wettbewerbsfähig bleiben können. Bioherbizide dürfen in der Praxis nicht zu teuer werden.
Landwirte freuen sich über neue Wirkstoffe
Auch bei Bioherbiziden stellt sich die Frage, ob Unkräuter auf Dauer resistent dagegen werden. Im Interview erklärt Nick vom KIT, wieso dies nicht der Fall sein wird.
Positive Zukunftsaussichten für den Markt der Bioherbizide
Mehr Zeit, Geld und Forschung sind nötig
Abwasser Recycling
Wie die Kläranlage zum Nährstoffcenter wirdVon Stefan Guggenberger
Menschen, Landwirtschaft, Industrie – sie alle brauchen Wasser
Bisher setzten Landwirte in Deutschland auf Regen. Nur etwa zwei Prozent der Agrarflächen werden künstlich bewässert und das geschieht in der Regel durch die Entnahme von Grund- oder Flusswasser. Verstetigt sich die Tendenz der geringeren Niederschläge und der steigenden Temperaturen, müssen Landwirte jedoch zunehmend das schwindende Grundwasser nutzen. Für die Zukunft bedeutet das, dass öffentliche Wasserversorgung, Landwirtschaft und Industrie bei der Frischwassernutzung konkurrieren.
Wasserstress durch cleveres Recycling vermeiden
Foto: ISOE (Institut für sozial-ökologische Forschung)
Das Gewächshaus wandert neben die Kläranlage
Foto: ISOE (Institut für sozial-ökologische Forschung)
Jetzt: Tomaten statt SalatDie Marktreife soll erprobt werden
Hypowave+ wird einen größeren Maßstab haben als die Pilotanlage in Hattorf. Denn die dort angebauten Tomaten sollen in ortsansässigen Supermärkten vertrieben werden. Damit sich das Projekt wirtschaftlich lohne, müsse die Anbaufläche mindestens einen Hektar groß sein, sagt Winker. Die neue Anlage wird in der Nähe von Gifhorn, etwa 20 Kilometer von Wolfsburg entfernt, entstehen. Dort sind die Böden eher sandig und Regenwasser versickert zu schnell. Dabei bleibt das Projekt gezielt im periurbanen Raum, wo Stadt und Land aufeinandertreffen. Hier können Landwirte von dem Anbaukonzept mit geschlossenen Nährstoff- und Wasserkreisläufen profitieren und es gibt einen Absatzmarkt für die erzeugten Lebensmittel. „Für uns ist es jetzt wichtig, in der passenden Nische die Marktreife zu erproben“, meint Winker weiter.
Foto: ISOE (Institut für sozial-ökologische Forschung)
Projekt SuskultStädte als Orte der Lebensmittelerzeugung
„In urbanen Räumen gibt es heute schon Impulse aus der Gesellschaft, Städte als Orte der Lebensmittelerzeugung zu erschließen“, ergänzt Schwindenhammer. Das fange bei Stadtbienen an, gehe über Urban-Gardening und münde darin, dass die Kläranlage zum Nährstoffcenter für die Bevölkerung werde.
Innovation muss von der Gesellschaft getragen werden
Nachhaltige Kleidung
Der Bioökonomie neue Kleider

Auf Kriegsfuß mit dem Wegwerfen Sharing Economy in der Textilbranchevon Sarah Wagner
Ein kurzes Gedankenspiel: Angenommen Studentin Bea guckt morgens in ihren Kleiderschrank und weiß vor lauter Teilen gar nicht, was sie am liebsten tragen würde. Vielleicht das Schnäppchen von vor zwei Wochen? Oder das Oberteil, das sie erst einmal getragen hat? Wobei, das hat schon jetzt sichtbare Gebrauchsspuren.
Unser Gedankenspiel ist gar nicht weit hergeholt. Denn jeder Deutsche kauft, nach Angaben der Greenpeace-Studie „Wegwerfware Kleidung“, durchschnittlich fünf neue Kleidungsstücke pro Monat, trägt aber 40 Prozent der Kleidung, die bei ihm im Schrank hängen, selten oder nie. Die Bekleidungsindustrie plant, ihre Produktion bis 2030 mehr als zu verdoppeln. Das heißt, dass die gesamte Bevölkerung dann jährlich 102 Millionen Tonnen Kleidungsstücke verbrauchen wird.
Kleider-Sharing
Sharing Economy
Richtig umgesetzt, hilft Sharing Economy, bestehende Kapazitäten besser zu nutzen, senkt den Ressourcenverbrauch und sorgt – aufs Beispiel der Kleidung übertragen – zu einer gesellschaftlichen Verbindung zwischen den Teilenden. Die Kleiderei ist laut Schröder nicht nur ein Laden, „sondern auch ein Ort, an dem sich ausgetauscht wird und man ganz viel lernt.“ Zum Beispiel, sein Bewusstsein vom Kleiderkonsum zu verändern.
Quelle Bild: Mona Schulzek für Kleiderei
Herausforderung: Umdenken
Deutlich nachhaltiger als der Konsum herkömmlicher Textilien ist der von ‘grüner Mode‘. Darunter fällt zum Beispiel nachhaltig produzierte Mode aus ressourcenschonenden Materialien oder auch Mode, die unter Aspekten der Kreislaufwirtschaft produziert wurde. Das bedeutet dass alles, was für das Produkt verwendet wird, am Ende wiederverwendet wird oder andernfalls komplett biologisch abbaubar ist. Abfall wird minimiert und der Lebenszyklus der Produkte verlängert.
Damit ist die Kreislaufwirtschaft das Gegenteil des linearen Wirtschaftsmodells, der ‚Wegwerfwirtschaft‘. Start-Ups wie circular.fashion oder die baden-württembergische Marke Trigema arbeiten bereits an Umsetzungsmöglichkeiten. Dazu brachte Trigema die „Change-Kollektion“ auf den Markt. Eine der ersten voll kompostierbaren Kollektionen aus Biobaumwolle, die auch mit dem Textil-Ökosiegel Cradle to Cradle zertifiziert ist.
Eine utopische Vorstellung
Textil-Ökosiegel
Und jetzt?
Schattenseite von Sharing Economy
Dennoch sei die Sharing Economy, "wenn man die Kreislaufwirtschaft ernst nimmt", ein großer Teil davon, so Zahn. Seiner Meinung nach können das Teilprinzip Sharing Economy und die steigende Produktion nach Aspekten der Kreislaufwirtschaft zur Reduzierung von Abfall co-existieren.
Nachhaltige TextilienEine Frage des Geldes
„Meist wird in Dinge investiert, die sicher sind. Und sicher sind nun mal die bestehenden Strukturen, nicht zwangsläufig die Neuen“, meint Zahn. Der Verbraucher sei oft nicht bereit, in das Bessere zu investieren. Es sei schwierig, auch unteren Einkommensschichten klar zu machen, dass sie eigentlich weniger kaufen und dann pro Produkt auch noch mehr zahlen sollen.
Green Fashion
Fair-FashionWenn aus Müll Mode wird von Carolin Blatzheim
Seit 2017 produziert das Kölner Startup-Unternehmen Airpaq hochwertige Rucksäcke. Der Clou: Sie bestehen zu 100 Prozent aus alten Auto-Airbags. „Unsere Vision ist es, eine nachhaltige Alternative zu konventionellen Produkten zu schaffen“, beschreiben die beiden Unternehmensgründer Adrian Goosses und Michael Widmann die Philosophie ihres Unternehmens.
Dafür benutzen sie das Konzept des ‘Upcyclings‘. Upcycling ist eine besondere Form des Recyclings, bei der aus gebrauchten oder kaputten Gegenständen ein neues, hochwertiges Produkt geschaffen wird. Was sonst seinen Weg in die Verbrennungsanlage findet, wird so beispielsweise wieder zu einem Alltagsgegenstand. Ein Prozess, bei dem durch gezielte Wiederverwertung von Materialen auch die Verschwendung von Rohstoffen verhindert wird.
Foto: Martin Steinbach / Airpaq
Sind Upcycling-Produkte nachhaltig?
Ein Beispiel hierfür ist die Autoverwertung. Laut Umweltbundesamt finden rund eine halbe Millionen Pkws jährlich ihren Weg zur Autoverwertung. Einige der im Auto verbauten Rohstoffe lassen sich wiederverwerten. Dazu gehören vor allem Eisenmetalle, Aluminium und Buntmetalle wie Kupfer, Cadmium oder Nickel. Alte und kaputte Airbags hingegen können in der Autoindustrie aufgrund des enthaltenen Sprengstoffs nicht weiterverwertet werden. Sie müssen unter strengen Regulierungen fachgerecht gezündet und zusätzlich aufwendig gesäubert werden, da die enthaltenen Materialen eine Gefahr für die Umwelt darstellen.


Airpaq legt großen Wert auf nachhaltiges Handeln in allen Prozessschritten. Die Rucksäcke werden in Rumänien unter strengen EU-Umweltschutzstandards produziert. Eine Produktion außerhalb Europas stand nicht zur Debatte: „Fair-Fashion und Nachhaltigkeit gehen für mich Hand in Hand. Ich kann kein nachhaltiges Business führen und dann sagen, mich interessiert nicht, wo die Dinge herkommen“, so Goosses. Zudem habe die Nähe zu Deutschland den Vorteil, die Produktion persönlich begleiten zu können.

Gegen Green Washing vorgehenErfolg durch Transparenz
Denn seit die Nachhaltigkeit in der Modebranche einen immer höheren Stellenwert erlangt, missbrauchen Unternehmen den nachhaltigen Modegedanken zu ihren persönlichen Marketingzwecken. Dieses Phänomen nennt man „Green Washing“. Darunter fallen Kampagnen und PR-Aktionen, in denen Firmen sich der Öffentlichkeit mit einem „grünen Image“ präsentieren und dem Kunden ihre Produkte als „ökologisch wertvoll“ verkaufen, obwohl dies nicht den Tatsachen entspricht.
Konkurrenz im Nischenmarkt
Als größere Konkurrenz sehe der junge Unternehmer konventionelle Fashion-Unternehmen: „Wenn ich es mit meinem Produkt schaffe, jemanden zu überzeugen, der sonst ein konventionelles Produkt aus schlechter Herstellung kauft, dann habe ich etwas erreicht.“ Das funktioniere mit den Airbags ganz gut, da das Material Rucksack-Stoffen ähnele. „Unsere Kunden müssen keine riesigen Upcycling-Fans sein, um die Produkte zu kaufen. Dadurch heben wir uns in der Branche auch ein bisschen ab. Ein ganz konventioneller Kunde kann unsere Produkte cool und praktisch finden“, erklärt Goosses. Dennoch ist die Fair-Fashion-Branche immer noch ein Nischenmarkt und die Preise für nachhaltige Produkte, verglichen mit konventionellen Produkten, sind hoch. Denn eine nachhaltige Produktion ist mit Kosten verbunden. Während ein konventionell hergestellter Rucksack mit 35 Liter Volumen zwischen 70 und 115 Euro kostet, liegt ein vergleichbarer Rucksack von Airpaq bei 219 Euro.
Auf dem Foto: Airpaq UG
Zukunft in der Fair-Fashion-Branche
Doch erst 2018 ergab eine Studie des Marktforschungsinstituts Appinio, dass sich nur 23 Prozent der Befragten zwischen 14 und 34 Jahren vorstellen könnten, in Zukunft nachhaltige Mode zu kaufen, weitere 38 Prozent könnten sich das tendenziell vorstellen. Wann dies der Fall ist und wie eine nachhaltige Modebranche aussieht, darüber lässt sich nur spekulieren. Dass Upcycling und Recycling in Zukunft weiterhin wichtig sein werden, davon ist Adrian Goosses überzeugt.
Secondhand
Zwischen Vintage und WegwerfgesellschaftVon Lara Schmottlach
Die alte Jeans von Mama wird herausgekramt und bei Bedarf etwas umgenäht. Papas Lederjacke ist zwar etwas zu groß, aber das ist schließlich wieder im Trend. Noch schnell eine Bluse von Oma übergeworfen, die älter ist als man selbst, und das Outfit steht. Wer auf den Straßen Kölns unterwegs ist, dem fällt auf, dass immer mehr Jugendliche und Erwachsene Leder- oder Jeansjacken im Oversize-Look, Mom-Jeans, Cordhosen und andere Vintage- und Secondhand-Fundstücke tragen. Rumzulaufen wie die Eltern oder Großeltern scheint wieder im Trend zu sein. Wer solche Kleidungsstücke nicht zu Hause hat, der bekommt sie in Secondhand-Stores.
Jeder Secondhand-Kauf unterstützt Slow Fashion
Fast fünf Kilo Bekleidungsmüll im Jahr – pro Einwohner
Umweltfreundlich und günstig, aber auch mal muffig und von minderer Qualität
Die 20-jährige Carolin, Journalistik-Studentin aus Bonn, kauft Secondhand. Sie sitzt an ihrem Schreibtisch und lächelt in die Laptop-Kamera. „Der Umweltaspekt bei Secondhand-Kleidung ist nicht mein Hauptgrund für den Kauf, aber ein positiver Nebenaspekt. Die Kleidung ist meist deutlich günstiger und in gut erhaltenem Zustand. Wenn mir etwas gefällt, darf es gerne auch Secondhand sein“, erzählt sie per Videocall. Wie bei allem gibt es aber auch hier ein paar negative Aspekte. Für Carolin fällt die Qualität darunter: „Manche der Sachen sind nicht so langlebig – dadurch, dass sie schon getragen wurden.“ Wer selbst öfters in Secondhand-Läden unterwegs ist, weiß außerdem, dass die Kleidung dort manchmal muffig riecht. Das liegt daran, dass sie älter ist – so gesehen kann man den Geruch auch authentisch finden. Den „Muff“ können Kunden mit einem Waschgang zu Hause problemlos beseitigen.
Secondhand-Shopping in der Pandemie
“Secondhand ist zu einem Spaßtrend geworden“
Deutlicher Zuwachs auf Secondhand-Plattformen
Kaufverhalten beeinflusst weitere Entwicklung
Nachhaltige Denimproduktion
Lieblingskleidungsstück Jeans: Wirklich untragbar?Von R. Bagheri
Stellen wir uns vor, eine 19-jährige Studentin, nennen wir sie Elena, ist mit ihren Freundinnen in der Stadt auf der Suche nach einer neuen Jeanshose. Denn alle, die sie im Kleiderschrank hat, sind ihr nicht mehr stylisch genug. Sie passen zwar noch, aber Elena zieht sie einfach nicht mehr gerne an. So wächst der Jeansstapel in ihrem Kleiderschrank. Durch die Vorliebe vieler Menschen für bequeme Jeanshosen in jedweder Form und Farbe wächst so oder so ähnlich auch der Stapel im Kleiderschrank vieler anderer Menschen in Deutschland.
Schmutzigstes Kleidungsstück der Welt
Verminderte Lebenserwartung bei Arbeitern in Denimproduktion
Die Jeansherstellung birgt nicht nur Gefahren für die Umwelt, sondern auch für die Träger und insbesondere die Arbeiter der Jeansbranche, denn die häufig verwendeten Bleichmittel Chlor und Kaliumpermanganat sind hochgiftig. Dem internationalen Verband der Naturtextilwirtschaft (IVN) zufolge beträgt die durchschnittliche Lebensdauer eines Fabrikarbeiters, der die giftigen Gase ein bis zwei Jahre lang einatmet, lediglich zehn weitere Jahre. Nur selten wissen die Beschäftigten in der Jeansbranche aber, wie gefährlich der Job für ihre Gesundheit ist. Eine durch die Arbeit verringerte Lebenserwartung ist vor allem bei Arbeitern in der Produktion von extrem niedrigpreisiger Jeansware gegeben, wie man sie beispielsweise bei Billigmode-Ketten findet. Käuferinnen wie Studentin Elena sind oft nicht über diese Gesundheitsgefährdung informiert.
Verzicht auf Jeans nicht die einzige Lösung
Veränderungswille in Modebranche fragwürdig
Neben vielen schwarzen Schafen gibt es aber auch Unternehmen, denen gute Produktionsbedingungen am Herzen liegen: Eins davon ist Armedangels. Das Kölner Unternehmen ist eines der größten Eco- und Fair Fashion-Labels Europas und hat bereits zwei sogenannte „Detox Denim”-Kollektionen herausgebracht. Für diese Jeans-Linie wurde ausschließlich zertifizierte Bio-Baumwolle verwendet, die beim Anbau mit 40 Prozent weniger Wasser und über 60 Prozent weniger CO² als gewöhnliche Baumwolle auskommt. Für die Färbung arbeitete Armedangels mit GOTS-zertifizierten Partnern zusammen, die ebenfalls auf den Wasserverbrauch achten und nur mit unbedenklichen Chemikalien arbeiten. Außerdem wurden beim Finishing und Bleaching der Hosen die modernen Laser- und Ozontechniken eingesetzt. Können bei solchen alternativen Verfahren zur Denim-Herstellung neben all den Vorteilen auch Nachteile auftreten? Nicht unbedingt Nachteile, aber Veränderungen zu dem, was man von der klassischen Jeans kennt, erläutert Capitao: „Die Produkte könnten anders altern und sich im Waschprozess ganz anders hinsichtlich der Optik und des Tragegefühls verhalten. Dann ist man vielleicht entweder gezwungen nach Alternativen zu suchen, oder der Konsument gewöhnt sich an dieses neue Produkt. Möglicherweise gefällt es ihm oder ihr sogar besser.”
Alternativen mit natürlichem Farbstoff
Natürlicher Indigo hat einen klaren Vorteil, denn in dem künstlich erzeugten Farbstoff, der meist zum Einsatz kommt, ist Anilin enthalten. Diese Chemikalie steht im Verdacht, krebserregend zu sein. Der Einsatz von Anilin brachte das Verbrauchermagazin Ökotest 2019 dazu, im „Ökotest Jeans“ sowohl das getestete Model von Hess Natur als auch von Armedangels unterm Strich nur mit „befriedigend” zu bewerten. Beide lagen dabei aber immer noch weit unter den von GOTS festgeschriebenen Grenzwerten.
Secondhand, lokale Produktion, veganer Denim
Rohstoffe konkurrieren mit Lebensmittelproduktion
Armedangels & Co. dürften nur der Anfang sein
Studentin Elena könnte dann zwischen einer Vielzahl an Marken eine nachhaltigere Jeans auswählen. Bis dahin und mit Blick auf den Geldbeutel könnte es auf der aktuellen Shopping-Tour eher eine Secondhand-Jeans werden. Der Vintagelook ist so gut wie garantiert.
ERZEUGEN
BIOMASSE ERZEUGENDie Rohstoffe der Zukunft
Bienensterben
ArtensterbenRettet die Bienen von Fabia Junker, Leonie Kahn und Pascal Stephan
Immer mehr Tier- und Pflanzenarten sind vom Aussterben bedroht oder bereits komplett verschwunden. So zeigte die „Rote Liste der Pflanzen“ des Bundesamts für Naturschutz Ende 2018, dass in Deutschland über 2500 heimische Pflanzenarten in ihrem Bestand gefährdet sind. Das entspricht mehr als einem Drittel der gesamten heimischen Wildpflanzen. Unter der schrumpfenden Vielfalt im Pflanzenreich leidet auch die Biene – vor allem in Bayern: 40 der ursprünglich 520 heimischen Bienenarten sind laut dem Bund Naturschutz bereits verschwunden. Deutschlandweit ist über die Hälfte aller Bienenarten bedroht.
Das Aktionsbündnis „Rettet die Bienen“ möchte diese dramatische Entwicklung stoppen und erwirkte im Juli 2019 mit dem Volksbegehren "Artenvielfalt" Gesetzesänderungen im bayerischen Naturschutzgesetz. Das Ziel: die Artenvielfalt retten, die Lebensräume der Tiere vernetzen und ungenutzte Wiesen in Blühwiesen umwandeln.
Der Wert der Bienen für die MenschheitÜberlebenswichtige Bestäuber
Nicht nur Honig gilt als beliebtes Bienenprodukt, auch vom Wachs, Harz und von den Bienenpollen profitiert unser Alltag: So wird Bienenwachs zum Beispiel als Inhaltsstoff für Cremes oder Salben in der Kosmetik- oder Pharmaindustrie eingesetzt. Die von Bienen gesammelten Pollen sind reich an Vitaminen, Mineralien und Proteinen. Als Nahrungsergänzungsmittel stärken sie das Immunsystem und verbessern die Leistungsfähigkeit des menschlichen Gehirns. Bienenharz, auch Propolis genannt, gilt als natürliches Antibiotikum. Das wohl kostbarste Produkt ist das sogenannte Gelée Royale, ein von Arbeitsbienen erzeugtes Sekret, mit dem die Bienenkönigin gefüttert wird. Es wird in der Kosmetikindustrie sowie im medizinischen Bereich eingesetzt.
Der Tierökologe Dr. Peter Biedermann macht deutlich, dass die Bienen auch für unsere Ernährung essentiell sind:
Ohne Bienen keine PflanzenvielfaltWichtig fürs Ökosystem
Bienensterben in Europa
Die Hälfte aller europäischen Bienenvölker sind in den vergangenen Wintern gestorben.
Vielfalt der Bienen
Es gibt 30.000 verschiedene Bienenarten.
Schwund von Lebensmitteln
Zwei Drittel unserer Nahrung würden ohne die Bienen nicht existieren.
Wirschaftlicher Wert
Der wirtschaftliche Wert der Bestäubung beträgt circa 250 Milliarden Euro.
Bienen als Bestäuber
70 Prozent der weltweiten Nutzpflanzen werden von der Biene bestäubt.
Manuelle Bestäubung
In manchen Regionen Chinas sind die Bienen bereits vollkommen ausgestorben. Dort müssen Menschen die Blüten per Hand bestäuben.
Ursachen für das BienensterbenVier schwerwiegende Gründe
Doch nicht nur die Bewirtschaftung von Acker- und Grünflächen, auch die Urbanisierung macht den Bestäubern zu schaffen: In dicht bebauten Gebieten finden die Bienen kaum blütenreiche Nahrungsquellen. Ihr Lebensraum verschwindet. Zuletzt tragen auch Umweltveränderungen wie der Klimawandel und die zunehmende Luftverschmutzung zum Bienensterben bei.
Jeder Einzelne ist gefragt
Wie eine bienenfreundliche Umgebung aussieht, kann man am Biozentrum der Universität Würzburg beobachten:
VolksbegehrenBürger wollen Bienen schützen
Dank 1,8 Millionen Bürgern hat das Land Bayern seit August 2019 ein verbessertes Naturschutzgesetz. Es gilt nun sogar ein Pestizidverbot auf allen staatlichen Flächen. Das Volksbegehren Artenvielfalt „Rettet die Bienen!“ wurde samt Begleitgesetz und umfassendem Maßnahmenpaket im Landtag verabschiedet: „Der 17. Juli 2019 wird als wichtiger Tag für den Naturschutz in die bayerische Geschichte eingehen“, freut sich Agnes Becker, Beauftragte des Volksbegehrens und stellvertretende ÖDP-Landesvorsitzende.
Der Kreissprecher des Aktionsbündnisses, Matthias Henneberger, sieht in der Bürgerbewegung aber nicht nur einen Erfolg für Bayern:
Pflanzenzüchtung / Klima
Forscher machen Pflanzen fit für den KlimawandelDie Anpassungsfähigsten überlebenvon Anna-Lena Gröh
Foto: Tom Freudenberg / pict-images
Ältere Landrassen gegen Staunässe und Kälte
Foto: Tom Freudenberg / pict-images
Sorten mit hoher Kältetoleranz
Foto: Tom Freudenberg / pict-images
Genschere zugunsten der Hitzetoleranz
Foto: Tom Freudenberg / pict-images
GenomeditierungWas passiert, wenn ich das Gen auschalte
Foto: Tom Freudenberg / pict-images
GentechnikMethoden noch nicht erlaubt
Foto: Tom Freudenberg / pict-images
Foto: Tom Freudenberg / pict-images
Foto: Tom Freudenberg / pict-images
Pilze und Pflanzen arbeiten Hand in Hand
Foto: Tom Freudenberg / pict-images
Foto: Tom Freudenberg / pict-images
Emissionsarme Landwirtschaft
Ammoniak-Emissionen reduzierenKlimafreundliche Landwirtschaftvon Caspar Bickert, Marc Fischäß und Felix Scheuerlein
Nach Zahlen des Thünen-Instituts emittierte die deutsche Landwirtschaft allein im Jahr 2018 rund 607.000 Tonnen des umweltschädlichen Gases NH3. Verschiedene Techniken und Methoden sollen die Emissionen in den kommenden Jahren deutlich reduzieren. Vor allem kleinere Betriebe stellt das in der Praxis jedoch vor eine Herausforderung.
Vom Feld in die Atmosphäre
Die wichtigste Quelle für Ammoniakemissionen in der Landwirtschaft ist die Wirtschaftsdüngerkette. Sie beginnt im Stall und endet damit, dass der Dünger auf dem Feld ausgebracht wird. Das Problem: Nutztiere scheiden mit Kot und Harn auch Stickstoff aus. Durch natürliche Umsetzungsprozesse entweicht so auch Ammoniak in die Luft.
Dr. Michael Diepolder von der Bayerischen Landesanstalt für Landwirtschaft beschreibt diese Ammoniak-Emissionen als „Vorstufe zur Feinstaubbelastung“ und schildert den genauen Vorgang:
Neue Technik zur GülleverteilungTeure Lösung
Mit optimierten Ausbringungsverfahren können die in der Gülle enthaltenen Nährstoffe effizienter in den Boden eingebracht werden. Das sei laut Diepolder nicht nur für das Ökosystem, sondern auch für die Bauern von Vorteil. Jedoch stellt die Umstellung auf eine emissionsärmere Technik kleinere Betriebe vor Herausforderungen – sie ist nicht nur technisch anspruchsvoll, sondern auch teuer. „Auf einmal sind für viele kleine Betriebe neue Kostenpositionen da, die sie so gar nicht kannten“, erklärt Landwirt Peter Seeger vom Hof Seeger im hessischen Otzberg. Der Staat müsse hier investieren, um Innovationen in der konventionellen Landwirtschaft voranzutreiben:
Politische AuflagenWohin mit der Gülle?
Auch das Vorhaben, neue Lagerkapazitäten für die Überschüsse zu schaffen, birgt große Hürden. Dr. Klaus Erdle, Leiter des Internationalen Pflanzenbauzentrums bei der Deutschen Landwirtschafts-Gesellschaft, erklärt warum:
Kooperation in der LandwirtschaftLandwirte tun sich zusammen
Auch wenn es also schon verschiedenste Ansätze gibt, mit denen die Ammoniak-Emissionen in der Landwirtschaft reduziert werden könnten – in der Praxis zeigt sich an vielen Stellen Potenzial zur Verbesserung.
Können die Corona-Maßnahmen das Klima retten?Von Krise zu Krisevon Sofie Reichel
Samstagvormittag in der Kölner Innenstadt. Es scheint, als wäre es ein normaler Tag. Die Stadt sprudelt nur so vor Leben, vor den Geschäften stehen die Menschen Schlange. Die Straßen füllen sich mit Autos, als wären die letzten Wochen nur ein Traum gewesen. Doch trotz Rückkehr zum Alltag ist die Corona-Krise noch präsent. In den letzten Monaten hat sie nahezu alle weiteren Themen in den Hintergrund gedrängt – auch den Umweltschutz. Doch das macht ihn nicht weniger dringend, denn der Klimawandel schreitet stetig voran. Es bleibt die Frage: Ist Klimaschutz in Zeiten der Pandemie überhaupt noch wichtig?
Wirtschaft im Wandel
Doch die Umweltverbände wollen mehr. Benedikt Jacobs, Experte im Bereich der Rohstoff- und Ressourcenpolitik beim Bund für Umwelt und Naturschutz Deutschland (BUND), erhofft sich einen systemischen Wandel der Wirtschaft. Damit der Klimaschutz an Priorität gewinnen kann.
Langfristige Veränderungen
Für den Energie- und Klimaforscher ist es zwar wichtig, dass man sich zunächst primär um die Gesundheit der Menschen kümmert und das Gesundheitssystem entlastet. Dennoch sollte seiner Meinung nach die Klimakrise dabei nicht in Vergessenheit geraten. Laut Fischedick muss sich die Gesellschaft auf Veränderungen vorbereiten und langfriste Maßnahmen treffen, um die Folgen des Klimawandels in Grenzen zu halten.
Sinkende Treibhausgasemissionen
Bestes Beispiel dafür: 2009 steckte die Welt in der Wirtschaftskrise – für das Klima ein prägendes Ereignis. Denn zwischen den Jahren 2008 und 2009 sank der Gesamtausstoß aller Treibhausgase um 8,4 Prozent. Jedoch zeigte sich schnell, dass die weiteren Beschlüsse in Folge der Krise diesen Erfolg in den darauffolgenden Jahren wieder zunichtemachten. So gab es 2010 in Deutschland laut Umweltbundesamt einen CO2-Anstieg um 35 Millionen Tonnen. Weltweit stiegen die CO2-Belastungen 2010 um sechs Prozent, in 2011 um weitere drei Prozent an.
Aus Krisen lernen
Er findet, dass die aktuellen Debatten die Wirtschaft weder resilienter noch klimafreundlicher oder regionaler machen. Seiner Meinung nach bietet die Krise jedoch eine Chance: „Wenn jetzt schon einmal alles ‘runtergefahren‘ ist, sollten wir auch in die richtige Richtung neustarten und uns nicht den rückwärtsgewandten Sachen zuwenden“, so Jacobs.
Politische Bemühungen
Viele Maßnahmen, die Institutionen und Umweltverbände vorgeschlagen haben, wurden in das Ergebnis des Koalitionsausschusses miteinbezogen. Laut Fischedick ein mutiger Schritt in die richtige Richtung. Doch: „Die Corona-Krise kam plötzlich und unerwartet. Vom Klimawandel wissen wir dagegen ganz genau, dass er stetig fortschreitet und dauerhafte Folgen hat, wenn wir jetzt nicht massiv gegensteuern. Es wäre fahrlässig, nicht jede Chance zu nutzen, einen möglichst hohen Beitrag zum Gegensteuern zu leisten."
Neue Rohstoffe für die BioökonomieAlternative Kulturpflanzenvon Jakob Holzhacker, Katrin Kölle und Monika Subataviciute
Während Mais laut dem Bundesverband Deutscher Pflanzenzüchter bereits seit den Sechzigerjahren angebaut wird, erfreut sich die alternative Kulturpflanze Durchwachsene Silphie erst seit 2009 wachsender Berühmtheit. Das zeigen Untersuchungen der Thüringer Landesanstalt für Landwirtschaft. Die Durchwachsene Silphie gilt als vielversprechender Lebensraum für Insekten, da sie den ganzen Sommer über bis hin zur Ernte blüht.
Auch das Technologie- und Förderzentrum im Kompetenzzentrum für Nachwachsende Rohstoffe (TFZ) erforscht alternative Kulturpflanzen. Michael Grieb ist dort stellvertretender Leiter des Sachgebiets ‚Rohstoffpflanzen und Stoffflüsse‘ und bestätigt, dass alternative Kulturen auch der Artenvielfalt zugutekommen könnten:
Pioniere der Vielfalt
Vom Erbsenprotein bis zur HanfkleidungAlternative Alleskönner
Laut Michael Grieb vom TFZ in Straubing sei auch der Hanf nicht zu unterschätzen. Die Pflanze lasse sich vielfältig und nahezu vollständig verwerten: So könnten die Hanfkörner in der Lebensmittelproduktion, Blüten und Blätter im Arzneimittelbereich eingesetzt werden. Aus den Stängeln lassen sich Fasern für die Textilindustrie herstellen, so Grieb.
Der Mais bekommt KonkurrenzAlternative Kulturen als Energielieferanten
Die Durchwachsene Silphie sei bei der Biogasherstellung durchaus eine Konkurrenz für herkömmlichen Kulturen wie den Mais, erläutert Michael Grieb. Die Pflanzenart aus Nordamerika könne nach einmaliger Aussaat bis zu 15 Jahre lang kontinuierlich Erträge liefern. Beim Mais hingegen handele es sich um eine einjährige Kultur. Das bedeute, dass er jährlich neu gesät werden müsse. Auch der Boden müsse dadurch jedes Jahr bearbeitet werden.
Kulturpflanzen und KlimaDer richtige Standort
Gefahren erkennen und kontrollierenNeue Pflanzen, neue Schädlinge?
Um dem entgegenzuwirken, werden bereits vor dem Anbau der neuen Kulturen umfangreiche Tests auf kontrollierten Flächen durchgeführt, so Grieb. Auch Blessing erklärt, dass bei neuen Pflanzenarten über ein Gesundheitszeugnis sichergestellt werde, dass mit der neuen Kultur keine Krankheiten oder Schädlinge mitgebracht werden. „Man kann nicht einfach so Saatgut von irgendwoher nach Deutschland bringen“, so Blessing.
Investition ins Grüne
Grieb sieht ein lokales Marktgleichgewicht als Grundvoraussetzung für den wirtschaftlich rentablen Anbau alternativer Kulturen. Außerdem verweist er auf Subventionsprogramme wie die sogenannte Greeningprämie: Hierbei handelt es sich um eine EU-Förderung für Landwirte, die bestimmte Umweltauflagen erfüllen. Auch der Einsatz alternativer Kulturen zählt zu diesen Vorgaben. In Bayern gibt es außerdem das sogenannte Kulturlandschaftsprogramm. Dieses stellt Förderungen für Projekte bereit, die sich besonders positiv auf die Artenvielfalt auswirken.
Das Aus für die konventionelle Landwirtschaft bedeuten die alternativen Kulturen jedoch nicht, wie Grieb deutlich macht:
Pflanzen als Klimaretter
Mit optimiertem Stoffwechsel zur KlimaneutralitätPflanzen als Klimarettervon Miriam Schönwerth
Mit Geoengineering zur Klimaneutralität
Ein Ansatz besteht deshalb darin, vermehrt CO2 aus der Atmosphäre zu entfernen, und somit rechnerisch negative Emissionen zu erzeugen. Diese Idee, genannt Carbon Dioxide Removal, fällt unter den Bereich des Geoengineering – also bewusste Eingriffe in das Klimasystem, um die menschgemachte Klimaerwärmung abzumildern.
PflanzenkraftNatürliche CO2-Verarbeitung
Trotzdem birgt die Photosynthese von Pflanzen Potenzial für eine gesteigerte Speicherung von CO2. Deshalb wird daran geforscht, wie sich dieses Potenzial besser nutzen lässt. Denn die Photosynthese verläuft teilweise ineffizient. Die Photorespiration, also die Atmung der Pflanzen, durch die gleichzeitig CO2 freigesetzt wird, hat negative Auswirkungen auf die gesamte Bilanz der Photosynthese. Dies geschieht, da das Enzym RuBisCo (Ribulose-1,5-bisphosphat-carboxylase/-oxygenase) nicht nur CO2 fixiert, sondern zu einem gewissen Grad auch empfindlich auf Sauerstoff reagiert und dabei wieder CO2 an die Luft abgibt. Ohne diese Ineffizienz könnte die Pflanze deutlich höhere Mengen an CO2 fixieren und ertragreicher sein.
Forschung in WürzburgOptimierte CO2-Fixierung – ein Modell
Teamleiter Dandekar sagt: „Unser Ergebnis ist also ein theoretischer Durchbruch, aber jetzt müssen natürlich noch die tatsächlichen Experimente kommen.“ Die Rechenergebnisse sollen in praktische Versuche umgesetzt werden. Dabei wollen die Forschenden kein Geoengineering betreiben, sondern eine voll reversible, kleinskalige Klimaschutzstrategie nutzen. Dandekar kann sich verschiedene Ansätze vorstellen:
Einsatz von GentechnikEthische Fragen
Dandekar greift mit Hilfe der Gentechnik in die Chloroplasten der Pflanzen ein. Laut ihm ist dies ein Vorteil, da nur ein geringer Bereich verändert wird und der Rest der Pflanze so weiterarbeiten kann wie bisher. Doch auch über ethische Aspekte denkt der Forscher nach:
Kompromisse in der Forschung
Viele Einflussfaktoren, fehlende BesserungInsektensterben in Wiesen und Wäldern von Helena Gennutt
Abnehmende Vielfalt
Die Ursachen für das Insektensterben sind dabei schwierig nachzuvollziehen. „Wir wissen bei ganz vielen Faktoren, dass sie den Insektenrückgang beeinflussen. Es ist jedoch schwierig, den wichtigsten Faktor eindeutig zu bestimmen, weil die Faktoren in der realen Landschaft oft miteinander korrelieren“, erklärt Wolfgang Weisser, Professor für terrestrische Ökologie an der TUM.
Negativer Einfluss durch Agrarwesen
Eine Metastudie des australischen Ökologen Francisco Sánchez-Bayo vom Sydney Institute of Agriculture aus dem Jahr 2019 prognostiziert gar, dass bereits in 100 Jahren viele Insekten ausgestorben sein könnten: Den Forschern zufolge nimmt die Insektenmasse jährlich um 2,5 Prozent ab und ein Drittel der Insektenarten ist bereits heute vom Aussterben bedroht. Weisser erklärt im Interview, wie der Rückgang einer Art mit dem Aussterben derselben zusammenhängt.
Quelle Bild: Dr. Ulrike Garbe / Landesamt für Umwelt, Brandenburg
Landwirtschaftliche Flächennutzung
Auch im Insektenatlas der Heinrich-Böll-Stiftung wird betont, dass die Gestaltung der Landschaft in ihrer Gesamtheit gegenüber der Bewirtschaftung einzelner Felder relevant ist. Denn Insekten benötigen neben Blühstreifen, die ihnen Nahrung bieten, auch Wohnorte, etwa im Boden oder Totholz. „Wenn die ewig weit weg sind, dann nützt der Blühstreifen nichts“, erklärt Weisser. Im Interview spricht er darüber, wie Menschen und Insekten nebeneinander leben können.
WaldnaturschutzMehr Schutz für Wälder
So wird etwa dafür gesorgt, Totholzbestände zu erhalten oder den Wald mit diesen anzureichern. Totholz ist allerdings nicht der einzige Einflussfaktor auf Waldinsekten. Zwar seien die Probleme in der Agrarlandschaft laut Weisser größer, die Rückgänge im Wald dafür schwieriger nachzuvollziehen. Auch hier vermutet er weitere Ursachen auf Landschaftsebene.
Einsatz von Pestiziden
„Allerdings hätten wir denselben Effekt auf die Insekten, wenn die Wildkräuter mit anderen Methoden, zum Beispiel mechanisch oder thermisch, entfernt würden“, sagt Christian Maus, Insektenforscher beim Chemie- und Pharmakonzern Bayer. Die Anforderungen an die Umweltsicherheit von Pestiziden seien seit den Neunzigerjahren strenger und die Evaluierungsmethoden ausgefeilter geworden. Anders sieht es in Afrika und Südamerika aus, wo laut Insektenatlas teilweise Mittel eingesetzt werden, die in der EU seit Jahrzehnten verboten sind.
Freiwillige Umweltprogramme statt gesetzliche Vorgaben?
Denn in der Landwirtschaft brauche es immer den regionalen Bezug, der sich über Gesetze schlecht definieren lasse. Außerdem nähmen die Landwirte freiwillige Programme wie das bayerische Vertragsnaturschutzprogramm und das Kulturlandschaftsprogramm (KULAP) gut an. Bei diesen Programmen erhalten sie Ausgleichszahlungen für umweltschonende Bewirtschaftung. „Im Öko-Landbau ist Unterfranken mit an der Spitze“, sagt Köhler. Dies belegen auch die aktuellen Teilnahmezahlen an den KULAP-Maßnahmen.
Fehlende Erfolge
Wie passt das zusammen?Nachhaltige Fleischproduktionvon Felix Dreifürst
Fleisch als Alltagsprodukt
Zu viel Fleisch pro Kopf
Aber mit welchen Folgen? Beim Thema Klimawandel und Umwelt denken viele an Verkehr, Industrie oder Kohlekraftwerke und nicht etwa an den zentralen Faktor Fleischkonsum. Dabei belastet Fleisch die Umwelt enorm.
Der große Klimasünder
Lösungsansätze
Fleisch und Wurst mit Verbands-Biosiegeln wie etwa Bioland, demeter, Naturland, Biopark und Biokreis erfüllen neben den EU-Mindestanforderungen auch weitere Kriterien. Dazu gehört zum Beispiel der Einsatz von weniger Zusatzstoffen in der Lebensmittelverarbeitung. Doch bedeutet Bio auch gleichzeitig eine bessere CO2-Bilanz?
Auenland BeefRegionalität als Markenzeichen
Quelle Bild: Auenland Beef GmbH, Hofheim
Sensibilität für das Produkt
Der gesellschaftliche Trend bewege sich trotz des hohen Pro-Kopf-Konsums zu weniger, jedoch bewussterem Fleischkonsum. Das zeigt auch eine Statistik der Bundesanstalt für Landwirtschaft und Ernährung: Mit einem Pro-Kopf-Verzehr von 59,5 Kilogramm nimmt der Konsum von Fleisch tendenziell ab.
Quelle Bild: Auenland Beef GmbH, Hofheim
Nachhaltigkeit in Großbetrieben
Regionalität wird auch hier großgeschrieben. Kurze Vertriebswege und eine starke Bindung zur Heimat sind laut Geschäftsführer Peter Schmitt zentrale Punkte der Unternehmensphilosophie. „Viele unserer Kunden wollen wissen, wo das Fleisch herkommt. Regionalität und Transparenz sind daher unabdingbar für den zukünftigen Erfolg des Unternehmens“, sagt Schmitt.
Wertschätzung ist die Voraussetzung
Neue Gesetze müssten die Produktionsbedingungen direkt angehen. Zum Beispiel mit einer zweckgebundenen Abgabe, die direkt in mehr Tierwohl und bessere Arbeitsbedingungen investiert wird. Mit dem erst kürzlich beschlossenen Gesetzentwurf zum Verbot von Werkverträgen ist nun ein erster Schritt getan. Doch über all dem steht der Kunde. Eine grundlegende Änderung der Verbraucher ist Voraussetzung für einen bewussten und nachhaltigen Fleischkonsum.
Kreislaufwirtschaft Waldvon Svenja Kordmann
Fast ein Drittel Deutschlands ist mit Wald bedeckt. In Bayern wachsen Wälder auf gut einem Viertel der Landesfläche. Der Freistaat zählt damit zu den am meisten bewaldeten Bundesländern. Die nachhaltige Forstwirtschaft erhält durch den rasanten Klimawandel eine immer höhere Bedeutung.
Für einen zukunftsfähigen Wald
Der Kreislauf des Holzes
Das Prinzip des Waldes bringt vielseitige Stärken mit sich: Durch Photosynthese nehmen Bäume Kohlenstoff auf und geben Sauerstoff ab. Wird der Baum gefällt, bleibt der Kohlenstoff im Holz, bis er schließlich verbrannt wird. Der Kohlenstoff wird dann beim Verbrennen freigesetzt – das Holz gilt in der Gesamtbilanz immer noch als CO₂-neutral. Gleichzeitig entsteht keine sogenannte graue Energie, also Energie die beim Herstellen, Transportieren, Lagern, Verkaufen und Entsorgen von Produkten entsteht. Holz wächst im Wald und muss nicht aufwendig verarbeitet werden. Lediglich das Sägen, Hobeln und Kleben kostet Energie.
Vielseitige Möglichkeiten
Der Rohstoff Holz findet immer mehr Anwendungsmöglichkeiten: In den etablierten Sparten Holzbau, Papier und Zellstoff, aber auch als Textilfaser oder Basis-Chemikalie. Um beispielsweise Textilien aus dem Fasermaterial Viskose, Kosmetik, Aromen oder Pharmazeutika zu produzieren, werden in Bioraffinerien Zwischen- und Endprodukte verwertet. Die große Stärke von Holz liegt außerdem in der hohen Verfügbarkeit in den Regionen mit entsprechend kurzen Lieferwegen.
Klimawandel als Endgegner
Zukunftsfähiger Waldumbau
Wald im Wandel
Gleichzeitig gilt es, Energie und Material zu sparen. „Wir müssen unsere fränkisch einheimischen Baumarten wie Eiche, Elsbeere, Feldahorn fördern und ein paar exotische Baumwarten wie Zedern, Flaumeichen, Baumhaseln in homöopathischen Mengen im Waldbestand integrieren." Erste Wälder zeigen diesen Wandel bereits. So gibt es in Würzburg deutschlandweit das größte Vorkommen von Baumhaseln, ursprünglich ein Waldbaum aus Südosteuropa und der Türkei. Auch andere Arten, die ursprünglich nicht aus Deutschland stammen, sind bereits seit Jahrhunderten hier heimisch, wie Röder von der bayerischen Cluster-Initiative berichtet:
Ökologischer Fußabdruck ist klein
Der Klimaschutzeffekt in der Forstwirtschaft entsteht zum einen durch mehr Waldfläche und Holzprodukte. Zum anderen werden Emissionen vermieden, wenn der biogene Rohstoff Holz verwendet wird. Holz lässt sich mit geringem Energieeinsatz verarbeiten, deshalb bleibt der ökologische Fußabdruck der meisten Holzprodukte vergleichsweise klein. Laut der „Clusterstudie Forst und Holz 2015“ werden etwa 25 Prozent der CO₂-Emissionen Bayerns durch die Verwendung von Holz ausgeglichen. Doch nicht nur für die CO2-Emissionen ist die Forstwirtschaft wichtig. Stadtförster Schönmüller erklärt, was es bedeutet, wenn Wälder nicht nachhaltig bewirtschaftet werden:
Palmöl
Ein Palmölverbot ist auch keine LösungVon Janice Krebs
Seit Jahren steht die Ölpalme in der Kritik: Sie sei schuld, dass der Regenwald abgeholzt werde, mache Orang-Utans ihren Lebensraum streitig und befeuere den Klimawandel. Der Schriftzug „ohne Palmöl“ auf Verpackungen gilt als Qualitätsmerkmal. Welches Fett das Palmöl dabei ersetzt, scheint keine Rolle zu spielen. Oft ist es das in Mode gekommene Kokosfett, das ähnliche Eigenschaften aufweist und an weiße Sandstrände statt an Monokulturen erinnert. Doch hat die Palme mit den orangenen Früchten und dem weißen Kern ihren schlechten Ruf verdient?
Ölpalmen decken 40 Prozent des weltweiten Bedarfs
Ölpalmen sichern 40 Prozent des weltweiten Bedarfs an Pflanzenölen, nehmen jedoch nur ein Zehntel der Gesamtfläche in Anspruch. Zum Vergleich: Kokosfett deckt etwa ein Prozent des Bedarfs, wächst aber auf gut fünf Prozent der Gesamtfläche. In den Anbauländern hat die Ölpalme nicht nur soziale und ökologische Probleme geschaffen, sondern auch für positive Veränderungen gesorgt.
Landrechte bieten soziale und ökologische Vorteile
„Ein wichtiger Schritt wäre es, mehr auf den Flächen zu produzieren, die bereits bewirtschaftet werden, anstatt zusätzlichen Wald zu roden“, sagt Qaim, der die ökologischen, ökonomischen und sozialen Auswirkungen des Palmöl-Booms erforscht. Das bedeutet, dass die Erträge gesteigert werden müssten. Und da gibt es laut dem Forscher Potential: Pro Hektar werden etwa drei Tonnen Palmöl erwirtschaftet, es seien aber bis zu acht Tonnen möglich. Die Erträge könne man mit organischen Düngern und verbessertem Pflanzenmaterial steigern. Durch die Flächenknappheit werden Ölpalmen zudem zunehmend in ungünstigen Klimaregionen angebaut, was die Produktivität senkt. Eine Lösung wären resistentere Ölpalmensorten.
Um höhere Erträge zu erzielen, müsse man auch Kleinbauern und -bäuerinnen sichere Landrechte geben. Qaim erklärt, warum diese so wichtig sind und welche Rolle hierbei auch der Staat spielt:
Und Qaim erklärt welche Möglichkeit es noch gibt, den Ölpalmenanbau ökologischer zu gestalten:
Nachhaltigkeitszertifikate mit ausbaufähigem Potential
Der wirksamste RegenwaldschutzWeniger Autofahren, weniger Fleisch essen
Auch Verbraucher:innen können etwas tun, um dem Regenwald zu helfen, meint Qaim.
Klimafreundlicher Reisanbau
Wie Bakterien den Anbau von Reis klimafreundlicher machenVon Lea Holzamer


Von allen Nutzpflanzen hat Reis jedoch eine der schlechtesten Klimabilanzen. Warum erklärt Ralf Conrad, emeritierter Professor und ehemaliger Leiter der Abteilung für Biogeochemie des Max-Planck-Instituts für terrestrische Mikrobiologie.

Methan ist 25-mal schädlicher als CO2 und trägt somit erheblich dazu bei, dass die Erde wärmer wird. Dadurch entsteht eine Diskrepanz: Reis ernährt zwar einen Großteil der Weltbevölkerung, befeuert aber gleichzeitig die Klimakrise.
Wie die Methanbildung gestoppt werden kann



Die Menschen haben es in der Hand
Sustainable Rice PlatformFragwürdiger Nachhaltigkeitsstandard
Sustainable Rice Platform Schwache Kontrollmechanismen
Also sollten wir, um die Umwelt zu schützen, einfach auf Reis verzichten? So einfach ist das nicht, sagt Conrad:
Spinnenseide
SpinnenseideEin Multitalent für die Medizinvon Marlen Schubert
Foto: Karl-Heinz Romann
Spinnenseide schützt vor Schimmel
Kein Material vereint so viele Eigenschaften
Foto: Philipp Martin Schroeder, Aquazoo Düsseldorf
Natürliche Spinnenseide gewinnen
Der Zehnkämpfer unter den Seiden
Die Seide aus dem Reagenzglas
Der Blick auf die Proteine zeigt: In allen Spinnenseiden befinden sich vorne und hinten Domänen, die wie Schalter funktionieren. Doch erst durch einen Labor-Unfall sind die Forschenden hinter die Funktionsweise der Schalter gekommen. In einer Probe hatten sich zwei Schichten gebildet: eine Wasserschicht und eine ölige, in der sich alle Moleküle befanden.
Um einen künstlichen Seidenfaden zu bilden, ist aber noch ein mechanischer Zug nötig. Aus der Wasserschicht erhält man lediglich schlechtes Nylon, aus der öligen dahingegen eine Faser mit besonderen Eigenschaften. Die Moleküle bringen sich also selbst in die richtige Position. „Das ist genau das, was in der Spinne passiert. Die speichert ihre Proteine in der Drüse, ready to go, denn wenn sie sich abseilt, dann braucht sie die direkt“, so Scheibel.
Foto: Anna Bartz
Ein Implantat umhüllt von Spinnenseide
Das Billigste ist nicht immer das Beste
Allerdings könnten Produkte teurer werden, weil sie nachhaltig hergestellt würden und weil mehr Technologie und Know-how dahinterstecke. Der Biochemiker betont aber: „Wir müssen uns alle Gedanken machen, wenn wir nachhaltig wirtschaften wollen: Dann ist vielleicht nicht immer das Billigste das Beste.“
Algen II
Vielseitige WasserlebewesenWo Algen fossile Rohstoffe ablösen können Von Nina Kammleiter
Algenforschung für verschiedene Klimazonen
Foto: Andreas Heddergott / TU München
Mit Mikroalgen um die Welt fliegen
Foto: Andreas Heddergott / TU München
Foto: Hochschule Bremerhaven/AWI
Essbare Verpackungen aus Makroalgen
Foto: Hochschule Bremerhaven/AWI
Von der Forschung in die Industrie
Foto: Hochschule Bremerhaven/AWI
BEHIND THE SCENES
Bioökonomie: Eine Multimedia-ReportageHinter den Kulissen

Doch wie nähert man sich einem so komplexen Thema? Wie funktionieren Interviews in Zeiten von digitaler Lehre und Kontaktbeschränkungen? Und welche Herausforderungen, Hindernisse und Überraschungen gab es sonst noch für die Studierenden? Der Blick hinter die Kulissen des vom Bundesministerium für Bildung und Forschung geförderten Projekts gibt Antworten.
Wir stellen uns vor
Zum Anfang Zum Anfang Zum AnfangStudierende berichten
Und wie hat‘s euch gefallen?

Statt Kameraschulung und Videodreh vor Ort mussten die Studierenden diesen Sommer mit Online-Interviews vorlieb nehmen. Zwar sind dabei keine Loops oder Drohnen-Aufnahmen entstanden, spannende Meinungen aus dem Bereich der Bioökonomie und wertvolle Erfahrungen für die Zukunft haben die angehenden Journalist*innen aber trotzdem gesammelt. Hier berichten sie davon.
Ronja-Valentina Voit
Zum AnfangAmelie Mangler
Zum AnfangDavid Le
Zum AnfangAnne Köppen
Zum AnfangRomel Aleksanian
Zum AnfangBirte Kock
Zum AnfangMaximilian Roos
Zum AnfangSelina Pellner
Zum AnfangRenan Schmid
Zum AnfangLara Jack
Zum AnfangNaomi Berhane
Sofie Reichel
ABOUT & IMPRESSUM

Bioökonomie: Eine Multimedia-Reportage | Über dieses Projekt

Das Bundesministerium für Bildung und Forschung (BMBF) fördert mit dieser Multimedia-Reportage im Rahmen des Wissenschaftsjahres 2020/21 ein Projekt, das Fragen wie diesen nachgeht. Rund 200 Studierende der Universität Würzburg, der Hochschule für Angewandte Wissenschaften Würzburg-Schweinfurt und der Macromedia Hochschule Köln nehmen hier das Thema Bioökonomie unter die Lupe. Bei den Inhalten werden sie intensiv vom Sachverständigenrat für Bioökonomie Bayern unterstützt. Sie beleuchten, welche bioökonomischen Technologien heute schon zum Einsatz kommen, wie der Wandel von einer erdöl- zu einer biobasierten Wirtschaft gelingen kann und was eine solche Bioökonomie für die Umwelt, das Klima und unsere Gesellschaft bedeutet. In Text-, Audio- und Videobeiträgen kommen dabei Expert*innen aus Wissenschaft und Wirtschaft zu Wort, die spannende Einblicke in Forschungsprojekte und innovative Technologien geben und dabei zeigen, wie die Bioökonomie einzelne Unternehmen, ganze Branchen und nicht zuletzt unseren gesamten Lebensalltag grundlegend verändern kann. Teil des Projekts war außerdem eine Online-Diskussion über das Thema "Nachhaltige Ernährung", an der unter anderem Renate Künast (Bündnis 90/Die Grünen) und ein Vertreter des Fleischkonzerns Tönnies teilnahmen.
Im Wissenschaftsjahr 2020/21 kooperiert die Universität Würzburg mit der Hochschule für Angewandte Wissenschaften Würzburg-Schweinfurt sowie der Macromedia Hochschule Köln. Mit ihren Projektpartnern realisiert sie bereits zum dritten Mal eine Multimedia-Reportage im Rahmen des Wissenschaftsjahres. So entstanden im Wissenschaftsjahr 2018 und 2019 die Multimedia-Reportagen Arbeitswelten der Zukunft und Künstliche Intelligenz. Die Main-Post, der Bayerische Rundfunk, die Frankfurter Rundschau, die Rheinische Post sowie die Vogel Communications Group sind Medienpartner des Projekts.
Impressum
Universität Würzburg
Professur für Wirtschaftsjournalismus und Wirtschaftskommunikation
Prof. Dr. Kim Otto
Sanderring 297070 Würzburg
Tel.: +49 (0)931 31-88226
E-Mail: kim.otto@uni-wuerzburg.de

KURZFILME & PODCASTSs

PODCASTs
Expert*innen im GesprächBioökonomie im Klartext

Fleischersatz Podcast
"Es ist einfach eine Frucht, die eben diese Struktur von Fleisch hat"
Gen-Pflanzen Podcast
"Jetzt müssen natürlich die Arbeiten experimenteller Art kommen."
"Eine ideale Partnerin der erneuerbaren Energien."
Biokunststoffe Podcast
"Solche Entwicklungen können nur im Team gelingen."
Rapsasphalt Podcast
„Es gibt sehr viele Möglichkeiten, um mit klassischem Straßenbau Nachhaltigkeit zu betreiben.“
SoLaWi - Podcasts
Landwirtschaft gemeinsam anpacken

Aber wie funktionieren Erzeuger-Verbraucher-Gemeinschaften in der Praxis? Lohnt sich die Direktvermarktung für landwirtschaftliche Betriebe? Und wie alltagstauglich ist das Konzept für Verbraucher*innen? Unsere Studierenden haben sich umgehört.
Solidarische Landwirtschaft Podcast Köln
„Es lohnt sich absolut – auch ökonomisch.“
SoLaWi-Podcast FHWS
"Wir müssen anfangen, auch aktiv zu werden"
Algen Podcast
"Wir haben die Möglichkeit, ohne Abfallströme zu leben"
E-Mobilität Podcast
"Die größte Hürde ist der fehlende Veränderungswille."
Studentin Amelie Mangler geht der Klimabilanz der E-Mobilität auf den Grund und spricht dafür mit Dr. Jörg Geier aus der "Modellstadt der Elektromobilität" Bad Neustadt an der Saale und mit Prof. Dr. Maximilian Fichtner vom Helmholtz-Institut Ulm.
Wasserwirtschaft Podcast
"Die Ressource Wasser wird in Zukunft viel, viel wichtiger werden"
Medizinprodukte Podcast
"Wir müssen anwendungsorientiert forschen"
Fleischproduktion Podcast
"Fleisch ist meiner Meinung nach viel zu billig in Deutschland"
Foto: Auenland Beef
Recyclingfähige Verpackungen Podcast
"Die Umstellungsprozesse sind sehr komplex"
Forstwirtschaft Podcast
"Bauen mit Holz ist aktiver Klimaschutz"
Podcast_Pilze als Wasserfilter
„Pilze sind aufgrund ihres Enzymsystems in der Lage komplexe Verbindungen zu spalten“
Podcast_Palmöl
„Die Ölpalme ist nicht böse“
Podcast_Klimafreundlicher Reisanbau
„Dank Forschung an neuen Reissorten haben wir höhere Erträge“
Podcast_Bioökonomie & Gesellschaft
„Unsere bioökonomische Zukunft ist abhängig von einer gesellschaftlichen Auseinandersetzung, die in den kommenden Jahrzenten zu führen ist“
Podcast_Pflanzenzüchtung
„Wir passen unsere Pflanzen ständig und über lange Zeit an die sich verändernden Umweltbedingungen an“
Podcast_Nachhaltige Batterien
„Die Lithium-Ionen-Batterie ist der Zehnkämpfer unter den Batterietechnologien“
Podcast_Bioherbizide
„Wir müssen hinhören und hinschauen, welche Vielfalt an Problemlösungen die Natur im Laufe einer Millionen Jahre entwickelt hat“
Podcast_Algen_als_Verpackung
„Wir streben an, diese Verpackung in drei Jahren im Industriemaßstab herstellen zu können“
Podcast_Abwasser_Recycling
„Abwasser ist ein Nährstofflieferant für die Landwirtschaft“
Foto: ISOE (Institut für sozial-ökologische Forschung)
KURZFILME
Spannende Projekte im RampenlichtBioökonomie in Bild und Ton

Nachhaltige_Forstwirtschaft_Kurzfilm
Zum AnfangSolidarische_Landwirtschaft_Kurzfilm
Zum AnfangRapsasphalt_Kurzfilm
Zum AnfangNachhaltige_Fleischproduktion_Kurzfilm
Zum AnfangPflanzen als Klimaretter_Kurzfilm
Zum AnfangElektromobilität_Kurzfilm
Zum AnfangWindkraft
Crosswind energySystemsAlternative Stromerzeugung durch Windkraftvon Marvin Wollschläger, Felix Dauerer, Maximilian Hauck
Das Würzburger Unternehmen Crosswind hat sich auf Windkraftanlagen spezialisiert. Die Ingenieure entwickeln und stellen die Anlagen selbstständig her. Windenergie wird seit dem Altertum als erneuerbare Energiequelle genutzt, um Strom zu gewinnen. Bei Windkraftanlagen wird zwischen Onshore- und Offshore-Windparks unterschieden. Onshore-Windparks werden an der Küste und im Binnenland errichtet. Offshore-Windparks erzeugen ihren Strom auf dem Meer, in großem Abstand zur Küste. Über unterirdische Kabel wird der Strom weitergeleitet und gelangt von dort aus in die jeweiligen Haushalte. Die Windkraft besticht vor allem durch ihre Wirtschaftlichkeit und ihre Umweltfreundlichkeit. Dadurch wird die örtliche Wirtschaft angekurbelt und die Energie-Importe aus dem Ausland reduziert. Der lokale Strompreis wird ebenso stabilisiert. Bei der Stromerzeugung durch Windkraft werden keine schädlichen Brennstoffe produziert, weswegen Umwelt- und Gesundheitsschäden dadurch vermieden werden können. Außerdem steht Wind im Gegensatz zur Sonne Tag und Nacht zur Verfügung, es kann also permanent Strom erzeugt werden.
Die horizontale WindkraftanlageHoch hinaus
Die horizontale Windkraftanlage bildet die effektivste Methode durch Wind Strom zu erzeugen und erreicht einen Wirkungs-grad von knapp 50 Prozent. Je höher der Wirkungsgrad, desto weniger Kohlendioxid (CO2) wird pro erzeugte Kilowattstunde frei. Zum Vergleich: Ein Kohlekraftwerk hat einen Wirkungsgrad von 30 bis 40 Prozent.
Der meiste Strom wird im Norden von Deutschland gewonnen, da dort der meiste Wind weht. Dementsprechend ist hier auch der größte Teil der Anlagen und Windparks zu finden. In einem Jahr produziert eine solche Anlage Strom für ein ganzes Dorf. Dieter Irl von Crosswind erläutert die Vorteile von horizontalen Windkraftanlagen:
Web-basierte Kontrolle durch ZEFIR-SCADAFernüberwachung
Über das Kontrollsystem hat der Betreiber aber auch einen ständigen Zugriff auf alle Betriebsparameter, es können z.B. aktuelle Wetterdaten abgerufen werden und mit älteren abgeglichen werden. Bei Störungen kann die Anlage aus der Ferne abgeschaltet oder neu gestartet werden – und das nicht nur vom Computer, sondern sogar vom Handy aus.
Vertikale Windkraftanlage Strom vom DachEigenproduzierter Strom zur Selbstversorgung
1. Spannbeton - Turm
Diese Fertigung garantiert hohe, technische Parameter und eine glatte Oberfläche.
2. Stahlturm mit Abspannseil
Das Leichtbausystem besitzt die Möglichkeit einer schnellen Turmdemontage. Die kurzen Turmteile ermöglichen einen leichten Transport.
3. Flachdach Turm
Besteht aus einem Stahlgitter mit hoher Spannweite, was eine große Stabilität in der gesamten Struktur gewährleistet.
Zusätzliche Verstrebungen innerhalb der Turbine ermöglichen eine Versteifung der einzelnen Rotorflügel miteinander.
Mithilfe des Scheibengenerators kann die kinetische Energie des Windes in Elektrizität umgewandelt werden. Der Generator wurde dabei so entwickelt, dass keine Reibung entsteht und so eine permanente Wartung ausgeschlossen wird.
Der Mast
dient als Grundgerüst und ergibt zusammen mit dem Fundament den Turm. Hierbei
gibt es drei verschiedene Möglichkeiten für den Aufbau:
1.
Spannbeton
- Turm
Diese Fertigung garantiert hohe, technische Parameter und
eine glatte Oberfläche.
2.
Stahlturm
mit Abspannseil
Das Leichtbausystem besitzt die Möglichkeit einer schnellen
Turmdemontage. Die kurzen Turmteile ermöglichen einen leichten Transport.
3.
Flachdach
Turm
Besteht aus einem Stahlgitter mit hoher Spannweite, was eine
große Stabilität in der gesamten Struktur gewährleistet.
Der Unterbau für den Turm auf einem Flachdach trägt beispielsweise durch eine berechnete Grundfläche zu einer hohen Stabilität der gesamten vertikalen Windkraftanlage bei. Zusätzliche Schwingungsdämpfer verhindern dabei Vibrationen.
Die aerodynamisch ausgelegten Rotorflügel der Turbine bestehen aus einem nahtlosem, extrudiertem Aluminium-Profil. Sie sind wasserfest und wasserabweisend.
Selbstversorgung eines Hotels
Der Hotelier hat, neben der eigenen Stromgewinnung, aber auch noch Marketingvorteile der Windkraftanlage für sich entdeckt. So hat er auf den großen Rotorflügeln viel Platz für Beschriftungen und das Windrad auf seinem Hotel schafft einen Wiedererkennungswert bei den Gästen.
Wie gestaltet sich die Trendwende zu erneuerbaren Energien?Grüner Strom
Weiterhin basteln die Ingenieure an einer Multirotorenanlage – eine Windkraftanlage mit mehreren Rotorflügeln. Sie hat den Vorteil, dass ein einzelner Ausfall von Rotoren überbrückt werden kann und kein Strom verloren geht. Dieter Irl, Geschäftsführer von Crosswind energySystems, wagt einen Blick in die Zukunft:
RecyclingNachhaltiges Altpapiervon Denise Klemke und Pascal Väth
Da Altpapier in verschiedenen Schritten aufbereitet wird, gehen zwangsläufig Fasern verloren. Um den Papierkreislauf aufrechterhalten zu können, müssen also immer wieder Frischfasern in den Kreislauf eingebracht werden, wie Samuel Schabel, Leiter des Fachgebiets Papierfabrikation und Mechanische Verfahrenstechnik an der TU Darmstadt, weiß.
RecyclingprozessDie ersten Versuche
Auch heute noch ist es ein komplexer Vorgang, der viel optimiert wird. Am Kunststoff-Zentrum SKZ wurde zuletzt das Verfahren der Extrusion untersucht, wodurch stark verun-reinigtes Altpapier ganz ohne zusätzlichen Wasserverbrauch effizient gereinigt werden kann. Normalerweise verbraucht der Recyclingprozess viel Wasser, wie Lars Helmlinger meint. Er gilt als Experte für Aufbereitungstechnologien am SKZ.
Aktiver Klimaschutz
Einsparpotenzial
Wenn allein in Deutschland beispielsweise ausschließlich Recyclingpapier als Büro- und Kopierpapier verwendet würde, ließen sich jährlich rund 146.000 Tonnen CO2-Emissionen einsparen. Außerdem würde eine Tonne Recyclingpapier im Vergleich zu neuem Papier die Menge an CO2 einsparen, die ein durchschnittliches Auto auf rund 1.000 km ausstößt, wie die Initiative Pro Recyclingpapier veröffentlichte.
Forderung nach NachhaltigkeitAutomobilindustrie unter Druckvon Pascal Kukielka und Louis Mauser
Die Lösung des Problems?Dekarbonisierung
„Bei dem strategischen Ziel, weltweit führender Anbieter für E-Mobilität zu werden, kann die Fokussierung auf die konse-quente Dekarbonisierung ein starker Wettbewerbsvorteil sein.“, sagt Georg Kell, Sprecher des Nachhaltigkeitsbeirats
der Volkswagen AG.
E-FuelAlternativer Antriebsstoff
in naher Zukunft noch nicht mit dem E-Fuel zu rechnen.
Wasserstoff-Brennstoffzelle
Problematisch ist allerdings, dass der Wasserstoff zunächst aus chemischen Verbindungen herausgelöst werden muss, damit er anschließend in der Wasserstoff-Brennstoffzelle genutzt werden kann. Nutzt man hierzu Strom aus Kraftwerken, ist eine negative Umweltbilanz des Energieträgers Wasserstoff die Folge und diese Brennstoffzelle nicht die optimale, nachhaltige Lösung.
Kreislaufwirtschaft
Erfolg durch Einsparung
Regionale Logistik
Regionale Logistikvon Sebastian Werner und Constantin Luther
Hier setzt regionale Logistik an. Claudia Schreiber, Projekt-leiterin beim Bundesverband der Regionalbewegung e.V. ist der Meinung, dass diese in Zukunft immer wichtiger wird:
Regionale Produkte
Nutzung vorhandener Ressourcen
Ökonomischer und ökologischer wäre, durch Kooperationen zwischen verschiedenen Betrieben, die sowieso vorhandenen Fahrzeuge und Fahrten optimal auszulasten. Der Meinung ist auch Anja Sylvester, Geschäftsführerin der LandLogistik GmbH, die einen weiteren Vorschlag hat:
Projekt KombiBus UckermarkAufwertung des ÖPNV
Einerseits wird die Nahversorgung gesichert, andererseits werden neue regionale Absatzmärkte für lokale Erzeuger und Produzenten erschlossen. Durch den neu konzipierten Fahrplan gelingt es sogar, eine taggleiche Anlieferung von Produkten innerhalb der Uckermark zu gewährleisten.
Digitalisierung in der LogistikEine App für alle
Erste Apps, die Lösungen hierfür anbieten, gibt es bereits. Davon profitieren die Anbieter der Ladeflächen, da sie finanziell entlastet werden. Außerdem können die Nachfrager von den neuen Lieferoptionen profitieren und ihre Kosten senken. Schlussendlich profitiert auch die Allgemeinheit, da die Logistikkosten verringert und Straßen sowie Klima weniger belastet werden. Einen weiteren wichtigen Ansatz definiert Sylvester:
Wichtiges Instrument der NachhaltigkeitÖffentliche Beschaffungvon Emma Veser, Sandra Schoene und Denise-Madeleine Tohsche
Das richtige Mittel
Studie zur öffentlichen BeschaffungBiobasierte Produkte
Auswirkungen der Lebenszykluskosten
Jedoch sollte der Preis nicht der einzige relevante Aspekt sein. Darum sollte ein Blick auf die Lebenszykluskosten geworfen werden, da diese sich bei vielen biobasierten Produkten mit der Dauer und der Langfristigkeit relativieren. Das weiß auch Bogaschewsky:
Zielsetzung
Öffentlicher Sektor als Vorbildfunktion
Denn das Wohlergehen der Bürger wird maßgeblich durch die öffentliche Beschaffung beeinflusst. Als Großverbraucher verfügt die öffentliche Hand über eine starke Marktmacht, welche sie nutzen kann und sollte, um umweltpolitische Ziele zu fördern.
Bodenschutz
Bodenschutz als Gemeinschaftsaufgabe von Antonia Ertl und Alina Strobel
Relevanz für Mensch und ÖkosystemBedeutung der Böden
ErosionUrsachen mit weitreichenden Folgen
Die Rolle des MenschenBodenversiegelung
Auch Professor Dr. Karl Stahr, Professor im Ruhestand an der Universität Hohenheim und Vorsitz der Arbeitsgruppe Geschichte der Bodenkunde in der Deutschen Bodenkundlichen Gesellschaft (DBG), stellt fest, was für eine Problematik mit der Bewirtschaftung einhergeht:
Bodenschutz als mathematische GleichungTechnische Maßnahmen
Bodenschutz im Alltag
Die Kompostierung organischer Abfälle im eigenen Garten wird empfohlen, da deren Nährstoffe in Teilen zurückgeführt werden können. In einigen Studien zeigte sich, dass so der Humusgehalt im Boden erhalten, und die biologische Aktivität der Böden gefördert wird. Ein zusätzlicher Faktor auf dem eigenen Grundstück ist weiter ein vorsichtiger Umgang mit zu versiegelnden Flächen. So sollte beispielsweise bei der Planung privater Wege oder Stellflächen darauf geachtet werden, dass diese in der Zukunft zurückführbar sind, und der Boden nicht nachhaltig unbrauchbar für das Ökosystem wird.
Systemwechsel in der LandwirtschaftIntegrierter Pflanzenschutzvon Johanna Kalmbach und Helena Karl
“Wenn im Anbausystem die Ressourcen nicht nachhaltig genutzt werden, ist das System langfristig nicht enkeltauglich“, sagt Dr. Brigitte Kranz. Sie ist Geschäftsführerin der IBMA Deutschland/Österreich, ein Dachverband, der Hersteller und Anbieter von biologischen Pflanzenschutzmitteln vertritt. Der Verband macht sich für den integrierten Pflanzenschutz stark. Dadurch soll die Landwirtschaft nachhaltiger gestaltet werden.
Pyramide des PflanzenschutzesDer integrierte Ansatz
Im oberen Bereich der Pyramide finden sich biologische Pflanzenschutzmaßnahmen. Als letztes Mittel der Wahl stehen an der Spitze schließlich chemisch-synthetische Pflanzen-schutzmittel. Das Motto lautet, so wenig Chemie wie möglich – so viel wie nötig. Doch das klappt nicht immer, wie Enno Bahrs, Agrarwissenschaftler mit Schwerpunkt Agrarökonomie an der Universität Hohenheim, feststellt:
Kritik an chemischen Mitteln
Biologische Maßnahmen
Die Pyramide im Fokus
Ganz ohne geht es nichtGezielter Einsatz der Chemie
Er sieht in diesem Zusammenhang zwei Annäherungs-notwendigkeiten. “Die landwirtschaftliche Produktion muss sich aufgrund der Resistenzentwicklung noch stärker auf einen integrierten Pflanzenschutz stützen“, erläutert Gehring. “Auf der anderen Seite muss sich die Gesellschaft damit zurechtfinden, dass Landwirte gezielt chemische Pflanzenschutzmittel in der Produktion verwenden, wenn sie nicht nur hochpreisige, ökologisch produzierte Lebensmittel konsumieren will“.
Sowohl Kranz als auch Bahrs sind ebenfalls der Auffassung, dass der Verbraucher hier eine wichtige Rolle spielt:
Energieholz
Heizen mit Holz: ein zweischneidiges SchwertEnergieholzvon Berenike Caesar und Julian Glöckner
Wärme und Stromerzeugung
Kostenvergleich
‘Kurzumbetriebsfläche‘Schnelles Baumwachstum
Energieeffizienz
Kurze Transportwege
Emissionen
In Bezug auf die Stickoxide, welche immer wieder in den Städten thematisiert werden, spiegelt sich ein anderes Bild wider. „Die Stickoxidproblematik wird durch Dieselfahrzeuge erzeugt, hierbei spielen Holzfeuerungsanlagen eine relativ geringere Rolle“, zeigt Huth auf. Die Menge an Energieholz, die aus deutschen Wäldern nachhaltig erwirtschaftet werden kann, stößt nach den Angaben von Forschungseinrichtungen bereits jetzt an ihre Grenzen. Was bedeutet das für die Energiewende?
Anreize für erneuerbare Energien
Biologische Vielfalt
Biologische Vielfalt als Produktionsfaktorvon Laura Bieber, Lisa Ebner und Katharina Mensch
Auch Professor Josef Settele, wissenschaftlicher Mitarbeiter des Helmholtz-Zentrums für Umweltforschung, betont die Wichtigkeit der Biodiversität als Produktionsfaktor für die Ökonomie:
Eine ökonomische PerspektiveBiodiversität in der Forstwirtschaft
Grenzen biologischer Vielfalt
Daher kann sich Biodiversität nicht in gleichem Maße positiv auf alle Funktionen eines Ökosystems auswirken. Dies macht es schwierig, hier den optimalen Grad zu ermitteln. Eine Maximierung der Biodiversität in Systemen der Land- und Forstwirtschaftführt also nicht immer zu einem maximalen ökonomischen Wert.
Theoretische Betrachtung bietet neue AnhaltspunkteMittlere Mischung optimal
Wann sich Biodiversität besonders lohntPositiver Einfluss auf Risikostreuung
Zum Vergleich: Der Produktionswert von Mais beträgt ungefähr 1.500 US Dollar pro Jahr und Hektar. Zusätzlich hat der geringere Einsatz von Dünger und Pestiziden positive Auswirkungen auf die Umwelt, da Gewässer und Luft wesentlich weniger mit Stickstoff kontaminiert werden.
Beitrag zum Klimaschutz
Auch laut Dr. Maurice Strunk, Geschäftsführer des Deutschen Netzwerks der Forstunternehmen und Forsttechnik e. V., können weitreichende Bestandsschäden in den Wäldern durch eine Erhöhung der Biodiversität verhindert werden:
Die Landwirtschaft der ZukunftKreative Agroforstsysteme
Professor Thomas Knoke, Leiter der Professur für Waldinventur und nachhaltige Nutzung am Wissenschaftszentrum Weihenstephan, meint, die Landnutzung müsse in Zukunft angepasst werden:
Next GrowthWachstum geht auch andersvon Milad Klopfer
Wirtschaftswachstum wird klassischerweise als das gleichgewichtige Anwachsen von Angebot und Nachfrage auf lange Sicht definiert. Messen lässt sich dieses Wachstum an ökonomischen Werten wie beispielsweise dem Bruttoinlandsprodukt oder dem Bruttonationaleinkommen. Man könnte den Wachstumswert aus rein ökonomischer Sicht immer weiter expandieren, ohne dabei auf natürliche Grenzen zu stoßen. Dass wir jedoch aus ökologischer Sicht durchaus an die Grenzen des Wachstums stoßen, dürfte vielen Menschen spätestens durch die Botschaften der globalen Fridays for Future-Bewegung bewusst geworden sein. Kapitalistische Gesellschaften stehen also vor einem systemischen Widerspruch, denn unbegrenztes wirtschaftliches Wachstum auf einem ökologisch begrenzten Planeten zu schaffen ist schlicht unmöglich.
Krise durch ausbleibendes Wachstum vermeidbar
Studie „Next Growth – Wachstum neu denken“Leitfaden für Unternehmen
Neue Stufe des Kapitalismus‘ erreichen
Einflussmöglichkeiten der Konsumenten eher gering
Ökologische Parallelen
Sind alternative Kapitalismuskonzepte wie dieses also nur eine unerreichbare Utopie? Möglicherweise. Möglicherweise können sie aber mehr sein, wenn die breite Gesellschaft ein solches System einfordert und es schafft, durch andere Mittel – wie z.B. Ressourceneinsparungen – einen der reinen Gewinnsteigerung ebenbürtigen, monetären Mehrwert zu schaffen.
Algen I (Köln)
Algen – Rohstoff der Zukunft?Vom Meer ins Flugzeugvon Dana Jansen
Vielseitig einsetzbar
Hohe Produktionskosten und unausreichende Skalierungseffekte
Projekte, mit denen seit den 1970er Jahren versucht wurde, Algen für Biotreibstoffe zu nutzen, erwiesen sich im industriellen Maßstab als nicht wirtschaftlich. Versprochene Produktionsmengen blieben aus, wettbewerbsfähige Preise waren nicht absehbar. „Besonders in den USA haben Regierung und Investoren mehrere hundert Millionen Dollar in solche Projekte gesteckt“, sagt Siegfried Knecht, Vorstandsvorsitzender beim Branchenverein Aviation Initiative for Renewable Energy (aireg). „Im Bereich der Algen haben sich die meisten Firmen wieder in Richtung Nahrungsmittel, Futtermittel, Kosmetika gewandt“, sagt Knecht. Dort könne mit Algen heute viel Geld verdient werden. Nur wenige arbeiteten noch im Bereich der nachhaltigen Treibstoffe.
Förderung ohne Konzept
Der Münchner Biotechnologe Thomas Brück hält – wäre die Politik nicht so risikoscheu, wie er beklagt – ein Synergie-Konzept für realisierbar: etwa Algenkultivierung kombiniert mit PtXMethoden. Also mit Verfahren zur Erzeugung erneuerbarer Energien, in denen durch elektrischen Strom aus Wasser und CO2 nicht nur flüssiger Kraftstoff generiert wird, sondern auch Gase oder feste synthetische Stoffe, die die Wirtschaft benötigt. Oder Algen kombiniert mit Energiegewinnung durch Sonnenlicht. „Das wäre ein ganzheitlich nachhaltiges Verfahren“, sagt der Wissenschaftler. Die Gesellschaft für chemische Technik und Biotechnologie Dechema beklagt ebenfalls eine fehlende Zusammenarbeit und Kommunikation zwischen Forschung, Industrie, Politik und Wirtschaft. Nur so könne das Potential der Mikroalge wirtschaftlich rentabel ausgeschöpft werden.

Bioökonomie für alle
Bioökonomie für alle
 Wie an der Uni Würzburg gegärtnert wird
Wie an der Uni Würzburg gegärtnert wird
 Natürlicher Kreislauf mit Konzept
Natürlicher Kreislauf mit Konzept
 Lukas Lackner über das Projekt
Lukas Lackner über das Projekt
 Natürlicher Kreislauf
Natürlicher Kreislauf
 Der Garten wächst
Der Garten wächst
 Organisationsstruktur
Organisationsstruktur
 Die Natur unterstützen
Die Natur unterstützen
 Gartenfibel
Gartenfibel
 Lukas Lackner über Nachhaltigkeit
Lukas Lackner über Nachhaltigkeit
 Naturkosmetik – gut für Mensch und Natur?
Naturkosmetik – gut für Mensch und Natur?
 Eine unsichtbare Gefahr
Eine unsichtbare Gefahr
 Vom Ozean auf unsere Teller
Vom Ozean auf unsere Teller
 Schützer der Natur
Schützer der Natur
 Weg von Paraffinen und Co
Weg von Paraffinen und Co
 Jutta Blankenhagen-Wagner über die Bedeutung der Haut
Jutta Blankenhagen-Wagner über die Bedeutung der Haut
 Genauso gut?
Genauso gut?
 Die Legende vom hohen Preis
Die Legende vom hohen Preis
 Naturkosmetik erkennen
Naturkosmetik erkennen
 Gute Aussichten
Gute Aussichten
 Der Marktanteil wächst
Der Marktanteil wächst
 Fleischkonsum mit gutem Gewissen
Fleischkonsum mit gutem Gewissen
 Deutsche essen weniger Fleisch
Deutsche essen weniger Fleisch
 Ernährung der Zukunft
Ernährung der Zukunft
 Nicht überzeugend genug
Nicht überzeugend genug
 Tiere produziert man nicht!
Tiere produziert man nicht!
 Fleisch als Luxusgut?
Fleisch als Luxusgut?
 Ethisches Dilemma
Ethisches Dilemma
 Ungesund und langweilig?
Ungesund und langweilig?
 Transparenz durch Labels
Transparenz durch Labels
 Insekten als Ersatz?
Insekten als Ersatz?
 Produktion und Politik
Produktion und Politik
 Die grüne Zukunft der Digitalisierung
Die grüne Zukunft der Digitalisierung

 Dreckiger Strom
Dreckiger Strom
 Digitale Zukunft
Digitale Zukunft
 Das grüne Rechenzentrum
Das grüne Rechenzentrum
 Politik ist gefordert
Politik ist gefordert
 Elektroschrott
Elektroschrott
 Freund und Feind der Umwelt
Freund und Feind der Umwelt
 Ein gewaltiger Riese
Ein gewaltiger Riese
 Alternative Wohnkonzepte
Alternative Wohnkonzepte
 Leben im Ökodorf
Leben im Ökodorf
 Gemeinschaftsgefühl inbegriffen
Gemeinschaftsgefühl inbegriffen
 Nachhaltige Baustoffe
Nachhaltige Baustoffe
 Grundstück gesucht
Grundstück gesucht
 Wenig Platz, wenig Verbrauch
Wenig Platz, wenig Verbrauch
 Minimalismus ist eine Einstellung
Minimalismus ist eine Einstellung
 Nicht nur ein Trend
Nicht nur ein Trend
 Solidarische Landwirtschaft
Solidarische Landwirtschaft
 Einkaufen mit gutem Gefühl
Einkaufen mit gutem Gefühl
 Das Rundum-Sorglos-Paket
Das Rundum-Sorglos-Paket
 Regionaler Ernteanteil
Regionaler Ernteanteil
 Rundum solidarisch
Rundum solidarisch
 Wertschätzung für die Produkte
Wertschätzung für die Produkte
 Sicherheit für den Landwirt
Sicherheit für den Landwirt
 Solawi: Nische oder Zukunft?
Solawi: Nische oder Zukunft?
 Stefan Köhler über die Grenzen der SoLawi
Stefan Köhler über die Grenzen der SoLawi
 Wieso ein Franke Straßen mit Pflanzenöl bauen will
Wieso ein Franke Straßen mit Pflanzenöl bauen will
 Viel Potenzial für Nachhaltigkeit
Viel Potenzial für Nachhaltigkeit
 Bessere bauliche Eigenschaften durch Rapsöl
Bessere bauliche Eigenschaften durch Rapsöl
 Kleiner Rapsöl-Anteil – große Wirkung
Kleiner Rapsöl-Anteil – große Wirkung
 Nur auf kleineren Straßen einsetzbar
Nur auf kleineren Straßen einsetzbar
 Kritik am Rapsöl im Asphalt
Kritik am Rapsöl im Asphalt
 1 m² Rapsasphalt benötigt 1 m² Rapsfeld
1 m² Rapsasphalt benötigt 1 m² Rapsfeld
 Klaus Geuder: Die Politik ist gefordert
Klaus Geuder: Die Politik ist gefordert
 Elektromobilität: Alternativlose Alternative?
Elektromobilität: Alternativlose Alternative?
 Entwicklung der Elektroautos
Entwicklung der Elektroautos
 Elektromobilität als Zukunftsmodell
Elektromobilität als Zukunftsmodell
 Internationaler Vergleich
Internationaler Vergleich
 Geier über E-Autos
Geier über E-Autos
 Ist schon die Trendwende zum E-Auto in Sicht?
Ist schon die Trendwende zum E-Auto in Sicht?
 Geier über E-Autos
Geier über E-Autos
 Co2-Bilanz besser als bei Benzinern
Co2-Bilanz besser als bei Benzinern
 Geier über Probleme für den Verbraucher
Geier über Probleme für den Verbraucher
 Kritik an Lithium-Ionen-Batterie
Kritik an Lithium-Ionen-Batterie
 Lithium im Kreuzfeuer
Lithium im Kreuzfeuer
 Blaupause bei Alternativen
Blaupause bei Alternativen
 Reinigen ganz ohne Chemie
Reinigen ganz ohne Chemie
 Herkömmliche Putzmittel verunreinigen die Natur
Herkömmliche Putzmittel verunreinigen die Natur
 Nachhaltigkeitssiegel sorgen für Gewissheit
Nachhaltigkeitssiegel sorgen für Gewissheit
 Tenside als zentrale Substanzen
Tenside als zentrale Substanzen
 Regional und 100 Prozent biologisch
Regional und 100 Prozent biologisch
 Nachhaltigkeit im Unternehmen
Nachhaltigkeit im Unternehmen
 Bewusster Umgang mit Reinigungsmitteln
Bewusster Umgang mit Reinigungsmitteln
 Der Wille ist da
Der Wille ist da
 Zwischen Umweltschutz und Kaufrausch
Zwischen Umweltschutz und Kaufrausch
 Nachhaltiger Konsum – ein Absurdum?
Nachhaltiger Konsum – ein Absurdum?
 Grundwald über Nachhaltigen Konsum
Grundwald über Nachhaltigen Konsum
 Die Nachfrage nach grünen Produkten steigt
Die Nachfrage nach grünen Produkten steigt
 Grunwald über den Rebrund-Effekt
Grunwald über den Rebrund-Effekt
 Ein Luxusphänomen
Ein Luxusphänomen
 Der Preis der Nachhaltigkeit
Der Preis der Nachhaltigkeit
 Grunwald über Einfluss von Reichen auf Ökobilanz
Grunwald über Einfluss von Reichen auf Ökobilanz
 Umweltschutz mit kleinem Geldbeutel
Umweltschutz mit kleinem Geldbeutel
 Prinzipielle und realistische Macht der Verbraucher
Prinzipielle und realistische Macht der Verbraucher
 Grunwald über d. Verantwortung d. Politik
Grunwald über d. Verantwortung d. Politik
 Ein Stück Weg fehlt noch
Ein Stück Weg fehlt noch
 Schwammiger Begriff
Schwammiger Begriff

 Im falschen Gewand
Im falschen Gewand

 Nicht alle halten ihr Versprechen
Nicht alle halten ihr Versprechen

 Wertschätzung
Wertschätzung

 Kein Konflikt
Kein Konflikt
 Wie die Bioökonomie den gesellschaftlichen Wandel herausfordert
Wie die Bioökonomie den gesellschaftlichen Wandel herausfordert


 Grenzenlose Verfügbarkeit
Grenzenlose Verfügbarkeit
 O-Ton 1
O-Ton 1
 Weniger Wachstum, mehr Verzicht
Weniger Wachstum, mehr Verzicht

 Weniger Produktion, weniger Arbeit
Weniger Produktion, weniger Arbeit
 Wir werden verzichten müssen
Wir werden verzichten müssen
 Die hemmende Rolle der Märkte
Die hemmende Rolle der Märkte
 Mehr öffentliche Debatte
Mehr öffentliche Debatte
 Außerhalb des Wachstumswahnsinns
Außerhalb des Wachstumswahnsinns
 Der Wunsch nach einer neuen Wirtschaftsordnung
Der Wunsch nach einer neuen Wirtschaftsordnung
 Eine Lösung: die Gemeinwohl-Ökonomie
Eine Lösung: die Gemeinwohl-Ökonomie
 Wachstum muss nicht das oberste Ziel sein
Wachstum muss nicht das oberste Ziel sein
 Welthandel: ethisch korrekt und gemeinwohlorientiert
Welthandel: ethisch korrekt und gemeinwohlorientiert
 Gemeinwohl-Bilanz bereits heute in EU verankert
Gemeinwohl-Bilanz bereits heute in EU verankert
 Wirtschaftshilfen an gesellschaftlichen Nutzen geknüpft
Wirtschaftshilfen an gesellschaftlichen Nutzen geknüpft
 Große Konzerne sollen Verantwortung übernehmen
Große Konzerne sollen Verantwortung übernehmen
 Corona-Pandemie könnte Entwicklungen neuen Schub geben
Corona-Pandemie könnte Entwicklungen neuen Schub geben
 Von der Wegwerf- zur Kreislaufwirtschaft
Von der Wegwerf- zur Kreislaufwirtschaft
 Vom Stall zur Steckdose
Vom Stall zur Steckdose
 Biogas
Biogas
 Christian Endreß über Stromerzeugung
Christian Endreß über Stromerzeugung
 Biogasanlage
Biogasanlage
 Bioenergie in Deutschland
Bioenergie in Deutschland
 Biogas in der Kritik
Biogas in der Kritik
 Dr. Wilhelm Böhmer über Vorteile von Biogas
Dr. Wilhelm Böhmer über Vorteile von Biogas
 Ohne Bauern kein Biogas
Ohne Bauern kein Biogas
 Biogasanlagen nicht mehr rentabel?
Biogasanlagen nicht mehr rentabel?

 Katalysator für die Umwelt
Katalysator für die Umwelt
 Lebensgrundlagen erhalten
Lebensgrundlagen erhalten
 Von der Kakaoschale zur Biokohle
Von der Kakaoschale zur Biokohle
 Felix Ertl über die Verarbeitung von Kakaoresten
Felix Ertl über die Verarbeitung von Kakaoresten

 Felix Ertl über die Eigenschaften von Biokohle
Felix Ertl über die Eigenschaften von Biokohle
 Ein anpassungsfähiger Rohstoff
Ein anpassungsfähiger Rohstoff
 Ein Multitalent
Ein Multitalent
 Pflanzenkohle als Futtermittel
Pflanzenkohle als Futtermittel
 Pflanzenkohle als Wasserspeicher
Pflanzenkohle als Wasserspeicher
 Nachhaltig Bauen mit Holz
Nachhaltig Bauen mit Holz
 Ulf Rössler über Klimaziele
Ulf Rössler über Klimaziele
 Holz als CO2-Speicher
Holz als CO2-Speicher
 Eine ökologische Mustersiedlung
Eine ökologische Mustersiedlung
 In Qualität investieren
In Qualität investieren
 Ulf Rössler über Kosten
Ulf Rössler über Kosten
 Keine knappe Ressource
Keine knappe Ressource
 Grillkohle aus Brauereiresten
Grillkohle aus Brauereiresten
 Fabian Stenzel über Holzkohle
Fabian Stenzel über Holzkohle
 Eine Gefahr für unsere Wälder
Eine Gefahr für unsere Wälder
 Grillkohle aus Produktionsresten
Grillkohle aus Produktionsresten
 Lars Droese über Kokusbriketts
Lars Droese über Kokusbriketts
 Lange Transportwege als Klimafaktor
Lange Transportwege als Klimafaktor
 Fabian Stenzel über Transport
Fabian Stenzel über Transport
 Das Problem mit dem Biertreber
Das Problem mit dem Biertreber
 Hans-Peter Drexler über Biertreber
Hans-Peter Drexler über Biertreber
 Vom Biertreber zur Grillkohle
Vom Biertreber zur Grillkohle
 Die Qualität entscheidet
Die Qualität entscheidet
 Fabian Stenzel über Kundenzufriedenheit
Fabian Stenzel über Kundenzufriedenheit
 Recycling von Windkraftanlagen
Recycling von Windkraftanlagen
 5.000 Anlagen vor dem Aus?
5.000 Anlagen vor dem Aus?
 Lars Schnatbaum-Laumann über Abbau der Windkraftanlagen
Lars Schnatbaum-Laumann über Abbau der Windkraftanlagen
 Problematische Bestandteile
Problematische Bestandteile
 Frank Kreimer über die Entsorgung
Frank Kreimer über die Entsorgung
 80.000 Euro pro Megawatt
80.000 Euro pro Megawatt
 Keine Lösung in Sicht
Keine Lösung in Sicht
 Alexander Hofmann über Kreislaufwirtschaft
Alexander Hofmann über Kreislaufwirtschaft
 Nachhaltige Materialien auf dem OP-Tisch
Nachhaltige Materialien auf dem OP-Tisch
 Medizinprodukte im Wandel
Medizinprodukte im Wandel
 Erforschung von Biopolymeren
Erforschung von Biopolymeren
 Kunststoff-Alternativen sind einsatzbereit
Kunststoff-Alternativen sind einsatzbereit
 In der Praxis keine Priorität
In der Praxis keine Priorität

 Rudloff über Kostenoptimierung
Rudloff über Kostenoptimierung
 Nachhaltigkeit in der Pharmaindustrie
Nachhaltigkeit in der Pharmaindustrie
 Erfahrungswerte sammeln
Erfahrungswerte sammeln
 Erfolg in Sicht
Erfolg in Sicht
 Mit kontinuierlicher Forschung zum Ziel
Mit kontinuierlicher Forschung zum Ziel
 Rudloff fordert die Politik auf
Rudloff fordert die Politik auf
 Fast Fleisch
Fast Fleisch
 Jackfruit als Fleischersatz
Jackfruit als Fleischersatz
 Positive Ökobilanz von Ersatzprodukten
Positive Ökobilanz von Ersatzprodukten
 Fleischverzehr geht zurück
Fleischverzehr geht zurück
 Es geht auch ohne Fleisch
Es geht auch ohne Fleisch
 Die Konsumenten sind gefragt
Die Konsumenten sind gefragt
 Pflanzenproteine ohne den Umweg übers Tier nutzen
Pflanzenproteine ohne den Umweg übers Tier nutzen
 Kraft-Wärme-Kopplung als Alternative
Kraft-Wärme-Kopplung als Alternative
 Fünf Kilowatt für Mehrfamilienhäuser
Fünf Kilowatt für Mehrfamilienhäuser
 Versorgungssicherheit durch Erdgas
Versorgungssicherheit durch Erdgas
 Suche nach neuem Energieträger
Suche nach neuem Energieträger
 Für eine klimaneutrale Zukunft
Für eine klimaneutrale Zukunft
 Regulierbare Anlagen sind notwendig
Regulierbare Anlagen sind notwendig
 Einsatz der KWK
Einsatz der KWK
 Regularien als Hindernisse
Regularien als Hindernisse
 Klimaneutrales Bauen
Klimaneutrales Bauen
 Suche nach Zementersatz
Suche nach Zementersatz
 Herstellung auf Erdölbasis
Herstellung auf Erdölbasis
 Carbonbeton: korrosionsfrei, leicht, tragfähig
Carbonbeton: korrosionsfrei, leicht, tragfähig
 Hohe CO2-Werte, weniger Beton
Hohe CO2-Werte, weniger Beton
 Heimisches Holz nachhaltiger als WPC
Heimisches Holz nachhaltiger als WPC
 Weitere Forschungsfelder
Weitere Forschungsfelder
 Neue Rohre aus Abfällen
Neue Rohre aus Abfällen
 Projekte für die Zukunft
Projekte für die Zukunft
 Nachhaltige Wasserwirtschaft
Nachhaltige Wasserwirtschaft
 Wassermangel auf der Welt
Wassermangel auf der Welt
 Testsysteme zur Abwasseranalyse
Testsysteme zur Abwasseranalyse
 Wasser wird wichtiger
Wasser wird wichtiger
 Vielseitiges Testsystem
Vielseitiges Testsystem
 Schadstoffe im Abwasser nehmen zu
Schadstoffe im Abwasser nehmen zu
 Alternativen für die Zukunft
Alternativen für die Zukunft
 Gut verpackt und voll recycelt
Gut verpackt und voll recycelt
 Steigende Menge an Verpackungsabfällen
Steigende Menge an Verpackungsabfällen
 Recycling laut Gesetz
Recycling laut Gesetz
 Umstellungsprozesse als Herausforderung
Umstellungsprozesse als Herausforderung
 Beurteilung von Recyclingfähigkeit
Beurteilung von Recyclingfähigkeit
 Probleme beim Recycling
Probleme beim Recycling
 Optimierungen auf Software-Basis
Optimierungen auf Software-Basis
 Zusammensetzung der Verpackungen
Zusammensetzung der Verpackungen
 Kunststoff als Wertstoff
Kunststoff als Wertstoff
 Die Kunststoffe der Bioökonomie
Die Kunststoffe der Bioökonomie
 Bio = besser?
Bio = besser?
 Plastik im Alltag
Plastik im Alltag
 Zwei Arten von Biokunststoffen
Zwei Arten von Biokunststoffen
 Bioplastik muss nicht teuer sein
Bioplastik muss nicht teuer sein
 Keine 100 Jahre in unserer Umwelt
Keine 100 Jahre in unserer Umwelt
 Kritik am Biokunststoff
Kritik am Biokunststoff
 Verbindliche Ziele
Verbindliche Ziele
 Forschung für den Markt
Forschung für den Markt
 Umdenken für die Umwelt
Umdenken für die Umwelt
 Einweg trifft auf Upycycling
Einweg trifft auf Upycycling
 Bio-Plastik
Bio-Plastik
 Julia Piechotta von Spoontainable über Bio-Plastik
Julia Piechotta von Spoontainable über Bio-Plastik
 Wirtschaften ohne Abfall
Wirtschaften ohne Abfall
 Reststoffe nutzen
Reststoffe nutzen
 Spoontainable macht´s vor
Spoontainable macht´s vor
 Julia Piechotta über Spoontainable
Julia Piechotta über Spoontainable
 Wunsch nach mehr Politik
Wunsch nach mehr Politik
 Frederik Feuerhahn über Wunsch nach mehr Politik
Frederik Feuerhahn über Wunsch nach mehr Politik
 Kompostierbarer Kunststoff
Kompostierbarer Kunststoff
 Ein Problem für Mensch und Natur
Ein Problem für Mensch und Natur
 Nachhaltige Funktionsschichten
Nachhaltige Funktionsschichten
 Nachhaltige Funktionsschichten II
Nachhaltige Funktionsschichten II
 Doch nicht kompostierbar?
Doch nicht kompostierbar?
 Kreislauf statt Kompost
Kreislauf statt Kompost
 Umweltbewusstsein schaffen
Umweltbewusstsein schaffen
 Biokraftstoffe 2.0
Biokraftstoffe 2.0
 Pflanzenreste statt Futtermittel
Pflanzenreste statt Futtermittel
 95 Prozent weniger CO2
95 Prozent weniger CO2
 Von Miscanthus bis Zuckerrohr
Von Miscanthus bis Zuckerrohr
 Kurze Wege fürs Klima
Kurze Wege fürs Klima
 Ganz ohne fossile Kraftstoffe?
Ganz ohne fossile Kraftstoffe?
 Lokale Strukturen stärken
Lokale Strukturen stärken
 Wie Haßfurt Wasserstoff zum Energiespeicher der Zukunft macht
Wie Haßfurt Wasserstoff zum Energiespeicher der Zukunft macht

 In Haßfurt wird Windstrom in Wasserstoff gespeichert
In Haßfurt wird Windstrom in Wasserstoff gespeichert

 Windkraft spielt große Rolle
Windkraft spielt große Rolle

 Wasserstoff wird in Öl gespeichert
Wasserstoff wird in Öl gespeichert

 Pilze zersetzen Medikamentenrückstände im Abwasser
Pilze zersetzen Medikamentenrückstände im Abwasser

 Ökosysteme leiden
Ökosysteme leiden
 Dr. Anett Werner über Auswirkungen von Medikamentenreste
Dr. Anett Werner über Auswirkungen von Medikamentenreste
Pilzenzyme zersetzen die Rückstände
Pilzenzyme zersetzen die Rückstände


 Ozonierung und Aktivkohle sind praxiserprobte Alternativen
Ozonierung und Aktivkohle sind praxiserprobte Alternativen
 Gib der Natur nicht den Rest
Gib der Natur nicht den Rest

 Mit nachhaltigen Batterien eine klimafreundliche Mobilität schaffen
Mit nachhaltigen Batterien eine klimafreundliche Mobilität schaffen

 Die gesamte Wertschöpfungskette im Blick behalten
Die gesamte Wertschöpfungskette im Blick behalten

 Gebrauchte Batterien können wiederverwendet werden
Gebrauchte Batterien können wiederverwendet werden

 Es gibt Alternativen zu Lithium-Ionen-Batterien
Es gibt Alternativen zu Lithium-Ionen-Batterien

 Batterien sollen klimafreundlicher werden
Batterien sollen klimafreundlicher werden

 Wie Minze herkömmliche Herbizide ergänzen könnte
Wie Minze herkömmliche Herbizide ergänzen könnte
 Konventionelle Herbizide belasten das Ökosystem
Konventionelle Herbizide belasten das Ökosystem
 Nick über Bioherbizide
Nick über Bioherbizide
 Minze als Bioherbizid
Minze als Bioherbizid
 Nick über die Aufbringung
Nick über die Aufbringung
 Bioherbizide stehen noch vor einigen Herausforderungen
Bioherbizide stehen noch vor einigen Herausforderungen
 Landwirte freuen sich über neue Wirkstoffe
Landwirte freuen sich über neue Wirkstoffe
 Nick über Resistenzen
Nick über Resistenzen
 Positive Zukunftsaussichten für den Markt der Bioherbizide
Positive Zukunftsaussichten für den Markt der Bioherbizide
 Mehr Zeit, Geld und Forschung sind nötig
Mehr Zeit, Geld und Forschung sind nötig
 Wie die Kläranlage zum Nährstoffcenter wird
Wie die Kläranlage zum Nährstoffcenter wird
 Menschen, Landwirtschaft, Industrie – sie alle brauchen Wasser
Menschen, Landwirtschaft, Industrie – sie alle brauchen Wasser
 Wasserstress durch cleveres Recycling vermeiden
Wasserstress durch cleveres Recycling vermeiden
 Winkler über Aufbereitung
Winkler über Aufbereitung
 Das Gewächshaus wandert neben die Kläranlage
Das Gewächshaus wandert neben die Kläranlage
 Winkler über Herausforderungen
Winkler über Herausforderungen
 Jetzt: Tomaten statt Salat
Jetzt: Tomaten statt Salat
 Winkler über Standorte
Winkler über Standorte
 Städte als Orte der Lebensmittelerzeugung
Städte als Orte der Lebensmittelerzeugung
 Innovation muss von der Gesellschaft getragen werden
Innovation muss von der Gesellschaft getragen werden
 Der Bioökonomie neue Kleider
Der Bioökonomie neue Kleider
 Sharing Economy in der Textilbranche
Sharing Economy in der Textilbranche
 Textilüberschuss 2
Textilüberschuss 2
 Kleider-Sharing
Kleider-Sharing
 Sharing Economy
Sharing Economy

 Herausforderung: Umdenken
Herausforderung: Umdenken
 Eine utopische Vorstellung
Eine utopische Vorstellung
 Textil-Ökosiegel
Textil-Ökosiegel
 Und jetzt?
Und jetzt?
 Schattenseite von Sharing Economy
Schattenseite von Sharing Economy
 Eine Frage des Geldes
Eine Frage des Geldes
 Wenn aus Müll Mode wird
Wenn aus Müll Mode wird
 Sind Upcycling-Produkte nachhaltig?
Sind Upcycling-Produkte nachhaltig?
 Erfolg durch Transparenz
Erfolg durch Transparenz
 H&M Kampagne
H&M Kampagne
 Konkurrenz im Nischenmarkt
Konkurrenz im Nischenmarkt
 Zukunft in der Fair-Fashion-Branche
Zukunft in der Fair-Fashion-Branche

 Zwischen Vintage und Wegwerfgesellschaft
Zwischen Vintage und Wegwerfgesellschaft
 Jeder Secondhand-Kauf unterstützt Slow Fashion
Jeder Secondhand-Kauf unterstützt Slow Fashion
 Fast fünf Kilo Bekleidungsmüll im Jahr – pro Einwohner
Fast fünf Kilo Bekleidungsmüll im Jahr – pro Einwohner

 Umweltfreundlich und günstig, aber auch mal muffig und von minderer Qualität
Umweltfreundlich und günstig, aber auch mal muffig und von minderer Qualität
 Secondhand-Shopping in der Pandemie
Secondhand-Shopping in der Pandemie
 “Secondhand ist zu einem Spaßtrend geworden“
“Secondhand ist zu einem Spaßtrend geworden“
 Deutlicher Zuwachs auf Secondhand-Plattformen
Deutlicher Zuwachs auf Secondhand-Plattformen
 Kaufverhalten beeinflusst weitere Entwicklung
Kaufverhalten beeinflusst weitere Entwicklung
 Jeans: Wirklich untragbar?
Jeans: Wirklich untragbar?
 Schmutzigstes Kleidungsstück der Welt
Schmutzigstes Kleidungsstück der Welt
 Verminderte Lebenserwartung bei Arbeitern in Denimproduktion
Verminderte Lebenserwartung bei Arbeitern in Denimproduktion
 Verzicht auf Jeans nicht die einzige Lösung
Verzicht auf Jeans nicht die einzige Lösung
 Veränderungswille in Modebranche fragwürdig
Veränderungswille in Modebranche fragwürdig
 Alternativen mit natürlichem Farbstoff
Alternativen mit natürlichem Farbstoff
 Secondhand, lokale Produktion, veganer Denim
Secondhand, lokale Produktion, veganer Denim
 Rohstoffe konkurrieren mit Lebensmittelproduktion
Rohstoffe konkurrieren mit Lebensmittelproduktion
 Armedangels & Co. dürften nur der Anfang sein
Armedangels & Co. dürften nur der Anfang sein
 Die Rohstoffe der Zukunft
Die Rohstoffe der Zukunft
 Rettet die Bienen
Rettet die Bienen
 Überlebenswichtige Bestäuber
Überlebenswichtige Bestäuber

 Wichtig fürs Ökosystem
Wichtig fürs Ökosystem
 Fakten über die Biene
Fakten über die Biene
 Vier schwerwiegende Gründe
Vier schwerwiegende Gründe
 Jeder Einzelne ist gefragt
Jeder Einzelne ist gefragt
 Dr. Peter Biedermann über Campusprojekt
Dr. Peter Biedermann über Campusprojekt
 Bürger wollen Bienen schützen
Bürger wollen Bienen schützen
 Henneberger über Volksbegehren
Henneberger über Volksbegehren
 Die Anpassungsfähigsten überleben
Die Anpassungsfähigsten überleben

 Ältere Landrassen gegen Staunässe und Kälte
Ältere Landrassen gegen Staunässe und Kälte
 Sorten mit hoher Kältetoleranz
Sorten mit hoher Kältetoleranz
 Genschere zugunsten der Hitzetoleranz
Genschere zugunsten der Hitzetoleranz
 Was passiert, wenn ich das Gen auschalte
Was passiert, wenn ich das Gen auschalte
 Methoden noch nicht erlaubt
Methoden noch nicht erlaubt


 Pilze und Pflanzen arbeiten Hand in Hand
Pilze und Pflanzen arbeiten Hand in Hand

 Klimafreundliche Landwirtschaft
Klimafreundliche Landwirtschaft
 Vom Feld in die Atmosphäre
Vom Feld in die Atmosphäre
 Michael Diepolder über Ammoniak
Michael Diepolder über Ammoniak
 Teure Lösung
Teure Lösung
 Peter Seeger über die Weiterentwicklung
Peter Seeger über die Weiterentwicklung
 Wohin mit der Gülle?
Wohin mit der Gülle?
 Klaus Erdle über Güllelager
Klaus Erdle über Güllelager
 Landwirte tun sich zusammen
Landwirte tun sich zusammen
 Von Krise zu Krise
Von Krise zu Krise
 Wirtschaft im Wandel
Wirtschaft im Wandel
 Langfristige Veränderungen
Langfristige Veränderungen
 Sinkende Treibhausgasemissionen
Sinkende Treibhausgasemissionen
 Aus Krisen lernen
Aus Krisen lernen
 Politische Bemühungen
Politische Bemühungen
 Alternative Kulturpflanzen
Alternative Kulturpflanzen
 Michael Grieb über Artensterben
Michael Grieb über Artensterben
 Pioniere der Vielfalt
Pioniere der Vielfalt
 Alternative Alleskönner
Alternative Alleskönner
 Alternative Kulturen als Energielieferanten
Alternative Kulturen als Energielieferanten
 Der richtige Standort
Der richtige Standort
 Neue Pflanzen, neue Schädlinge?
Neue Pflanzen, neue Schädlinge?
 Investition ins Grüne
Investition ins Grüne
 Michael Grieb über Alternative Kulturpflanzen
Michael Grieb über Alternative Kulturpflanzen
 Pflanzen als Klimaretter
Pflanzen als Klimaretter
 Mit Geoengineering zur Klimaneutralität
Mit Geoengineering zur Klimaneutralität
 Natürliche CO2-Verarbeitung
Natürliche CO2-Verarbeitung
 Optimierte CO2-Fixierung – ein Modell
Optimierte CO2-Fixierung – ein Modell
 Dandekar über Nutzung
Dandekar über Nutzung
 Ethische Fragen
Ethische Fragen
 Dandekar über Ethik
Dandekar über Ethik
 Kompromisse in der Forschung
Kompromisse in der Forschung
 Dandekar über die Zukunft
Dandekar über die Zukunft
 Insektensterben in Wiesen und Wäldern
Insektensterben in Wiesen und Wäldern
 Abnehmende Vielfalt
Abnehmende Vielfalt
 Negativer Einfluss durch Agrarwesen
Negativer Einfluss durch Agrarwesen
 Weisser über Aussterben
Weisser über Aussterben
 Landwirtschaftliche Flächennutzung
Landwirtschaftliche Flächennutzung
 Weisser über Insekten
Weisser über Insekten
 Mehr Schutz für Wälder
Mehr Schutz für Wälder
 Einsatz von Pestiziden
Einsatz von Pestiziden
 Freiwillige Umweltprogramme statt gesetzliche Vorgaben?
Freiwillige Umweltprogramme statt gesetzliche Vorgaben?
 Fehlende Erfolge
Fehlende Erfolge
 Weisser über Maßnahmen
Weisser über Maßnahmen
 Nachhaltige Fleischproduktion
Nachhaltige Fleischproduktion
 Fleisch als Alltagsprodukt
Fleisch als Alltagsprodukt
 Zu viel Fleisch pro Kopf
Zu viel Fleisch pro Kopf
 Der große Klimasünder
Der große Klimasünder
 Lösungsansätze
Lösungsansätze
 Regionalität als Markenzeichen
Regionalität als Markenzeichen
 Eller über Tierwohl
Eller über Tierwohl
 Sensibilität für das Produkt
Sensibilität für das Produkt
 Nachhaltigkeit in Großbetrieben
Nachhaltigkeit in Großbetrieben
 Wertschätzung ist die Voraussetzung
Wertschätzung ist die Voraussetzung
 Kreislaufwirtschaft Wald
Kreislaufwirtschaft Wald
 Für einen zukunftsfähigen Wald
Für einen zukunftsfähigen Wald
 Röder über Klimawälder
Röder über Klimawälder
 Der Kreislauf des Holzes
Der Kreislauf des Holzes
 Vielseitige Möglichkeiten
Vielseitige Möglichkeiten
 Klimawandel als Endgegner
Klimawandel als Endgegner
 Schönmüller über Auswirkungen
Schönmüller über Auswirkungen
 Zukunftsfähiger Waldumbau
Zukunftsfähiger Waldumbau
 Wald im Wandel
Wald im Wandel
 Röder über Baumarten
Röder über Baumarten
 Ökologischer Fußabdruck ist klein
Ökologischer Fußabdruck ist klein
 Schönmüller über Nachhaltigkeit
Schönmüller über Nachhaltigkeit
 Ein Palmölverbot ist auch keine Lösung
Ein Palmölverbot ist auch keine Lösung

 O-Ton 3
O-Ton 3


 Ölpalmen decken 40 Prozent des weltweiten Bedarfs
Ölpalmen decken 40 Prozent des weltweiten Bedarfs

 Landrechte bieten soziale und ökologische Vorteile
Landrechte bieten soziale und ökologische Vorteile

 Nachhaltigkeitszertifikate mit ausbaufähigem Potential
Nachhaltigkeitszertifikate mit ausbaufähigem Potential

 Weniger Autofahren, weniger Fleisch essen
Weniger Autofahren, weniger Fleisch essen
 Wie Bakterien den Anbau von Reis klimafreundlicher machen
Wie Bakterien den Anbau von Reis klimafreundlicher machen



 Wie die Methanbildung gestoppt werden kann
Wie die Methanbildung gestoppt werden kann


 Die Menschen haben es in der Hand
Die Menschen haben es in der Hand
 Fragwürdiger Nachhaltigkeitsstandard
Fragwürdiger Nachhaltigkeitsstandard
 Schwache Kontrollmechanismen
Schwache Kontrollmechanismen

 Ein Multitalent für die Medizin
Ein Multitalent für die Medizin

 Spinnenseide schützt vor Schimmel
Spinnenseide schützt vor Schimmel
 Kein Material vereint so viele Eigenschaften
Kein Material vereint so viele Eigenschaften
 Grundlage für Implantate
Grundlage für Implantate
 Natürliche Spinnenseide gewinnen
Natürliche Spinnenseide gewinnen
 Der Zehnkämpfer unter den Seiden
Der Zehnkämpfer unter den Seiden

 Die Seide aus dem Reagenzglas
Die Seide aus dem Reagenzglas

 Ein Implantat umhüllt von Spinnenseide
Ein Implantat umhüllt von Spinnenseide
 Das Billigste ist nicht immer das Beste
Das Billigste ist nicht immer das Beste
 Wo Algen fossile Rohstoffe ablösen können
Wo Algen fossile Rohstoffe ablösen können


 Algenforschung für verschiedene Klimazonen
Algenforschung für verschiedene Klimazonen
 Mit Mikroalgen um die Welt fliegen
Mit Mikroalgen um die Welt fliegen



 Essbare Verpackungen aus Makroalgen
Essbare Verpackungen aus Makroalgen

 Von der Forschung in die Industrie
Von der Forschung in die Industrie

 Hinter den Kulissen
Hinter den Kulissen
 Julius-Maximilians-Universität Würzburg / Wirtschaftsjournalismus
Julius-Maximilians-Universität Würzburg / Wirtschaftsjournalismus
 FHWS
FHWS
 Macromedia
Macromedia
 Und wie hat‘s euch gefallen?
Und wie hat‘s euch gefallen?
 Ronja-Valentina über Bioökonomie und Ethik
Ronja-Valentina über Bioökonomie und Ethik
 Amelie Mangler über das Studieren währender der Corona-Krise
Amelie Mangler über das Studieren währender der Corona-Krise
 David Le über die Arbeit an der Multimedia-Reportage
David Le über die Arbeit an der Multimedia-Reportage
 Anne Köppen berichtet über ihr Thema für das Projekt
Anne Köppen berichtet über ihr Thema für das Projekt
 Romel Aleksanian erzählt über seine Erfahrungen im Projekt
Romel Aleksanian erzählt über seine Erfahrungen im Projekt
 Birte Kock über die Herausforderungen im Projekt
Birte Kock über die Herausforderungen im Projekt
 Maximilian Roos
Maximilian Roos
 Selina Pellner über ihre Erfahrung im Projekt
Selina Pellner über ihre Erfahrung im Projekt
 Renan Schmid über das Projekt Bioökonomie
Renan Schmid über das Projekt Bioökonomie





 Bioökonomie im Klartext
Bioökonomie im Klartext
 "Es ist einfach eine Frucht, die eben diese Struktur von Fleisch hat"
"Es ist einfach eine Frucht, die eben diese Struktur von Fleisch hat"
 "Jetzt müssen natürlich die Arbeiten experimenteller Art kommen."
"Jetzt müssen natürlich die Arbeiten experimenteller Art kommen."
 "Eine ideale Partnerin der erneuerbaren Energien."
"Eine ideale Partnerin der erneuerbaren Energien."
 "Solche Entwicklungen können nur im Team gelingen."
"Solche Entwicklungen können nur im Team gelingen."
 „Es gibt sehr viele Möglichkeiten, um mit klassischem Straßenbau Nachhaltigkeit zu betreiben.“
„Es gibt sehr viele Möglichkeiten, um mit klassischem Straßenbau Nachhaltigkeit zu betreiben.“
 „Es lohnt sich absolut – auch ökonomisch.“
„Es lohnt sich absolut – auch ökonomisch.“
 "Wir müssen anfangen, auch aktiv zu werden"
"Wir müssen anfangen, auch aktiv zu werden"
 "Die größte Hürde ist der fehlende Veränderungswille."
"Die größte Hürde ist der fehlende Veränderungswille."
 "Die Ressource Wasser wird in Zukunft viel, viel wichtiger werden"
"Die Ressource Wasser wird in Zukunft viel, viel wichtiger werden"
 "Wir müssen anwendungsorientiert forschen"
"Wir müssen anwendungsorientiert forschen"
 "Fleisch ist meiner Meinung nach viel zu billig in Deutschland"
"Fleisch ist meiner Meinung nach viel zu billig in Deutschland"
 "Die Umstellungsprozesse sind sehr komplex"
"Die Umstellungsprozesse sind sehr komplex"
 „Wir streben an, diese Verpackung in drei Jahren im Industriemaßstab herstellen zu können“
„Wir streben an, diese Verpackung in drei Jahren im Industriemaßstab herstellen zu können“
 Bioökonomie in Bild und Ton
Bioökonomie in Bild und Ton

 Alternative Stromerzeugung durch Windkraft
Alternative Stromerzeugung durch Windkraft
 Windkraftanlagen werden mehr
Windkraftanlagen werden mehr
 Fernüberwachung
Fernüberwachung
 Strom vom Dach
Strom vom Dach
 Vertikale Windkraftanlage
Vertikale Windkraftanlage
 Selbstversorgung eines Hotels
Selbstversorgung eines Hotels
 Grüner Strom
Grüner Strom
 Nachhaltiges Altpapier
Nachhaltiges Altpapier
 Prof. Schabel über Recyclingpapier
Prof. Schabel über Recyclingpapier
 Die ersten Versuche
Die ersten Versuche
 Lars Helmlinger über den Recyclingprozess
Lars Helmlinger über den Recyclingprozess
 Aktiver Klimaschutz
Aktiver Klimaschutz
 Prof. Schabel über Quotensteigerung
Prof. Schabel über Quotensteigerung
 Einsparpotenzial
Einsparpotenzial
 Automobilindustrie unter Druck
Automobilindustrie unter Druck
 Andreas Jenne über Nachhaltigkeit
Andreas Jenne über Nachhaltigkeit
 Dekarbonisierung
Dekarbonisierung
 Wasserstoff-Brennstoffzelle
Wasserstoff-Brennstoffzelle
 Kreislaufwirtschaft
Kreislaufwirtschaft
 Anreas Jenne über die Kreislaufwirtschaft
Anreas Jenne über die Kreislaufwirtschaft
 Erfolg durch Einsparung
Erfolg durch Einsparung
 Regionale Logistik
Regionale Logistik
 Claudia Schreiber über regionale Logistik
Claudia Schreiber über regionale Logistik
 Regionale Produkte
Regionale Produkte
 Nutzung vorhandener Ressourcen
Nutzung vorhandener Ressourcen
 Anja Sylvester über Bus als Alternative
Anja Sylvester über Bus als Alternative
 Aufwertung des ÖPNV
Aufwertung des ÖPNV
 Eine App für alle
Eine App für alle
 Anja Sylvester über Eigenreflexion
Anja Sylvester über Eigenreflexion
 Öffentliche Beschaffung
Öffentliche Beschaffung
 Das richtige Mittel
Das richtige Mittel
 Biobasierte Produkte
Biobasierte Produkte
 Ronald Bogaschewsky über die Frage des Preises
Ronald Bogaschewsky über die Frage des Preises
 Auswirkungen der Lebenszykluskosten
Auswirkungen der Lebenszykluskosten
 Bogaschewsky über Lebenszykluskosten
Bogaschewsky über Lebenszykluskosten
 Bogaschewsky über die Ignoranz der Politik
Bogaschewsky über die Ignoranz der Politik
 Öffentlicher Sektor als Vorbildfunktion
Öffentlicher Sektor als Vorbildfunktion
 Bodenschutz als Gemeinschaftsaufgabe
Bodenschutz als Gemeinschaftsaufgabe
 Bedeutung der Böden
Bedeutung der Böden
 Florian Ebertseder über Bodenneubildung
Florian Ebertseder über Bodenneubildung
 Ursachen mit weitreichenden Folgen
Ursachen mit weitreichenden Folgen
 Bodenversiegelung
Bodenversiegelung
 Karl Stahr über die zunehmende Bewirtschaftung
Karl Stahr über die zunehmende Bewirtschaftung
 Technische Maßnahmen
Technische Maßnahmen
 Bodenschutz im Alltag
Bodenschutz im Alltag
 Integrierter Pflanzenschutz
Integrierter Pflanzenschutz
 Der integrierte Ansatz
Der integrierte Ansatz
 Enno Bahrs über Pyramide
Enno Bahrs über Pyramide
 Kritik an chemischen Mitteln
Kritik an chemischen Mitteln
 Brigitte Kranz über Chemie vs. Biologie
Brigitte Kranz über Chemie vs. Biologie
 Biologische Maßnahmen
Biologische Maßnahmen
 Enno Bahrs über Deutschland Stand
Enno Bahrs über Deutschland Stand
 Die Pyramide im Fokus
Die Pyramide im Fokus
 Enno Bahrs über Digitalisierung
Enno Bahrs über Digitalisierung
 Gezielter Einsatz der Chemie
Gezielter Einsatz der Chemie
 Brigitte Kranz über Verbraucher
Brigitte Kranz über Verbraucher
 Enno Bahrs über Verbraucher
Enno Bahrs über Verbraucher
 Energieholz
Energieholz
 Wärme und Stromerzeugung
Wärme und Stromerzeugung
 Kostenvergleich
Kostenvergleich
 Christian Letalik über Nutzungspfade
Christian Letalik über Nutzungspfade
 Schnelles Baumwachstum
Schnelles Baumwachstum
 Energieeffizienz
Energieeffizienz
 Christian Letalik über den Nutzen der Bäume
Christian Letalik über den Nutzen der Bäume
 Kurze Transportwege
Kurze Transportwege
 Emissionen
Emissionen
 Patrick Huth über Beitragsleistungen
Patrick Huth über Beitragsleistungen
 Anreize für erneuerbare Energien
Anreize für erneuerbare Energien
 Biologische Vielfalt als Produktionsfaktor
Biologische Vielfalt als Produktionsfaktor
 Josef Settele über Ökonomie
Josef Settele über Ökonomie
 Biodiversität in der Forstwirtschaft
Biodiversität in der Forstwirtschaft
 Grenzen biologischer Vielfalt
Grenzen biologischer Vielfalt
 Mittlere Mischung optimal
Mittlere Mischung optimal
 Positiver Einfluss auf Risikostreuung
Positiver Einfluss auf Risikostreuung
 Beitrag zum Klimaschutz
Beitrag zum Klimaschutz
 Maurice Strunk über Klimawandel
Maurice Strunk über Klimawandel
 Kreative Agroforstsysteme
Kreative Agroforstsysteme
 Thomas Knoke über Zukunft der Biodiversität
Thomas Knoke über Zukunft der Biodiversität
 Wachstum geht auch anders
Wachstum geht auch anders
 Leitfaden für Unternehmen
Leitfaden für Unternehmen
 Einflussmöglichkeiten der Konsumenten eher gering
Einflussmöglichkeiten der Konsumenten eher gering
 Ökologische Parallelen
Ökologische Parallelen
 Vielseitig einsetzbar
Vielseitig einsetzbar
 Hohe Produktionskosten und unausreichende Skalierungseffekte
Hohe Produktionskosten und unausreichende Skalierungseffekte
 Hohe Produktionskosten und unausreichende Skalierungseffekte
Hohe Produktionskosten und unausreichende Skalierungseffekte
 Förderung ohne Konzept
Förderung ohne Konzept
 Durch Zusammenarbeit zum Ziel
Durch Zusammenarbeit zum Ziel
 Nachhaltigkeit durch Kreislaufdenken
Nachhaltigkeit durch Kreislaufdenken
 Kochen und backen mit der Trend-Zuta
Kochen und backen mit der Trend-Zuta